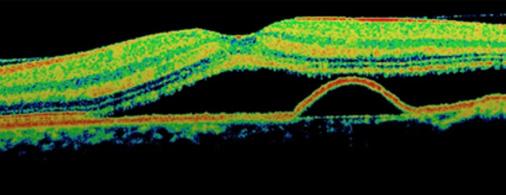

ARTICLE 1
Rôle des biosimilaires dans l’avenir de la gestion des maladies rétiniennes
ARTICLE 2
Les médicaments biologiques biosimilaires : traitement de l’uvéite

ARTICLE 3
Les nouveaux produits ophtalmiques topiques pour le segment antérieur
VOLUME 45 | NUMÉRO 3 MAI | JUIN 2023
Une autre facette de notre
Nous imprimons notre revue sur du papier certifié FSC.
engagement environnemental.
ÉDITEUR
Association des Optométristes du Québec
1255, boul. Robert-Bourassa, bureau 1400
Montréal, Québec H3B 3X1
COURRIEL | aoq@aoqnet.qc.ca
PRÉSIDENT
Docteur Guillaume Fortin, optométriste
ABONNEMENT ANNUEL
CANADA | 85,45 $
ÉTRANGER | 125,00 $ (taxes incluses)
COORDONNATEUR SCIENTIFIQUE
Docteur Jean-Pierre Lagacé, optométriste, M.Sc.
COURRIEL | jpierre.lagace@aoqnet.qc.ca
COORDONNATRICE DE LA PRODUCTION
Josée Lusignan | 514 288-6272
COURRIEL | josee.lusignan@aoqnet.qc.ca
PUBLICITÉ
Normand Lalonde
CPS Média Inc.
TÉLÉPHONE | 866 227-8414, poste 310
COURRIEL | nlalonde@cpsmedia.ca
CONCEPTION GRAPHIQUE
BooDesign.ca
ARTICLES DEMANDÉS
TÉLÉCOPIEUR | 514 288-7071
COURRIEL | aoq@aoqnet.qc.ca
SITE INTERNET | www.aoqnet.qc.ca
Bibliothèque nationale du Québec 2e trimestre 1979
Reproduction interdite sans autorisation.
LE PRÉSENT NUMÉRO A ÉTÉ TIRÉ À
3 050 exemplaires
ISSN-0708-3173
Numéro de convention postale : 41129579
DÉFINITION DE L’OPTOMÉTRISTE
L’Optométriste ouvre ses pages à toute collaboration pouvant intéresser la profession optométrique sur le plan professionnel, social, économique et syndical. Le Comité de rédaction invite tous les optométristes à soumettre le rapport d’un cas ou un article susceptible d’intéresser leurs confrères. Tous les écrits soumis deviennent la propriété de la revue l’Optométriste. Le Comité de rédaction se réserve le droit de publier un article dans le numéro qui lui convient. Aucune indemnité ne sera versée à l’auteur pour l’utilisation d’un article. Les textes ainsi que les publi-reportages publiés dans cette revue n’engagent que leur auteur.
VEUILLEZ ENVOYER VOS ARTICLES À L’ÉDITEUR
Revue l’Optométriste
1255, boul. Robert-Bourassa, bureau 1400
Montréal, Québec H3B 3X1
TÉLÉPHONE | 514 288-6272
SOMMAIRE
« L’optométriste (O.D.) est un professionnel de la santé de première ligne, détenteur d’un doctorat universitaire de 5 ans, qui agit comme porte d’entrée des services oculo-visuels. Il évalue la vision, la binocularité et la santé oculaire. Son rôle est de procéder à l’examen des yeux et de la vision. Il peut également prescrire et administrer des médicaments aux fins de l’examen de la vision et du traitement de certaines pathologies oculaires. Il prescrit les lentilles ophtalmiques nécessaires, qu’elles soient cornéennes ou pour lunettes, et des traitements de rééducation visuelle. L’optométriste prodigue des conseils afin de prévenir les troubles visuels et de promouvoir la saine santé oculo-visuelle de ses patients et, au besoin, il peut diriger le patient vers d’autres professionnels de la santé. »
05 ÉDITORIAL
Docteur Guillaume Fortin, optométriste, Président 08 ARTICLE 1
Rôle
Docteur Jean-Pierre Lagacé, optométriste, M.Sc.
18 ARTICLE 2
Les médicaments biologiques biosimilaires : traitement de l’uvéite

Docteur Jean-Pierre Lagacé, optométriste, M.Sc. 26 ARTICLE 3
Les nouveaux
Docteur
36 CHRONIQUE LES CONSEILS D'AFFAIRES MNP
Des conseils pour retenir vos employés
40 CHRONIQUE JURIDIQUE
Êtes-vous un consommateur aguerri ? Vrai ou Faux


44 CHRONIQUE ACTUALITÉS
55 CHRONIQUE FMOQ
CELIAPP, un nouveau coup de pouce pour les premiers acheteurs
58 CHRONIQUE LUSSIER
58 L’assurance frais de bureau
60 Assurance automobile : la fièvre du printemps
62 LES PETITES ANNONCES CLASSÉES DE L'AOQ
26
Éloigné de quoi au juste ?
des biosimilaires dans l’avenir de la gestion des maladies rétiniennes
produits ophtalmiques topiques pour le segment antérieur
8 18
Jean-Pierre Lagacé, optométriste, M.Sc.

L’institution financière des optométristes Une offre pensée et développée pour vos besoins personnels et professionnels. Faites comme plusieurs optométristes et profitez de l’offre Distinction. 1 844 778-1795 poste 30 desjardins.com/optometriste
Éloigné de quoi au juste ?
Dans les derniers mois, quelques optométristes ont manifesté leur inquiétude dans les médias concernant la difficulté de recrutement et de relève dans certaines régions du Québec, et la difficulté pour les patients à obtenir un rendez-vous avec un optométriste. Étant moi-même optométriste de ce qu’on qualifie parfois de région « éloignée », il va sans dire que le sujet m’interpelle et qu’il est très à propos de parler de la situation.
La première chose que l’Association veut clarifier est qu’il n’y a pas de pénurie d’optométristes au Québec. Le ratio optométriste est environ 1 par 5 600 habitants alors que le ratio canadien est environ 1 par 6 300. Évidemment ces ratios ne disent pas tout, ils ne tiennent pas compte des réalités du Québec en ce qui a trait au nombre moyen de jours travaillés, de vacances ou de congés de maternité. Cela dit, ce ratio permet d’obtenir des services rapides et adéquats pour une forte majorité de patients Québécois. Comme le démontrent nos sondages, il n’y a pas d’attente importante dans la plupart des grandes villes du Québec pour les rendez-vous de routine et encore moins pour les rendez-vous d’urgence.

Nul besoin d’être actuaire pour comprendre par ailleurs que dans une ville de 16 800 habitants en appliquant le même ratio de 1/5 600, si un des trois optométristes de la ville part à la retraite ou quitte pour un plus grand centre sans avoir de relève… le ratio tombe à 1/8 400. Les deux optométristes restants ne suffiront pas et risquent une surcharge de travail qui les épuisera tôt ou tard. Si ces deux optométristes finissent eux aussi par prendre leur retraite sans relève… enfin, nous voyons tous le problème !
Cette situation n’est pas unique à l’optométrie. Les communautés à faible densité de population sont confrontées à cette réalité dans tous les services de santé ou autres. Cependant, nous avons toujours vanté notre répartition exemplaire sur le territoire québécois.
Nous nous devons tous fournir des efforts pour maintenir cette force qui protège à la fois nos patients et notre profession. Sans qu’il y ait de pénurie réelle, les difficultés de recrutement sectorielles sont reconnues par l’AOQ, l’OOQ ainsi que l’École d’optométrie. C’est entre autres pourquoi un nouveau processus d’admission a été mis en place et pourquoi plus d’étudiants seront admis dans les prochaines années. Même s’il y a déjà un certain effort pour les stages de deux semaines de gestion, il serait souhaitable que l’École offre plus de possibilités d’exposition des étudiants aux milieux où il y a des problématiques de recrutement et de relève. C’est aussi parce que nous reconnaissons ces difficultés sectorielles que nous en parlons afin d’allumer une flamme chez certains !

5 ÉDITORIAL PAR LE DOCTEUR GUILLAUME FORTIN OPTOMÉTRISTE, PRÉSIDENT OPTOMÉTRISTE | MAI | JUIN 2023
Il y a bien sûr plusieurs facteurs hors de notre contrôle. L’attrait des grandes villes existe bel et bien. Néanmoins, la qualité et le coût de la vie en région exercent aussi un attrait indéniable. Lors de la pandémie, une région métropolitaine de recensement comme celle de la ville de Saguenay, 6e en nombre d’habitants au Québec, a connu une expansion démographique inédite en trente ans… Plusieurs personnes se sont questionnées sur leur milieu de vie et ce qu’ils recherchent comme qualité de vie. Ce phénomène se pointe-t-il aussi chez les optométristes ? Peut-être… certains indicateurs montrent que oui. Vous êtes nombreux à travailler une semaine régulièrement aux quatre coins du Québec. Les optométristes locaux que vous aidez sont reconnaissants. Les cliniques et l’entièreté des communautés sont reconnaissantes ! Mais au fond, comme dans le film « La grande séduction », ces communautés ne souhaitent pas ce genre de relation à long terme. La vérité est qu’elles espèrent plutôt vous voir un jour tomber en amour avec l’endroit et vous y installer. C’est ce que recherchent réellement ces régions dites « éloignées » soit des professionnels qui s’enracinent. À l’instar des jeunes des régions qui tombent en amour avec Montréal ou Québec, l’inverse est tout à fait possible.
Ainsi, plus nous exposerons les jeunes optométristes à l’exercice de la profession en région, plus l’amour pour celle-ci risque de se développer ! Alors continuez de demander à l’École si des stages en régions sont possibles et continuez de venir faire votre petit tour de temps en temps !
Je prêche un peu pour ma paroisse mais je le fais aussi pour la profession car la répartition de nos membres sur le territoire fait partie de notre force. Le Québec regorge de fabuleux endroits offrant également des opportunités de carrière et d’affaires exceptionnelles ! Intéressez-vous à elles et qui sait, vous verrez peut-être qu’en fait, ce que les gens qualifient « d’éloigné » est souvent très proche de ce que vous recherchez ! Aussi, peu importe où nous nous enracinons, nous sommes toujours éloignés de quelque chose… Les seules choses dont les optométristes ne doivent pas s’éloigner, ce sont des Québécois et de leurs milieux de vie.

 Docteur Guillaume Fortin, optométriste Président
Docteur Guillaume Fortin, optométriste Président
1 888-SOS-OPTO
6 OPTOMÉTRISTE | MAI | JUIN 2023 POUR NOUS JOINDRE
514 288-6272
QUESTIONS ?
FAIRE UN CHANGEMENT D'ADRESSE Rendez-vous sur le portail de l'AOQ
DES
écrivez-nous à aoq@aoqnet.qc.ca
| aoqnet.qc.ca
Changez ce qui est possible pour vos patients presbytes
Lentilles cornéennes MyDayMD multifocal


Technologie multifocale révolutionnaire
Les lentilles multifocales à usage unique MyDayMD dotées du système progressif binoculaireMC multifocal innovant à trois additions de CooperVisionMD, permettent à vos patients de voir comme avant1


Ajustement facile et réussi1
Taux de réussite de l’ajustement de 98 % avec deux paires ou moins2
Vision claire et optimale qu’importe la distance1
Pour les presbytes à un stade précoce et avancé1
Conçues pour assurer le confort du porteur


Dotées de la technologie Aquaform pour une mouillabilité naturelle et un confort incroyable qui dure toute la journée
Donnez à vos patients presbytes les moyens de récupérer une vision claire à toutes les distances grâce aux lentilles multifocales à usage unique MyDayMD.
unique MyDayMD daily disposable multifocal; n = 104 porteurs habituels de lentilles multifocales.
2. Données internes CVI, 2020. Étude prospective, à double insu, bilatérale, d’une durée d’une semaine d’essai au Royaume-Uni portant sur les lentilles multifocales à usage unique MyDayMD daily disposable multifocal; n = 104 porteurs habituels de lentilles cornéennes multifocales. Données internes CVI, 2021. Étude prospective sur cinq sites aux États-Unis, avec sujets masqués, randomisée, bilatérale, d’une durée de deux semaines d’essai portant sur les lentilles multifocales à usage unique MyDayMD daily disposable multifocal; n = 58 porteurs habituels de lentilles cornéennes multifocales.
©2023 CooperVision, Inc., CooperVision et MyDay sont des marques déposées de The Cooper Companies, Inc., ses filiales ou sociétés affiliées.





7 OPTOMÉTRISTE | MAI | JUIN 2023
CVI,
Étude
bilatérale, d’une durée d’une semaine d’essai portant sur les lentilles multifocales à usage
1. Données internes
2020.
prospective, à double insu,
UV blocking
Titre Rôle des biosimilaires dans l’avenir de la gestion des maladies rétiniennes
Les biosimilaires sont une option prometteuse qui pourrait élargir l’accès aux thérapies rétiniennes en réduisant les coûts et en améliorant par conséquent les résultats des traitements dans le monde réel1
En juillet 2022, le premier biosimilaire approuvé par la FDA pour une indication ophtalmique est arrivé sur le marché. Byooviz (ranibizumab-nuna, Biogen/ Samsung Bioepis) est un biosimilaire référençant Lucentis (ranibizumab, Genentech), indiqué dans le traitement de la dégénérescence maculaire liée à l’âge néovasculaire, de l’œdème maculaire consécutif à une occlusion de la veine rétinienne (OVR) et de la néovascularisation choroïdienne myopique1,3
En août, la FDA a approuvé Cimerli (ranibizumab-eqrn, Coherus BioSciences) en tant que biosimilaire interchangeable du Lucentis, indiqué pour la DMLA néovasculaire, l’œdème maculaire consécutif à une OVR, l’œdème maculaire diabétique, la rétinopathie diabétique et la néovascularisation choroïdienne myopique. Il devrait être disponible dans le commerce en doses de 0,3 mg et 0,5 mg en octobre.
Dans d’autres parties du monde, l’introduction des biosimilaires est également considérée comme une occasion de dépasser le modèle de soins existant et d’élargir l’accès des patients4,5
Aucun biosimilaire d’anti-VEGF n’est actuellement disponible en Inde, mais ils feront partie des changements qu’on prévoit dans la prise en charge des patients au cours des prochaines années.
Après le signal d’alarme soulevé par le brolucizumab (Novartis), les ophtalmologistes sont particulièrement attentifs aux réactions immunogènes. L’immunogénicité, qui conduit le plus souvent à la génération d’anticorps anti-médicaments, doit toujours être testée et surveillée, mais elle est cependant inhérente aux traitements biologiques. Tous les produits biopharmaceutiques, y compris les biosimilaires, ont le potentiel de susciter une réaction immunogène.


8 OPTOMÉTRISTE | MAI | JUIN 2023
ARTICLE 1 PAR LE DOCTEUR JEAN-PIERRE LAGACÉ OPTOMÉTRISTE, M.Sc
Jusqu’à présent, aucune preuve d’immunogénicité n’a été observée dans les études, mais les médecins doivent rester vigilants, et les données de post-commercialisation sur un plus grand nombre de patients devraient fournir davantage d’informations.
Le processus d’approbation
Les biosimilaires sont des produits biologiques qui ne sont pas identiques, mais dont la structure et la fonction sont très similaires à celles d’un produit biologique déjà approuvé. Grâce à une approche stricte, par étapes, de la totalité des preuves, ils sont soumis à une évaluation de comparabilité tête-à-tête, suivie d’études in vitro et in vivo, pour prouver que la pureté, les propriétés physicochimiques, l’efficacité thérapeutique et la sécurité correspondent aux attributs du produit de référence.
« D’un point de vue préclinique, les exigences pour l’approbation d’un biosimilaire sont encore plus élevées et plus strictes qu’elles ne l’étaient pour le produit biologique d’origine. Le programme d’essais cliniques est proportionnellement réduit, mais à condition que la comparabilité soit rigoureusement démontrée au cours des étapes non cliniques », a déclaré M. Fornasari.
Des essais contrôlés randomisés sont ensuite réalisés, avec les critères classiques d’acuité visuelle et d’OCT. Comme une grande similitude a été prouvée au préalable, les autorités réglementaires autorisent un nombre réduit de patients et un suivi plus court, généralement 400 à 500 patients sur 12 mois en ophtalmologie.
L’immunogénicité est testée à ce stade et pendant la surveillance post-commercialisation. Les réactions peuvent ne pas être aussi fréquentes pendant la durée limitée des essais et c’est pourquoi les biosimilaires sont complétés par de solides études de surveillance de pharmacovigilance.
Tester les résultats et la sécurité dans le monde réel
Étant donné la taille réduite des échantillons et la durée plus courte des essais d’enregistrement, les études de phase 4 deviennent essentielles pour identifier les problèmes potentiels d’efficacité ou de sécurité.
Les études elles-mêmes ont jusqu’à présent été sous-dimensionnées et inadéquates pour démontrer scientifiquement quelque chose de nouveau ou d’intéressant, ni en ce qui a trait à la sécurité, ni en ce qui concerne l’efficacité et la diminution de la charge du traitement.
Extrapolation
L’extrapolation est le processus par lequel les indications approuvées pour le produit biologique de référence sont également accordées au biosimilaire. La biosimilarité de Byooviz a été évaluée pour la DMLA néovasculaire et, par extrapolation, sans essais spécifiques, l’approbation a également été donnée pour l’œdème maculaire après OVR et la néovascularisation choroïdienne myopique.
La FDA et l’Agence européenne des médicaments déclarent toutes deux que si la totalité des preuves et la justification scientifique soutiennent la biosimilarité pour l’une des indications du produit de référence, ces données peuvent justifier l’approbation pour d’autres indications détenues par le produit de référence.
Mme Fornasari a rassuré les ophtalmologistes, qui expriment souvent leur inquiétude face à cette pratique, en leur expliquant que l’extrapolation a une justification scientifique.
L’extrapolation élimine la nécessité de mener des études cliniques en double, ce qui réduit les coûts de développement et, en fin de compte, le coût final du médicament. L’expérience du Razumab en Inde
Le brevet du Lucentis a expiré en 2020 aux États-Unis et expire cette année en Europe, au Japon et en Chine. Le brevet d’Eylea (aflibercept, Regeneron) pourrait expirer en 2023 aux États-Unis, en 2025 en Europe et cette année au Japon et en Chine. Il existe actuellement 10 biosimilaires du ranibizumab, dont deux ont été approuvés en Inde, et Byooviz a été approuvé par la FDA et l’EMA. Les autres sont à des stades avancés d’essais cliniques. En outre, cinq biosimilaires de l’aflibercept sont à l’étude, et tous ont atteint la phase 3 des études2,4
Le Razumab (Intas Pharmaceuticals) a été approuvé par le contrôleur général des médicaments de l’Inde (DCGI) en 2015, et depuis, il est utilisé en clinique dans les hôpitaux et les cabinets privés. Considérant qu’il est deux fois moins cher que le Lucentis et trois fois moins cher que l’Eylea, les patients qui n’ont pas d’assurance et doivent payer de leur poche le préfèrent.
Les indications du Razumab sont la DMLA, l’œdème maculaire diabétique, l’œdème maculaire secondaire à l’OVCR et la membrane néovasculaire choroïdienne chez les patients atteints de myopie pathologique.
Avec les premiers lots de Razumab, une endophtalmie stérile est survenue chez 10 % des patients, ce qui a suscité des inquiétudes quant à la sécurité, et on a cessé la fabrication.
La cause a été identifiée comme étant des niveaux d’endotoxine plus élevés dans le tampon utilisé dans le processus de fabrication. Un tampon différent a été utilisé et de nouveaux lots ont été progressivement mis en circulation avec une surveillance attentive. Depuis lors, aucune réaction grave n’a été observée et le profil de sécurité est maintenant similaire à celui du ranibizumab et d’autres anti-VEGF.
Les études ultérieures menées dans le monde réel ont montré que les résultats étaient bons et que l’efficacité et la sécurité étaient équivalentes à celles du ranibizumab.
Au-delà de l’Avastin
Actuellement, l’Avastin (bevacizumab, Genentech) est l’anti-VEGF le plus couramment utilisé en Inde, car il est quatre fois moins cher que le Razumab. Comme partout ailleurs, il n’est pas approuvé par le DCGI pour un usage ophtalmique et est utilisé hors indication5,6
9 OPTOMÉTRISTE | MAI | JUIN 2023
Il y a également eu quelques rapports d’endophtalmie associée à l’utilisation d’Avastin en Inde, ce qui a mis en lumière les problèmes potentiels de contamination microbienne lorsque les seringues individuelles sont préparées à partir du grand flacon.
Les pharmacies de préparation sont assez rares en Inde et encore plus dans d’autres pays en développement, et c’est une des raisons pour lesquelles les médicaments biosimilaires approuvés sont nécessaires et représentent une occasion de marché massive.
D’autres biosimilaires pourraient être introduits, comme les biosimilaires d’Eylea, mais le coût devrait être plus élevé, car le prix du médicament de référence est supérieur.
Sensibiliser les cliniciens pour éviter l’effet nocebo
Byooviz vient d’être introduit sur le marché américain et,selon Singh, il est trop tôt pour dire s’il va gagner la communauté de la rétine et à quelle vitesse.
L’expérience acquise dans d’autres domaines thérapeutiques dans lesquels les biosimilaires sont disponibles depuis des années a montré que les médecins doivent acquérir une bonne compréhension du processus d’approbation et, par conséquent, gagner en confiance dans les biosimilaires. Ce n’est qu’à cette condition qu’ils pourront communiquer efficacement avec les patients et éviter l’effet nocebo.
L’effet nocebo (du latin : « je nuirai ») est un terme introduit en 1961 par Walter Kennedy. L’effet psychologique ou physiologique lié à la prise d’une substance inerte n’est pas toujours bénéfique, sous la forme d’un effet placebo, il peut aussi être dommageable pour l’individu, et on parle alors d’effet nocebo.
Cet effet nocebo peut prendre la forme d’effets secondaires. Le patient, croyant qu’il prend un médicament, est susceptible de recréer, par suggestion, les effets indésirables dont il a pu entendre parler auprès de ses amis ou dans les médias, ou qu’il a simplement lus sur la notice7
Une approche graduelle et inclusive
Une autre préoccupation des ophtalmologistes est que l’adoption des biosimilaires pourrait être dictée par les compagnies d’assurance et les politiques hospitalières plutôt que par le choix du clinicien.
Une introduction progressive dans la pratique clinique devrait aider les cliniciens à développer une confiance bien fondée dans les biosimilaires et à prévenir l’effet nocebo chez leurs patients, selon Fornasari.
À l’inverse, si les autorités sanitaires ou hospitalières prennent les devants et imposent l’adoption des biosimilaires, sans période de transition et sans impliquer les cliniciens dans le choix, l’acceptation pourrait être irrémédiablement compromise.
Concurrencer le bevacizumab
Alors que dans les pays en développement, les biosimilaires peuvent constituer une alternative potentiellement rentable au bevacizumab, sans risque de contamination en raison du manque de pharmacies de préparation, il peut être plus difficile de lui faire concurrence dans les pays développés, car le bevacizumab est bon marché et disponible sans risque substantiel, a déclaré Loewenstein.
Singh a également déclaré que le bevacizumab est un concurrent et que les biosimilaires ne seront jamais aussi bon marché.
En Israël, pour réduire la charge financière sur les soins de santé, l’Avastin est obligatoirement administré comme traitement de première intention, et Loewenstein, comme beaucoup de ses collègues, utiliserait volontiers un biosimilaire à la place.
Toutefois, le prix reste un élément important dans cette décision.
Efficacité et sécurité d’un produit biosimilaire de ranibizumab proposé par rapport à un produit de référence de ranibizumab pour les patients atteints de dégénérescence maculaire liée à l’âge néovasculaire : un essai clinique randomisé
Importance : La dégénérescence maculaire liée à l’âge néovasculaire est la principale cause de cécité chez les personnes de 50 ans et plus. La disponibilité d’un produit biosimilaire du ranibizumab (SB11) pourrait faciliter l’accès à un produit de remplacement efficace pour ce traitement8
Objectif : Démontrer l’équivalence d’efficacité, la sécurité similaire et l’immunogénicité similaire du SB11 par rapport au ranibizumab de référence.
Conception, contexte et participants : Cette étude d’équivalence de phase 3 randomisée, à double insu et en groupes parallèles, a été menée dans 75 centres de 9 pays du 14 mars 2018 au 9 décembre 2019, auprès de 705 participants âgés de 50 ans et plus atteints de dégénérescence maculaire liée à l’âge néovasculaire avec des lésions de néovascularisation choroïdienne sous-fovéaleactive. L’analyse a été réalisée en intention de traiter.
Interventions : Injection intravitréenne de SB11 ou de ranibizumab, 0,5 mg, toutes les 4 semaines jusqu’à la semaine 48.
Principaux résultats et mesures : Analyse intermédiaire définie à l’avance après que tous les participants aient terminé l’évaluation à la semaine 24 des points d’aboutissement primaires d’efficacité à la semaine 8 pour ce qui est du changement par rapport à la ligne de base de la meilleure acuité visuelle corrigée (MAVC), et à la semaine 4 pour ce qui est de l’épaisseur du sous-champ central (CST), avec des marges d’équivalence prédéfinies pour les différences de traitement ajustées de -3 lettres à 3 lettres pour la MAVC et de -36 μm à 36 μm pour le CST.
Résultats : Les caractéristiques de base et de la maladie parmi les 705 participants randomisés (403 femmes [57,2 %]; âge moyen [ET], 74,1 [8,5] ans) étaient comparables entre les groupes de traitement (SB11, 351; ranibizumab, 354). Les changements de la moyenne des moindres carrés (SE) de la MAVC par rapport à la ligne de base à la semaine 8 étaient de 6,2 (0,5) lettres dans le groupe SB11 contre 7,0 (0,5) lettres dans le groupe ranibizumab, avec une différence de traitement ajustée de -0,8 lettre (IC à 90 %, -1,8 à 0,2 lettre).
10 OPTOMÉTRISTE | MAI | JUIN 2023
Les changements de la moyenne des moindres carrés (SE) du CST par rapport à la ligne de base à la semaine 4 étaient de -108 (5) μm dans le groupe SB11 contre -100 (5) μm dans le groupe ranibizumab, avec une différence de traitement ajustée de -8 μm (IC à 95 %, -19 à 3 μm).
Les incidences des effets indésirables apparus au cours du traitement (231 sur 350 [66,0 %] vs 237 sur 354 [66,9 %]), y compris les effets indésirables graves apparus au cours du traitement (44 sur 350 [12,6 %] vs 44 sur 354 [12,4 %]) et les effets indésirables apparus au cours du traitement et ayant conduit à l’arrêt du médicament à l’étude (8 sur 350 [2,3 %] vs 5 sur 354 [1,4 %]), étaient similaires dans les groupes SB11 et ranibizumab. L’immunogénicité était faible, avec une incidence cumulative d’anticorps anti-médicament jusqu’à la semaine 24 de 3,0 % (10 sur 330) dans le groupe SB11 et de 3,1 % (10 sur 327) dans le groupe ranibizumab.
Conclusions et pertinence : Ces résultats d’efficacité équivalente et de profils de sécurité et d’immunogénicité similaires à ceux du ranibizumab soutiennent l’utilisation du SB11 pour les patients atteints de dégénérescence maculaire liée à l’âge néovasculaire.
Enregistrement de l’essai : Identifiant ClinicalTrials.gov : NCT03150589.
Identifiant ClinicalTrials.gov : NCT03150589
Étude visant à comparer le SB11 (biosimilaire proposé du ranibizumab) au Lucentis chez les sujets atteints de dégénérescence maculaire liée à l’âge néovasculaire (DMLA)11
Résumé : Il s’agit d’une étude multicentrique randomisée, à double insu, à groupes parallèles, visant à évaluer l’efficacité, la sécurité, la pharmacocinétique et l’immunogénicité du SB11 par rapport au Lucentis® chez des sujets atteints de DMLA néovasculaire.
Description détaillée : Les sujets seront randomisés dans un rapport 1 :1 pour recevoir soit SB11, soit Lucentis® (administré par voie intravitréenne (ITV) 0,5 mg toutes les 4 semaines). Les produits de recherche (IP) (SB11 ou Lucentis®) seront administrés jusqu’à la semaine 48, et la dernière évaluation sera effectuée à la semaine 52.
705 participants
Titre officiel : Étude multicentrique de phase III, randomisée, à double insu, à groupes parallèles, visant à comparer l’efficacité, l’innocuité, la pharmacocinétique et l’immunogénicité du SB11 et du Lucentis® chez des sujets atteints de dégénérescence maculaire liée à l’âge néovasculaire.
Date réelle de début de l’étude : 14 mars 2018
Date réelle de fin de l’étude primaire : 24 mai 2019
Date réelle de fin d’étude : 9 décembre 2019
Étude sur l’efficacité et la sécurité cliniques
de Razumab® (CESAR) : notre expérience avec le premier biosimilaire du ranibizumab au monde
Objectif : L’objectif de cette étude était d’évaluer l’efficacité et la sécurité du Razumab (le biosimilaire Ranibizumab d’Intas Pharmaceuticals Ltd) pour le traitement des maladies vasculaires choriorétiniennes telles que l’œdème maculaire diabétique (OMD), la membrane néovasculaire choroïdienne (MNVC) et l’œdème maculaire secondaire à une occlusion de la veine rétinienne (OVR)9
Méthodes : Nous avons mené une étude rétrospective monocentrique, incluant des patients atteints d’OMD, de MNVCet d’OVR, qui avaient reçu un traitement par Razumab® entre octobre 2018 et septembre 2019. Les mesures des résultats primaires comprenaient les changements de l’acuité visuelle à distance corrigée et de l’épaisseur fovéale centrale (EFC) entre la ligne de base et 1 mois et 3 mois. Les mesures des résultats secondaires comprenaient la pression intraoculaire (PIO) au jour 1, tout signe d’inflammation oculaire ou d’événements indésirables systémiques au cours du suivi.
Résultats : Cent cinquante-trois yeux de 141 patients ont été analysés. Les indications comprenaient l’OMD dans 70 (45,8 %) yeux, la MNVC dans 70 (45,8 %) yeux et l’OVR dans 13 (8,4 %) yeux. L’acuité visuelle à distance corrigée moyenne s’est améliorée par rapport aux valeurs de base (0,62 ± 0,44) jusqu’au mois 1 (0,45 ± 0,42) et s’est maintenue jusqu’à 3 mois (0,42 ± 0,44; P < 0,001). L’EFC moyenne a montré une réduction significative de la ligne de base (405,68 ± 192 422 μm) au mois 1 (286,08 ± 118,36 μm) et au mois 3 (271 ± 104,24 μm; P < 0,001). Aucun des yeux n’a enregistré de PIO > 20 mmHg au jour 1. Aucun signe de toxicité oculaire ou d’événement indésirable systémique n’a été noté.
Conclusion : Le Razumab® a montré une amélioration rapide de l’acuité visuelle à distance corrigée et de l’EFCT dans la plupart des yeux avec une efficacité observée dès 1 mois et maintenue jusqu’à 3 mois. Le Ranibizumab biosimilaire peut être un médicament sûr et efficace à faible coût pour le traitement des maladies maculaires.
Biogen et Samsung Bioepis lancent ranibizumab-nuna aux É.-U.
Les sociétés ont commercialisé le premier biosimilaire ophtalmologique approuvé par la FDA comme option de traitement pour les patients atteints de troubles rétiniens10,11,12

11 OPTOMÉTRISTE | MAI | JUIN 2023
Biogeninc. et Samsung Bioepis Co. ltée ont annoncé aujourd’hui que le ranibizumab-nuna (Byooviz), un biosimilaire faisant référence au ranibizumab (Lucentis, Genentech) a été lancé aux États-Unis.
Selon les sociétés, le ranibizumab-nuna, une injection, pour une utilisation intravitréenne, sera disponible commercialement à compter du 1er juillet auprès des principaux distributeurs des États-Unis, avec un prix catalogue de 1 130 $ par flacon à usage unique pour administrer une dose de 0,5 mg par injection intravitréenne.

Les biosimilaires sont des produits qui présentent des profils d’efficacité et de sécurité similaires à ceux du produit original. Une différence majeure entre le ranibizumab original et le biosimilaire est que ce dernier est considérablement moins cher.
La FDA a approuvé en septembre le ranibizumab-nuna, un inhibiteur du facteur de croissance de l’endothélium vasculaire (VEGF), pour le traitement de la dégénérescence maculaire liée à l’âge (DMLA) néovasculaire (humide), de l’œdème maculaire consécutif à une occlusion de la veine rétinienne et de la néovascularisation choroïdienne myopique.
La FDA a fondé son approbation du ranibizumab-nuna sur les résultats de la phase 3 de l’étude AMD (NCT03150589) dans laquelle le SB11 a été évalué pour le traitement de la DMLAN.
Dans cet essai multicentrique à répartition aléatoire, à double insu et à groupes parallèles, 705 patients ont été recrutés; 634 patients ont terminé l’étude à la semaine 52. Le produit biosimilaire a été comparé au ranibizumab de référence.
La DMLA néovasculaire (humide), bien que moins fréquente que la DMLA sèche, est responsable de la majorité des pertes de vision sévères et de la cécité associées à la DMLA1. Les thérapies anti-VEGF sont devenues un traitement standard de la DMLA humide, mais dans le monde réel, les coûts liés au traitement de la DMLA humide posent souvent des problèmes pour atteindre des résultats cliniques optimaux2. Les biosimilaires ont le potentiel d’alléger le fardeau financier associé aux thérapies anti-VEGF actuelles.
Ian Henshaw, premier vice-président et responsable mondial des biosimilaires chez Biogen, a noté dans un communiqué de presse que le lancement du ranibizu mab-nuna aux États-Unis est « un moment important pour les patients, les prestataires de soins, les payeurs et l’ensemble du système de santé ».
« Les patients souffrant de troubles vasculaires rétiniens disposent désormais d’une option de traitement plus abordable, a déclaré Henshaw dans un communiqué. Nos recherches auprès des médecins montrent que le coût est cité comme l’un des principaux obstacles au traite ment pour les patients, un tiers d’entre eux n’étant pas en mesure de payer le médicament. »
M. Henshaw a également noté que le ranibizumab-nuna a le potentiel d’élargir l’accès aux patients souffrant de troubles rétiniens qui peuvent entraîner une perte de vision permanente, tout en économisant des milliards de dollars au système de santé américain.
En outre, Christopher Hansung Ko, président et PDG de Samsung Bioepis, a noté dans le communiqué que le lancement du ranibizumab-nuna marque une étape clé dans l’augmentation des options et la réduction de la charge financière associée aux médicaments anti-VEGF actuels.
« La priorité de Samsung Bioepis est d’assurer l’accès des patients aux médicaments dont ils ont besoin, et nous continuerons à faire progresser notre pipeline afin d’améliorer l’accès aux médicaments biologiques, en tirant parti de notre décennie d’expérience dans le développement, la fabrication et la commercialisation de ces importants produits biologiques », a-t-il ajouté dans le communiqué.
Selon les sociétés, le ranibizumab-nuna est le premier biosimilaire lancé aux États-Unis dans le cadre du partenariat entre Biogen et Samsung Bioepis.
Outre les États-Unis, le ranibizumab-nuna a également été approuvé comme premier biosimilaire en ophtalmologie en Europe (2021), au Royaume-Uni (2021) et au Canada (2022).
Les sociétés ont également noté que l’accord de commercialisation de Biogen et Samsung Bioepis comprend deux candidats biosimilaires en ophtalmologie, le ranibizumab-nuna et le SB15, un candidat biosimilaire référençant l’aflibercept (Eylea, Regeneron Pharmaceuticals). Samsung Bioepis est responsable du développement, de l’enregistrement réglementaire et de la fabrication des produits, tandis que Biogen est responsable de la commercialisation.
La place des biosimilaires
En commentant la pertinence de l’approbation du produit pour la communauté ophtalmique, Se Joon Woo, MD, Ph. D., professeur au département d’ophtalmologie et directeur du centre de recherche et de développement des dispositifs médicaux à la faculté de médecine de l’université nationale de Séoul et à l’hôpital Bundang de l’université nationale de Séoul en Corée du Sud, a expliqué que l’approbation par la FDA du premier biosimilaire ophtalmique revêt une importance significative, car les ophtalmologistes ne connaissent pas les biosimilaires.
Les ophtalmologistes font confiance aux produits approuvés par la FDA, et le fait qu’il soit approuvé par la FDA
12 OPTOMÉTRISTE | MAI | JUIN 2023
Essai : Un biosimilaire anti-VEGF présente une faible immunogénicité
Immunogénicité d’un biosimilaire du ranibizumab sur les résultats du traitement chez les patients atteints de dégénérescence maculaire liée à l’âge néovasculaire.
L’immunogénicité d’un biosimilaire du ranibizumab n’a pas d’impact significatif sur les résultats du traitement chez les patients atteints de dégénérescence maculaire liée à l’âge néovasculaire (DMLAN) et d’autres maladies rétiniennes, selon une recherche publiée dans JAMA Ophthalmology13
Les investigateurs ont effectué une analyse post-hoc d’une étude d’équivalence de phase 3 randomisée, à double insu et à groupes parallèles afin d’examiner l’association entre l’immunogénicité au ranibizumab-nuna, précédemment appelé SB11, et le ranibizumab de référence. Ils ont également examiné les profils d’efficacité, de sécurité et de pharmacocinétique chez les patients (≥50 ans) atteints de DMLA néovasculaire et présentant des lésions actives de néovascularisation choroïdienne sous-fovéale.
L’étude originale multinationale et multicentrique a inclus des participants de 75 centres dans 9 pays et a été menée entre le 14 mars 2018 et le 9 décembre 2019 (identifiant ClinicalTrials.gov : NCT03150589). Pour cet essai, les patients ont été répartis au hasard (1 :1) pour recevoir des injections intravitréennes de ranibizumab-nuna (0,5 mg) ou de ranibizumab (0,5 mg) toutes les 4 semaines jusqu’à la semaine 48. Les principaux résultats étaient la modification de la meilleure acuité visuelle corrigée (MAVC) entre le début de l’étude et la semaine 8 et la modification de l’épaisseur du sous-champ central entre le début de l’étude et la semaine 4. Les résultats secondaires comprenaient les effets indésirables (EI), les concentrations sériques de ranibizumab et l’immunogénicité à différents moments jusqu’à la semaine 52.
Dans l’étude actuelle, les investigateurs ont comparé la MAVC, l’épaisseur du sous-champ central, les EI associés à l’inflammation intraoculaire et les concentrations sériques de ranibizumab entre les patients ADA-positifs et ADA-négatifs.
Les résultats suggèrent que l’incidence des anticorps anti-médicaments était faible pour les produits à base de ranibizumab et que son immunogénicité ne semblait pas avoir de lien cliniquement pertinent avec leur efficacité, leur sécurité ou leurs profils [pharmacocinétique].
Au total, 705 patients (âge moyen de 74,1 ans; 57,2 % de femmes et 42,8 % d’hommes) ont été inclus dans l’étude, et 634 d’entre eux ont terminé les 52 semaines de suivi. À la semaine 52, les investigateurs ont constaté que 4,9 % des patients étaient ADA-positifs et 95,1 % des patients étaient ADA-négatifs.
Cimerli (FYB201)
CIMERLIMC (ranibizumab-eqrn) est un biosimilaire approuvé par la FDA, interchangeable avec Lucentis® pour toutes les indications de Lucentis® approuvées par la FDA.
Anciennement CHS-201 (également connu sous le nom de FYB201), il s’agit d’un biosimilaire du produit de référence, Lucentis®. CIMERLIMC possède les mêmes attributs de produit que Lucentis®, à savoir les mêmes dosages (0,3 mg, 0,5 mg), la même formulation et les mêmes excipients, ainsi que la même séquence d’acides aminés.
Identifiant ClinicalTrials.gov : NCT02611778
Efficacité et sécurité du biosimilaire Ranibizumab FYB201 en comparaison avec Lucentis chez les patients atteints de dégénérescence maculaire liée à l’âge néovasculaire (COLUMBUS-AMD)14
Résumé : L’objectif de cette étude est de déterminer l’efficacité et la sécurité du ranibizumab biosimilaire FYB201 par rapport au Lucentis chez les patients atteints de dégénérescence maculaire liée à l’âge néovasculaire.
712 participants
Titre officiel : Efficacité et sécurité du ranibizumab biosimilaire FYB201 par rapport au Lucentis chez les patients atteints de dégénérescence maculaire liée à l’âge néovasculaire.
Date réelle de début de l’étude : 19 décembre 2015
Date réelle d’achèvement primaire : décembre 2017
Date réelle d’achèvement de l’étude : 6 juin 2018
CIMERLI a été approuvé par la Food and Drug Administration (FDA) des États-Unis en août 2022, après avoir satisfait aux normes de la FDA en matière de biosimilarité et d’interchangeabilité avec le produit de référence, y compris la sécurité, l’efficacité et la qualité.
Efficacité et sécurité du biosimilaire FYB201 par rapport au Ranibizumab dans la dégénérescence maculaire liée à l’âge néovasculaire
Pour le groupe d’étude COLUMBUS-AMD
Objectif : Cet essai a été mené pour étudier l’équivalence clinique du biosimilaire proposé FYB201 et du ranibizumab de référence chez des patients n’ayant jamais été traités et présentant une néovascularisation choroïdienne sous-fovéale causée par une dégénérescence maculaire liée à l’âge néovasculaire(DMLAN)15
Conception : Il s’agissait d’une étude prospective, multicentrique, avec évaluation à l’aveugle, à groupes parallèles, de phase III randomisée, d’une durée de 48 semaines.
Participants : Un total de 477 patients a été assigné au hasard pour recevoir FYB201 (n = 238) ou le ranibizumab de référence (n = 239).
Méthodes : Les patients ont reçu FYB201 ou le ranibizumab de référence 0,5 mg par injection intravitréenne (IVT) dans l’œil étudié toutes les 4 semaines.
13 OPTOMÉTRISTE | MAI | JUIN 2023
Secondary Endpoints: BCVA
•
Principaux critères d’évaluation : Le critère d’évaluation principal était le changement par rapport à la ligne de base de la meilleure acuité visuelle corrigée (MAVC) par les lettres de l’Early Treatment Diabetic Retinopathy Sudy (ETDRS) à 8 semaines avant la troisième injection mensuelle IVT. La biosimilarité de FYB201 avec son princeps a été évaluée par un test d’équivalence bilatéral, avec une marge d’équivalence en MAVC de 3 lettres ETDRS.
Résultats : La MAVC s’est améliorée dans les deux groupes, avec une amélioration moyenne de +5,1 (FYB201) et +5,6 (ranibizumab de référence) lettres ETDRS à la semaine 8. La différence moyenne des moindres carrés de l’analyse de covariance (ANCOVA) pour le changement par rapport à la ligne de base entre FYB201 et le ranibizumab de référence était de -0,4 lettre ETDRS avec un intervalle de confiance (IC) de 90 % de -1,6 à 0,9. Le critère d’évaluation primaire a été respecté, car l’IC à 90 % se situait dans la marge d’équivalence prédéfinie. Les effets indésirables étaient comparables entre les groupes de traitement.
Secondary Endpoints: FCP Retinal Thickness
• Mean (SD) change in study eye FCP retinal thickness was highly similar between FYB201 and reference ranibizumab over the course of the study
La moyenne (±ET) de la MAVC de l’œil étudié était très similaire entre FYB201 et le ranibizumab de référence au cours de l’étude16 cours de l’étude16
Conclusions : FYB201 est biosimilaire au ranibizumab de référence en termes d’efficacité clinique et de sécurité oculaire et systémique dans le traitement des patients atteints de DMLAN.
RÉFÉRENCES
1. https://www.healio.com/news/ophthalmology/20220831/ specialists-discuss-role-of-biosimilars-in-future-of-retinaldisease-management ?utm_source=selligent&utm_ medium=email&utm_campaign=news&M_ BT=216791041429
2. Arepalli S, Kaiser PK. Pipeline therapies for neovascular age related macular degeneration. Int J Retina Vitreous. 2 021 Oct 1;7(1):55. doi: 10.1186/s40942-021-00325-5. PMID: 34598731; PMCID: PMC8485527.
3. Sharma S, Sharma T, Prasad S, Gopalakrishnan M, Chaturvedi A. Treatment Landscape of Macular Disorders in Indian Patients with the Advent of Razumab™ (World’s First Biosimilar Ranibizumab): A Comprehensive Review. OphthalmolTher. 2 021 Sep;10(3):431-443. doi: 10.1007/ s40123-021-00362-1. Epub 2021 Jun 21. PMID: 34155608; PMCID: PMC8216589.
4. Sharma A, Kumar N, Parachuri N, Bandello F, Kuppermann BD, Loewenstein A. Biosimilars for Retinal Diseases: An Update. Am J Ophthalmol. 2021 Apr;224:36-42. doi: 10.1016/j.ajo.2020.11.017. Epub 2020 Dec 9. PMID: 33309691.
5. Bressler NM, Kim T, Oh I, Russo P, Kim MY, Woo SJ. Immunogenicity With Ranibizumab Biosimilar SB11 (Byooviz) and Reference Product Lucentis and Association With Efficacy, Safety, and Pharmacokinetics: A Post Hoc Analysis of a Phase 3 Randomized Clinical Trial. JAMA Ophthalmol. 2022 Dec 15. doi: 10.1001/ jamaophthalmol.2022.5403. Epub ahead of print. PMID: 36520462.
6. Kim E, Han J, Chae Y, Park H, Kim S, Kim S, Lee J, Kim BC. Evaluation of the Structural, Physicochemical, and Biological Characteristics of SB11, as Lucentis® (Ranibizumab) Biosimilar. OphthalmolTher. 2022 Apr;11(2):639-652. doi: 10.1007/s40123-022-00453-7. Epub 2 022 Jan 27. PMID: 35084693; PMCID: PMC8927571.
7. https://fr.wikipedia.org/wiki/Effet_nocebo
La variation moyenne (±ET) de l’épaisseur rétinienne du PCF de l’œil étudié était très similaire entre FYB201 et le ranibizumab de référence au cours de l’étude16
8. Woo SJ, Veith M, Hamouz J, Ernest J, Zalewski D, Studnicka J, Vajas A, Papp A, Gabor V, Luu J, Matuskova V, Yoon YH, Pregun T, Kim T, Shin D, Bressler NM. Efficacy and Safety of a Proposed Ranibizumab Biosimilar Product vs a Reference Ranibizumab Product for Patients With Neovascular Age-Related Macular Degeneration: A Randomized Clinical Trial. JAMA Ophthalmol. 2 021 Jan 1;139(1):68-76. doi: 10.1001/jamaophthalmol.2020.5053. PMID: 33211076; PMCID: PMC7677876.
9. Verma L, Thulasidas M, Purohit A, Gupta A, Narula R, Talwar D. Clinical efficacy and safety of Razumab® (CESAR) study: Our experience with the world's first biosimilar Ranibizumab. Indian J Ophthalmol. 2021 Feb;69(2):347-351. doi: 10.4103/ijo.IJO_2516_20. PMID: 33463589; PMCID: PMC7933889.
10. Woo SJ, Veith M, Hamouz J, Ernest J, Zalewski D, Studnicka J, Vajas A, Papp A, Gabor V, Luu J, Matuskova V, Yoon YH, Pregun T, Kim T, Shin D, Bressler NM. Efficacy and Safety of a Proposed Ranibizumab Biosimilar Product vs a Reference Ranibizumab Product for Patients With Neovascular Age-Related Macular Degeneration: A Randomized Clinical Trial. JAMA Ophthalmol. 2 021 Jan 1;139(1):68-76. doi: 10.1001/jamaophthalmol.2020.5053. PMID: 33211076; PMCID: PMC7677876.
11. https://clinicaltrials.gov/ct2/show/NCT03150589
12. https://www.ophthalmologytimes.com/view/biogensamsung-bioepis-launch-ranibizumab-nuna-in-us
13. https://www.ophthalmologyadvisor.com/topics/retinavitreous/ranibizumab-biosimilar-immunogenicity-doesnot-significantly-affect-neovascular-amd-outcomes/
14. https://clinicaltrials.gov/ct2/show/NCT02611778
15. Holz FG, Oleksy P, Ricci F, Kaiser PK, Kiefer J, Schmitz-Valckenberg S; COLUMBUS-AMD Study Group. Efficacy and Safety of Biosimilar FYB201 Compared with Ranibizumab in Neovascular Age-Related Macular Degeneration. Ophthalmology. 2022 Jan;129(1):54-63.
doi: 10.1016/j.ophtha.2021.04.031. Epub 2021 May 3. PMID: 33 957 183.
16. https://investors.coherus.com/static-files/ac9fee67-bbd34827-9b87-5e9524eaf2a1
14 OPTOMÉTRISTE | MAI | JUIN 2023
7 |
Mean
study eye BCVA was highly similar between FYB201 and reference ranibizumab over
course of the study BCVA, best corrected visual acuity; ETDRS, Early Treatment Diabetic Retinopathy Study; SD, standard deviation. Holz FG et al. Ophthalmology. 2021 May 3;S0161-6420(21)00325-0. doi: 10.1016/j.ophtha.2021.04.031. 0 10 20 30 40 50 60 70 80 90 Baseline48 12162024283236404448 Lettres ETDRS Moyennes ( ± ET ) Meilleure acuité
Semaines de l'étude FYB201 Reference ranibizumab
(SD)
the
visuelle corrigée moyenne
8 |
BCVA, best corrected visual acuity; ETDRS, Early Treatment Diabetic Retinopathy Study; FCP, foveal center point; SD, standard deviation. Holz FG et al. Ophthalmology 2021 May 3;S0161-6420(21)00325-0. doi: 10.1016/j.ophtha.2021.04.031. Baseline 4 8 12 16 20 24 28 32 36 40 44 48 Semaines à l'étude 0 –50 –100 –150 –200 –250 –300 –350 –400 FYB201 Reference ranibizumab Changements moyens depuis le départ ( ± ET
ACUVUEMD OASYS MAX 1-jour MULTIFOCALE réunit 3 technologies puissantes pour répondre à plus de besoins presbytes* .




Conception d’optimisation pupillaire

Pour une vision à toutes les distances1
• 100 % des paramètres adaptés aux variations de taille de la pupille en fonction de l’âge et de la réfraction^^2

• Même conception optique unique pour toutes les lentilles cornéennes ACUVUEMD multifocales2
• 92 % des patients s’adaptent avec succès à leur première paire lors de la première visite et 96 % s'adaptent avec succès à 2 paires de lentilles ou moins‡3
MC
Technologie LarmeStable
Pour un confort tout au long de la journée et une vision uniforme1
• Optimise la distribution de l’agent mouillant à travers la lentille et sur la surface4,5,6
• Notre seul et unique matériau de lentille conçu pour prolonger la stabilité du film lacrymal5



• Offre un taux d’évaporation 2 fois plus faible§4,6




Filtre de lumière OptiBleue

MC **
Pour une clarté dans toutes les conditions d'éclairage**1
Filtre la lumière bleue-violette** à 60 % – le niveau le plus élevé de l’industrie †† 4 Réduit la diffusion de la lumière‡‡5 Réduit les halos et les étoilements‡‡5
























* Comparativement à ACUVUEMD MOIST 1-JOUR MULTIFOCALE et ACUVUEMD OASYS MULTIFOCALE.

^^ Comparativement aux conceptions des produits concurrents; la technologie est optimisée aussi bien en fonction des paramètres d’erreur de réfraction qu’en fonction de la puissance d’addition.
‡ Quatre lentilles au total.
§ Comparativement à DAILIES Total1MD, MyDayMD et ULTRAMD ONE DAY. Également beaucoup moins élevé qu’ACUVUEMD OASYS 1-jour.
** Il n’a pas été démontré que la filtration de la lumière HEV par les lentilles cornéennes confère un quelconque avantage pour la santé de l’utilisateur, y compris, mais sans s’y limiter, la protection de la rétine, la protection contre la progression de la cataracte, la réduction de la fatigue oculaire, l’amélioration du contraste ou de l’acuité, la réduction de l’éblouissement, l’amélioration de la vision en faible luminosité, du rythme circadien ou du cycle de sommeil. Le professionnel de la vue doit être consulté pour de plus amples renseignements.
†† Comparativement aux informations accessibles au public pour les lentilles cornéennes 1-jour standard en date du mois de juillet 2022.
‡‡ Comparativement à ACUVUEMD OASYS 1-jour.
1. Données internes de JJV, 2022. Allégations subjectives autonomes pour les lentilles cornéennes ACUVUEMD OASYS MAX 1-jour MULTIFOCALE - Méta-analyse exploratoire. 2. Données internes de JJV, 2022. Technologie de CONCEPTION D’OPTIMISATION PUPILLAIRE ACUVUEMD : lentilles cornéennes JJVC, caractéristiques de la conception et avantages associés. 3. Données internes de JJV, 2022. Allégations de réussite de l’ajustement autonome des lentilles cornéennes ACUVUEMD OASYS MAX 1-jour MULTIFOCALE. 4. Données internes de JJV, 2022. Définition de la technologie LarmeStableMC 5. Données internes de JJV, 2022. Effet sur le film lacrymal et évaluation des artefacts visuels de la famille ACUVUEMD OASYS MAX 1-jour avec technologie LarmeStableMC 6. Données internes de JJV, 2022. Propriétés du matériau : lentilles cornéennes de marque ACUVUEMD MOIST 1-JOUR, ACUVUEMD TruEyeMD 1-JOUR, ACUVUEMD OASYS 1-jour avec technologie HydraLuxeMD, ACUVUEMD OASYS MAX 1-jour avec technologie LarmeStableMC et d’autres marques de lentilles 1-jour jetables. Informations importantes sur la sécurité : Les lentilles cornéennes ACUVUEMD sont recommandées pour corriger la vue. Comme toute lentille cornéenne, des problèmes oculaires peuvent se développer, y compris des ulcères cornéens. Certains porteurs peuvent ressentir une légère irritation, une démangeaison ou un inconfort. Les lentilles ne devraient pas être prescrites en cas d’infection ou d’inconfort oculaire, de larmoiement excessif, de changements de la vue, de rougeurs ou d'autres problèmes oculaires. Consulter la notice du produit pour obtenir plus d'information. Communiquer également avec les Soins de la vision Johnson & Johnson, division de Johnson & Johnson inc., en composant le 1 800 667-5099 ou en visitant fr.jnjvisionpro.ca
© Soins de la vision Johnson & Johnson, division de Johnson & Johnson inc. 2022 PP2022AVOM4242 Septembre 2022
Voici enfin la lentille multifocale que vos patients presbytes attendaient – vision claire et nette à toutes les distances et dans toutes les conditions d’éclairage en plus d'un confort tout au long de la journée
NOUVEAU
Dans le cas d’une kératoconjonctivite sèche (sécheresse oculaire) modérée ou sévère
Découvrez une production de larmes accrue grâce à CEQUAMC
PrCEQUAMC (solution ophtalmique de cyclosporine à 0,09 % p/v) est indiqué pour augmenter la production de larmes chez les patients atteints de kératoconjonctivite sèche (sécheresse oculaire) modérée ou sévère.

CEQUA est une préparation fondée sur la technologie des nanomicelles*

* La signification clinique n’est pas connue.
Usage clinique :
Enfants (< 18 ans) : L’efficacité et l’innocuité de CEQUA n’ont pas été établies chez les enfants. Santé Canada n’a donc pas autorisé d’indication pour cette population.
Personnes âgées (> 65 ans) : Dans l’ensemble, aucune différence n’a été observée sur le plan de l’innocuité ou de l’efficacité entre les patients âgés et les patients adultes plus jeunes.
Contre-indications :
• Patients qui présentent une hypersensibilité à ce médicament ou à l’un des composants du produit (y compris les ingrédients non médicinaux) ou du contenant
• Patients atteints d’infections oculaires ou périoculaires évolutives ou soupçonnées

• Patients atteints d’affections oculaires ou périoculaires malignes ou précancéreuses
Mises en garde et précautions pertinentes :
• Destiné à un usage ophtalmique topique seulement
• Il convient de résoudre les infections oculaires ou périoculaires existantes ou soupçonnées avant l’instauration d’un traitement par CEQUA. Si une infection se produit pendant le traitement, l’administration de CEQUA doit être interrompue jusqu’à ce que l’infection ait été enrayée.
• Il faut déconseiller aux patients de conduire un véhicule et d’utiliser des machines jusqu’à ce que leur vision soit redevenue normale après l’administration de CEQUA.
• CEQUA n’a pas été étudié chez des patients ayant des antécédents de kératite herpétique, de maladie des glandes lacrymales en phase terminale, de kératoconjonctivite sèche (KCS) causée par la destruction des cellules caliciformes conjonctivales comme dans le cas d’une carence en vitamine A, ou de tissu cicatriciel comme dans le cas d’une pemphigoïde cicatricielle, de brûlures causées par des produits alcalins, du syndrome de Stevens-Johnson, d’un trachome ou d’une exposition au rayonnement.
• Il faut surveiller de près les patients atteints d’une kératite grave.
• Risque de blessure et de contamination oculaires
• CEQUA ne doit pas être administré pendant que le patient porte des lentilles cornéennes.
• Infections et tumeurs locales : Une surveillance régulière est recommandée lorsque CEQUA est utilisé à long terme.
• Réactions d’hypersensibilité
• Les effets de CEQUA n’ont pas été étudiés chez des patients atteints d’insuffisance rénale ou hépatique.
• CEQUA est déconseillé pendant une grossesse, sauf si les avantages l’emportent sur les risques.
• Il faut faire preuve de prudence lors de l’administration de CEQUA aux femmes qui allaitent.
Pour de plus amples renseignements :
Veuillez consulter la monographie de CEQUA à l’adresse https://pdf.hres.ca/dpd_pm/00060038.PDF pour des renseignements importants non abordés ici concernant les effets indésirables, les interactions médicamenteuses et la posologie. Vous pouvez aussi obtenir la monographie du produit en communiquant avec notre Service médical au numéro sans frais 1 844 924-0656.
RÉFÉRENCE : Monographie de CEQUAMC actuelle, Sun Pharma Global FZE.
© 2022 Sun Pharma Canada Inc. Tous droits réservés. CEQUA est une marque de commerce de Sun Pharma Global FZE. Utilisée sous licence.
Optométristes
recherchés
Faites partie de l'équipe
Institut Nazareth et Louis-Braille
Nous offrons
Un emploi valorisant à proximité de chez vous
Un milieu de travail humain et flexible
Une collaboration interdisciplinaire
La possibilité de participer à des projets de recherche
Nos points de service

Longueuil - Saint-Jean-sur-Richelieu - Université de MontréalMontréal, Métro Radisson - Laval - Hôpital Notre-Dame Bientôt!
Vous avez des questions ou vous souhaitez nous faire parvenir votre candidature?
Écrivez-nous à : genevieve.lize.cisssmc16@ssss.gouv.qc.ca
PM-CA-CQA-0031F
 Dr Vincent Moore, OD, FAAO
Dr Vincent Moore, OD, FAAO
Les médicaments
biologiques biosimilaires : traitement de l’uvéite

Un médicament biologique biosimilaire, ou un biosimilaire, est un médicament biologique qui a démontré qu’il est très similaire et ne comporte aucune différence cliniquement significative en matière d’efficacité et de sécurité par rapport à un produit biologique2 de marque originale (« référence ») déjà autorisé pour la vente. Les biosimilaires peuvent devenir disponibles sur le marché suivant l’expiration de brevets et de périodes de protection des données propres au médicament biologique de référence1
Nom(s) de certaines marques de biosimilaires : HumiraMD, HadlimaMD, HulioMD, HyrimozMD, IdacioMD, AmgevitaMD (tant pour les maladies systémiques que pour l’uvéite).

Le TNF-α, cytokine pro-inflammatoire découverte en 1975, joue un rôle primordial dans les uvéites. Il est produit principalement par les lymphocytes T auxiliaires CD4 +, par les macrophages, par les polynucléaires neutrophiles et par les cellules endothéliales. Il stimule la prolifération de certaines cellules de l’inflammation (dont les macrophages), l’expression des molécules d’adhérence sur les cellules endothéliales et induit la sécrétion d’autres cytokines pro-inflammatoires (telles que les interleukines 1 et 6) et de monoxyde d’azote par les macrophages2
Dans les modèles animaux d’uvéite tels que l’uvéite auto-immune expérimentale (UAE), on a retrouvé des taux élevés de TNF-α1, de même que chez des patients présentant une uvéite. De plus, il a été démontré que la neutralisation du TNF-α dans les UAE diminuait l’activation macrophagique et donc la production de monoxyde d’azote, permettant de réduire les lésions rétiniennes.
Plusieurs études se sont penchées sur l’intérêt de l’infliximab et de l’adalimumab pour le contrôle de l’inflammation oculaire dans les uvéites non infectieuses. Ces uvéites étaient majoritairement réfractaires, c’est-à-dire non contrôlées après essai d’au moins un traitement immunosuppresseur.
18 OPTOMÉTRISTE | MAI | JUIN 2023
Le mélanome de l’uvée –mise à jou
ARTICLE 2 PAR LE DOCTEUR JEAN-PIERRE LAGACÉ OPTOMÉTRISTE,
M.Sc.
À noter que pour la majorité des études, le contrôle de l’inflammation oculaire était défini par une absence de Tyndall protéique et cellulaire en chambre antérieure, une absence de Tyndall vitréen, une réduction de l’œdème maculaire, une absence de vascularite ou d’œdème papillaire3
Pour l’infliximab, on a constaté une efficacité importante et prolongée du traitement, avec pour les plus grandes cohortes 78 % à 81,8 % de patients ayant une inflammation oculaire contrôlée, pour un suivi moyen allant jusqu’à 29 mois4,5. Les résultats ont été tout aussi spectaculaires pour l’adalimumab, avec 68 % à 81,7 % de patients répondeurs, pour un suivi moyen allant jusqu’à 22 mois6,8. Le délai moyen de réponse complète aux anti-TNF-α était d’environ 2 mois.
Une étude rétrospective française récente de 160 patients a démontré qu’il n’existait pas de différence d’efficacité entre l’infliximab et l’adalimumab pour le contrôle de l’inflammation oculaire des uvéites non infectieuses réfractaires, avec 97 % de patients répondeurs à l’infliximab et 95 % à l’adalimumab au bout de 12 mois de traitement9
Il est également important de souligner que le traitement par anti-TNF-α est efficace sur l’œdème maculaire réfractaire associé aux uvéites non infectieuses, et permet ainsi une diminution de l’épaisseur maculaire en sevrant en parallèle la corticothérapie locale7,8,10,11. Cela semble logique lorsque l’on sait que le TNF-α participe à la régulation du taux de VEGF dans l’œil, contribue à son augmentation et est donc associé à l’apparition d’œdème maculaire et de néovascularisation choroïdienne.
L’adalimumab
D’abord utilisé pour diverses pathologies systémiques, l’adalimumab est un anticorps monoclonal thérapeutique, commercialisé depuis 2003 sous le nom d’Humira.
Comme l’indique son suffixe-mumab, l’adalimumab est un anticorp sintégralement humain (fully human), capable de lier letumor necrosis factoralpha(TNF-α), ou facteur de nécrose tumorale α. En se complexant avec cettec ytokinepro-inflammatoire, il empêche son interaction avec son récepteur et module ainsi les processus inflammatoires TNF-α dépendants2
Indications systémiques :
� Polyarthrite rhumatoïde de l’adulte dans ses formes résistantes;
� Rhumatisme psoriasique de l’adulte;
� Maladie de Crohn;
� Rectocolite hémorragique(RCH) ou colite ulcéreuse;
� Spondylarthrite ankylosante;
� Psoriasis en plaques chez l’adulte.
HUMIRA® (adalimumab), un médicament d’AbbVie, est homologué par Santé Canada pour le traitement de l’uvéite antérieure non infectieuse chronique chez les enfants13 :
L’homologation de cette nouvelle indication d’HUMIRA fait en sorte que cet agent est aujourd’hui le seul médicament biologique offert au Canada pour le traitement des enfants âgés de 2 ans ou plus atteints d’uvéite antérieure non infectieuse chronique qui n’ont pas répondu de façon satisfaisante à un traitement classique.
� Cette homologation repose sur les résultats de l’étude SYCAMORE, une étude clinique entreprise à l’initiative de chercheurs, qui a révélé que l’emploi d’HUMIRA en association avec le méthotrexate a permis de prolonger de façon significative le temps écoulé avant l’échec thérapeutique, comparativement à l’association méthotrexate et placebo chez des enfants atteints d’uvéite associée à l’arthrite juvénile idiopathique évolutive.
� L’arthrite juvénile idiopathique est la maladie intéressant tout l’organisme le plus souvent associée à l’uvéite non infectieuse chez les enfants, puisqu’elle touche plus de 75 % des enfants atteints d’uvéite antérieure.
Vers 2019, Santé Canada a approuvé l’utilisation d’HUMIRA® (adalimumab) pour le traitement de l’uvéite antérieure non infectieuse chronique chez les enfants âgés de 2 ans ou plus qui n’ont pas répondu de façon satisfaisante ou qui présentent une intolérance à un traitement classique, ainsi que chez ceux pour lesquels un traitement classique est inapproprié. HUMIRA est aujourd’hui le seul médicament biologique qui soit homologué au Canada pour le traitement de cette affection chez les enfants âgés de 2 ans ou plus.
L’uvéite est une inflammation de l’uvée, qui comprend l’iris, la choroïde et le corps ciliaire de l’œil. Si elle n’est pas traitée, elle peut se solder par une perte de vision imputable, entre autres, à des cataractes, au glaucome et à un œdème maculaire cystoïde (OMC). Selon les estimations, l’uvéite provoquerait une perte de vision grave chez 25 % à 30 % des enfants qui en sont atteints, d’où l’absolue nécessité de la diagnostiquer et de la traiter rapidement afin de préserver leur vision. L’arthrite juvénile idiopathique est la maladie intéressant tout l’organisme le plus souvent associée à l’uvéite chez les enfants, puisque plus de 75 % des enfants atteints d’uvéite antérieure souffrent aussi de cette forme d’arthrite.
« Pour beaucoup d’enfants, un diagnostic d’uvéite est une mauvaise nouvelle en raison des nombreuses visites à l’hôpital qu’implique cette maladie, de la menace d’une perte de vision et de l’anxiété vécue par toute la famille, a expliqué le Dr Éric Fortin, ophtalmologue de la Clinique universitaire de la vision de l’Université de Montréal. Espérons que l’homologation d’HUMIRA pour le traitement de l’uvéite chez les enfants fera en sorte que ceux qui en auront besoin y auront accès plus facilement. C’est très important pour moi et pour mes patients ».
19 OPTOMÉTRISTE | MAI | JUIN 2023
« L’uvéite chez l’enfant est une maladie invalidante et pouvant entraîner la cécité, ce qui est une source de problèmes écrasants pour les enfants et leur famille, a affirmé Christina Pelizon, directrice des Affaires médicales chez AbbVie Canada. L’étude SYCAMORE a révélé que l’emploi d’HUMIRA en association avec le méthotrexate a permis de prolonger significativement le temps écoulé avant l’échec thérapeutique, comparativement à l’association méthotrexate et placebo. Ces résultats montrent bien qu’HUMIRA a ce qu’il faut pour aider à protéger les yeux de beaucoup d’enfants contre les complications de l’uvéite antérieure non infectieuse chronique réfractaire aux traitements classiques ».
L’étude SYCAMORE est une étude clinique à répartition aléatoire ayant servi à comparer l’efficacité et l’innocuité cliniques d’HUMIRA administré avec du méthotrexate et celles du méthotrexate administré avec un placebo dans le traitement de l’uvéite associée à une arthrite juvénile idiopathique évolutive. Elle a été commanditée par le University Hospitals Bristol NHS Foundation Trust, et le Clinical Trials Research Centre de l’Université de Liverpool en a assuré la coordination. Le comité indépendant de pharmacovigilance a rapidement recommandé la levée de l’insu après la répartition aléatoire de 90 enfants atteints d’uvéite associée à une arthrite juvénile idiopathique évolutive parce qu’HUMIRA administré avec du méthotrexate, comparativement au méthotrexate administré avec un placebo, permettait de mieux maîtriser l’inflammation oculaire et était associé à un taux d’échec thérapeutique significativement plus faible, celui-ci étant défini d’après plusieurs critères dont de nombreuses particularités physiologiques de l’inflammation intraoculaire1
À propos de l’étude SYCAMORE
L’étude clinique SYCAMORE a été commanditée par le University Hospitals Bristol NHS Foundation Trust, et le Centre de recherche clinique de l’Université de Liverpool en a assuré la coordination. Sa réalisation a été rendue possible grâce à des subventions octroyées par le National Institute for Health Research, dans le cadre du programme Health Technology Assessment et par Arthritis Research UK. Au cours de cette étude multicentrique, à double insu, à répartition aléatoire et comparative avec placebo, des chercheurs ont évalué l’efficacité et l’innocuité d’HUMIRA chez des enfants et des adolescents âgés de 2 ans ou plus atteints d’une uvéite antérieure non infectieuse associée à une arthrite juvénile idiopathique évolutive et dont la maladie s’est révélée réfractaire à un traitement par le méthotrexate d’une durée d’au moins 12 semaines.
Les patients qui recevaient une dose stable de méthotrexate ont été affectés aléatoirement, dans un rapport de 2 pour 1, à HUMIRA (à des doses de 20 mg ou de 40 mg en fonction de leur poids) ou à un placebo, administrés par voie sous-cutanée toutes les 2 semaines. Ils ont poursuivi le traitement à l’étude jusqu’à l’échec thérapeutique ou pendant 18 mois au maximum et ont été suivis pendant une période pouvant aller jusqu’à 2 ans après la répartition aléatoire, ce qui comprenait une période de 6 mois sans médicament à l’étude.
Le paramètre d’évaluation principal était le temps écoulé avant l’échec du traitement, celui-ci étant défini d’après au moins un des critères suivants : manifestations multiples d’une inflammation intraoculaire, aggravation ou apparition d’ophtalmopathies concomitantes, utilisation de médicaments non autorisés ou dans des circonstances ne respectant pas les critères prescrits et interruption du traitement pendant une période prolongée.
Les résultats de l’étude montrent que l’ajout d’HUMIRA au méthotrexate a permis de prolonger significativement le temps écoulé avant l’échec du traitement, comparativement au placebo. En outre, les critères régissant l’arrêt du recrutement ont été satisfaits après que 90 sujets sur les 114 prévus au départ ont été recrutés. Les chercheurs ont recensé 16 cas d’échec thérapeutique chez les 60 patients (27 %) traités par HUMIRA et 18 chez les 30 témoins (60 %) (rapport des risques instantanés : 0,25; intervalle de confiance [IC] à 99,9 % : de 0,08 à 0,79; p < 0,0001 [la limite régissant l’arrêt du recrutement]).
Les effets secondaires courants d’HUMIRA comprennent : réactions au point d’injection (rougeur, enflure, démangeaison, douleur ou ecchymose), toux et symptômes du rhume, céphalées, éruptions cutanées, nausées, pneumonie, fièvre et douleurs abdominales.HUMIRA est administré par injection sous la peau (sous-cutanée). Avant d’entreprendre le traitement par HUMIRA, il faut soupeser soigneusement les bienfaits et les risques possibles du traitement.
Uvéites et biothérapies
Les biothérapies utilisées dans le traitement des uvéites non infectieuses incluent l’interféron (IFN), les immunoglobulines intraveineuses (IgIV), ainsi que les anticorps monoclonaux et les protéines de fusion (anti-TNFα, anakinra, tocilizumab, rituximab). L’IFN permet d’induire une rémission prolongée, se maintenant après l’arrêt du traitement, chez 20 % à 40 % des patients. Les effets secondaires (syndrome pseudo-grippal, effets psychiatriques) limitent son utilisation. Les anti-TNFα (infliximab, adalimumab) représentent une alternative thérapeutique attractive dans les uvéites sévères résistantes aux immunosuppresseurs, en particulier dans la maladie de Behçet. Ils sont efficaces la plupart du temps (> 90 % des cas), et rapidement; mais leur action est souvent suspensive14
Les anti-TNFα sont utilisées de façon prolongée ou dans l’attente de l’efficacité d’un autre immunosuppresseur, une fois l’inflammation oculaire contrôlée. Les IgIV sont utilisées dans la maladie de Birdshot. Leur tolérance est bonne, mais leur efficacité est transitoire. Le rituximab a montré son efficacité dans quelques observations d’inflammations oculaires variées (uvéites, sclérites et pseudotumeurs inflammatoires associées à la granulomatose avec polyangéite) ainsi que dans la pemphigoïde cicatricielle. Le risque d’infection limite son utilisation dans les maladies résistantes aux traitements conventionnels. L’anakinra (anti-IL1R) a montré des résultats intéressants en matière d’efficacité dans une petite étude ouverte sur la maladie de Behçet. Sa sécurité d’utilisation est bonne et son court délai d’action peut être intéressant pour le traitement des uvéites sévères.
20 OPTOMÉTRISTE | MAI | JUIN 2023
Sur la base des données disponibles (2 études versus placebo : VISUAL I et VISUAL II, et 2 études observationnelles rétrospectives : Réseau Français Uvéite et Réseau Français maladie de Behçet), ont été démontrées15 : � la supériorité de l’adalimumab en ce qui concerne le pourcentage de patients ayant eu une rechute à partir de la 6e ou la 2e semaine de traitement; � l’efficacité similaire entre l’infliximab et l’adalimumab en pratique réelle et une épargne cortisonique avec ces anti-TNF alfa.
L’adalimumab supérieur à l’infliximab dans l’uvéite due à la maladie de Behçet
L’anticorps anti-TNF adalimumab (Humira*, Abbvie) s’est montré supérieur à l’anti-TNF infliximab en traitement de l’uvéite réfractaire due à la maladie de Behçet, dans une étude publiée par Arthritis & Rheumatology16
L’adalimumab est indiqué dans le traitement des uvéites non infectieuses. Mais dans les études VISUAL qui ont conduit à l’obtention de cette indication, il y avait très peu d’uvéites dues à la maladie de Behçet. Par ailleurs, on a peu de données de comparaison entre l’adalimumab et l’infliximab dans les uvéites.
C’est pourquoi Belén Atienza-Mateo de l’hôpital Universitaire de Santander et ses collègues de nombreux établissements espagnols ont conduit une étude pour comparer les deux anti-TNF chez 177 patients souffrant d’uvéite réfractaire (persistant malgré un corticoïde systémique à haute dose et des immunosuppresseurs) due à la maladie de Behçet (pour 316 yeux). L’anti-TNF était choisi par le médecin en accord avec le patient : ce fut l’infliximab pour 103 patients et l’adalimumab pour 74.
Après un an de suivi, l’uvéite s’est améliorée avec les deux médicaments. Mais les résultats étaient meilleurs avec l’adalimumab. Le bénéfice avec ce dernier était supérieur sur l’inflammation antérieure et sur la vitrite et apparaissait plus rapidement.
De plus, l’acuité visuelle a été améliorée : 0,81 avec l’adalimumab contre 0,67 avec l’infliximab. L’épaisseur de la macula était légèrement (mais non significativement) diminuée.
Davantage de patients recevant l’adalimumab, en proportion, ont gardé ce traitement : 95,2 % comparé à 84,9 % avec l’infliximab. Les chercheurs notent toutefois que cela pourrait être dû au mode d’administration : sous-cutané pour l’adalimumab et intraveineux pour l’infliximab.
HYRIMOZMC
Uvéite
Avis transmis au ministre en octobre 2022
Marque de commerce : Hyrimoz
Dénomination commune : Adalimumab
Fabricant : Sandoz
Forme : Solution injectable sous-cutanée (seringue, stylo)
Teneurs : 50 mg/ml (0,8 ml et 0,4 ml)
Inscription – Avec conditions
RECOMMANDATION
En tenant compte de l’ensemble des aspects prévus par la loi, l’Institut national d’excellence en santé et en services sociaux (INESSS) recommande au ministre d’ajouter une indication reconnue à HulioMC sur les listes des médicaments pour le traitement de l’uvéite, si les conditions suivantes sont respectées.
Conditions
� Médicament d’exception;
� Atténuation du fardeau économique.
Indication reconnue pour le paiement
Pour le traitement des personnes atteintes d’uvéite non infectieuse qui ont fait l’essai d’un corticostéroïde et d’un immunosuppresseur pour une durée appropriée, à moins d’intolérance sérieuse ou de contre-indication.
L’autorisation initiale est donnée pour une durée maximale de 6 mois.
Lors des demandes pour la poursuite du traitement, le médecin devra fournir la preuve d’un effet clinique bénéfique. Les autorisations subséquentes sont données pour une durée maximale de 12 mois.
Évaluation
DESCRIPTION DU
MÉDICAMENT
HulioMC est un médicament biosimilaire de l’adalimumab, dont le produit de référence est HumiraMC. L’adalimumab est un anticorps monoclonal humain recombinant qui s’administre par voie sous cutanée.
Il se lie de manière concurrentielle au facteur de nécrose tumorale alpha (TNFα), ce qui prévient la réponse inflammatoire. HulioMC, tout comme son produit de référence HumiraMC, est notamment indiqué :
HULIOMC
Uvéite
Avis transmis au ministre en octobre 2022
Marque de commerce : Hulio
Dénomination commune : Adalimumab
Fabricant : BGP Pharma
Forme : Solution injectable sous-cutanée (seringue, stylo)
Teneurs : 50 mg/ml (0,8 ml et 0,4 ml)
� pour le traitement de « l’uvéite non infectieuse (uvéite intermédiaire, uvéite postérieure et panuvéite) chez les adultes qui n’ont pas répondu de façon satisfaisante à une corticothérapie ou comme traitement d’épargne des corticostéroïdes chez les patients corticodépendants », et
� pour le traitement de « l’uvéite antérieure non infectieuse chronique chez les enfants âgés de 2 ans et plus qui n’ont pas répondu de façon satisfaisante ou qui présentent une intolérance à un traitement classique ainsi que chez ceux pour lesquels un traitement classique est inapproprié ».
21 OPTOMÉTRISTE | MAI | JUIN 2023
L’adalimumab (HULIOMC et HYRIMOZMC) –étude de l’Institut national d’excellence en santé et en services sociaux (INESSS)
CONTEXTE DE L’ÉVALUATION
Il s’agit de la 1re évaluation de l’adalimumab par l’INESSS pour cette indication. À titre informatif, d’autres biosimilaires de l’adalimumab (AmgevitaMC et HyrimozMC) font présentement l’objet d’une évaluation à l’INESSS pour le traitement de l’uvéite non infectieuse chez les adultes et les enfants.
Le but du traitement est de diminuer l’inflammation et d’éviter les complications qui peuvent aller jusqu’à la cécité.
Le choix de traitement de l’uvéite non infectieuse tient compte entre autres de son emplacement, de sa gravité et de la cause sous-jacente le cas échéant, telle qu’une maladie auto-immune.
Le traitement de l’uvéite non infectieuse peut comprendre notamment des injections périoculaires ou intraoculaires de corticostéroïdes. Lorsque ceux-ci ne sont pas indiqués ou qu’ils sont inefficaces, des corticostéroïdes systémiques sont habituellement utilisés, notamment la prednisone sous forme orale. De plus, certains immunosuppresseurs tels que l’azathioprine, la cyclosporine, le méthotrexate, le mycophénolate mofétil ou le tacrolimus peuvent être envisagés selon la présence d’une maladie sous jacente et la nature de celle-ci. En pédiatrie, le méthotrexate est d’ailleurs un médicament qui peut être utilisé pour le traitement de l’arthrite juvénile idiopathique ainsi que de l’uvéite associée à celle-ci. Toutefois, les immunosuppresseurs peuvent entraîner des effets indésirables sérieux et ils ne sont pas homologués pour le traitement de l’uvéite au Canada.
Des agents biologiques peuvent également être considérés, notamment en cas d’inefficacité de ces traitements ou bien d’intolérance ou de contre-indication à ces derniers. L’adalimumab est actuellement le seul agent biologique homologué par Santé Canada pour cette indication. Il ne figure pas sur les listes des médicaments pour le traitement de cette maladie, néanmoins, certains patients peuvent y avoir accès par la mesure du patient d’exception.
Besoin de santé Les options médicamenteuses pour le traitement de l’uvéite non infectieuse sont limitées. Il existe un besoin de nouvelles thérapies efficaces et bien tolérées, particulièrement pour les patients qui ont présenté une réponse inadéquate aux corticostéroïdes oraux ainsi que pour ceux qui n’ont pas répondu aux immunosuppresseurs.
Analyse des données Les études cliniques décrites ci-dessous ont été effectuées avec le produit biologique de référence (HumiraMC). En accord avec le processus d’évaluation des médicaments biosimilaires de l’INESSS, l’avis de conformité émis par Santé Canada confirme qu’HulioMC est similaire sur le plan de la qualité et qu’il n’existe aucune différence cliniquement significative entre les 2 produits aux chapitres de l’efficacité et de l’innocuité. Par conséquent, les résultats obtenus peuvent être extrapolés au biosimilaire.
Parmi les publications analysées, les études VISUAL I (Jaffe 2016), VISUAL II (Nguyen 2016), VISUAL III (Suhler 2020) et SYCAMORE (Ramanan 2017) ont été retenues pour l’évaluation de la valeur thérapeutique.
VISUAL I : Il s’agit d’une étude de phase III multicentrique, à répartition aléatoire et à double insu, qui a pour but d’évaluer l’efficacité et l’innocuité de l’adalimumab chez des adultes atteints d’uvéite active non infectieuse. Pour être inclus, les patients devaient avoir reçu un diagnostic d’uvéite non infectieuse intermédiaire ou postérieure, ou bien de panuvéite.
Leur maladie devait être active à la visite initiale, ce qui était défini par la présence d’au moins 1 des éléments suivants dans au moins 1 œil, malgré 2 semaines ou plus de prednisone orale à la dose de 10 à 60 mg ou l’équivalent :
� au moins 1 lésion active inflammatoire choriorétinienne ou vasculaire rétinienne;
� un grade cellulaire de la chambre antérieure d’au moins 2+ selon les critères Standardization of Uveitis Nomenclature (SUN);
� un grade d’opacité du vitré d’au moins 2+ selon les critères du National Eye Institute (NEI) adapté par SUN.
Les patients ont été répartis de façon aléatoire pour recevoir soit l’adalimumab 80 mg à la semaine 0 puis 40 mg toutes les 2 semaines à partir de la semaine 1, soit un placebo. De plus, ils ont reçu 60 mg de prednisone par jour de façon concomitante. La dose de prednisone a été diminuée de façon standardisée jusqu’à l’arrêt complet à la semaine 15. Le paramètre d’évaluation principal est un critère composé du temps écoulé avant l’échec du traitement dans au moins 1 œil, échec défini par la présence d’au moins 1 des 4 éléments suivants :
� nouvelles lésions inflammatoires;
� augmentation de 2 niveaux du grade cellulaire de la chambre antérieure après la semaine 6 ou un grade cellulaire qui n’a pas diminué d’au moins 0,5+ à la semaine 6;
� augmentation de 2 niveaux du grade d’opacité du vitré après la semaine 6 ou un grade qui n’a pas diminué d’au moins 0,5+ à la semaine 6;
� diminution de la meilleure acuité visuelle corrigée (MAVC) de 15 lettres ou plus. La durée maximale de l’étude est déterminée par la 1re des 2 situations suivantes : atteinte de la semaine 80 ou atteinte de 138 événements d’échec du traitement.
22 OPTOMÉTRISTE | MAI | JUIN 2023
Les résultats démontrent que l’adalimumab est plus efficace que le placebo pour réduire le risque d’échec du traitement, échec défini par l’un des 4 éléments du critère composé, soit l’apparition de nouvelles lésions inflammatoires, l’augmentation du grade cellulaire de la chambre antérieure, l’augmentation du grade d’opacité du vitré et la diminution de la meilleure acuité visuelle corrigée. Ces résultats sont considérés comme cliniquement significatifs. De plus, les bénéfices semblent s’observer sur tous les éléments définissant l’échec du traitement lorsqu’ils sont analysés de façon individuelle, bien qu’il s’agisse d’analyses exploratoires.
VISUAL II : Il s’agit d’une étude de phase III multicentrique, à répartition aléatoire et à double insu, qui a pour but d’évaluer l’efficacité et l’innocuité de l’adalimumab chez des adultes atteints d’uvéite inactive non infectieuse. Pour être inclus, les patients devaient avoir reçu un diagnostic d’uvéite non infectieuse, intermédiaire ou postérieure, ou de panuvéite contrôlée par de la prednisone à la dose de 10 à 35 mg par jour. De plus, ils devaient avoir eu au moins 1 poussée de la maladie documentée dans les 18 mois précédant l’inclusion et celle-ci devait avoir eu lieu au maximum 28 jours après diminution de la dose de corticostéroïdes oraux. À la visite initiale, l’uvéite devait être inactive depuis au moins 28 jours, l’uvéite inactive étant définie par 3 éléments dans les 2 yeux, soit l’absence de lésion active inflammatoire choriorétinienne ou vasculaire rétinienne, un grade cellulaire de la chambre antérieure de 0,5+ ou moins selon les critères de SUN et un grade d’opacité du vitré de 0,5+ ou moins selon les critères du NEI adaptés par le SUN.
Les patients ont été répartis de façon aléatoire pour recevoir soit de l’adalimumab 80 mg à la semaine 0 puis 40 mg toutes les 2 semaines à partir de la semaine 1, soit un placebo. À partir de la semaine 2, tous les patients devaient diminuer progressivement la prednisone de façon standardisée jusqu’à l’arrêt complet à la semaine 19. Le paramètre d’évaluation principal est un critère composé du temps écoulé avant l’échec du traitement dans au moins 1 œil, échec défini par la présence d’au moins 1 des 4 éléments suivants à partir de la semaine 2 :
� nouvelles lésions actives inflammatoires;
� augmentation de 2 niveaux du grade cellulaire de la chambre antérieure;
� augmentation de 2 niveaux du grade d’opacité du vitré;
� diminution de la MAVC de 15 lettres ou plus. La durée maximale de l’étude est déterminée par la 1re des 2 situations suivantes : atteinte de la semaine 80 ou atteinte de 106 événements d’échec du traitement.
Les résultats démontrent que l’adalimumab est plus efficace que le placebo pour réduire le risque d’échec du traitement, échec défini par l’un des 4 éléments du critère composé, soit l’apparition de nouvelles lésions inflammatoires, l’augmentation du grade cellulaire de la chambre antérieure, l’augmentation du grade d’opacité du vitré et la diminution de la meilleure acuité visuelle corrigée. L’ampleur des bénéfices est considérée comme cliniquement significative. Lorsque les différentes composantes du critère composé sont analysées de façon individuelle, un bénéfice en faveur de l’adalimumab semble se dégager pour la diminution de la MAVC seulement. Ces analyses sont toutefois exploratoires.
VISUAL III : Il s’agit d’une étude qui a pour but d’évaluer l’efficacité et l’innocuité à long terme de l’adalimumab chez des adultes atteints d’uvéite qui ont participé aux essais VISUAL I et II. Les patients inclus pouvaient avoir une uvéite active ou inactive à l’entrée dans l’étude de prolongation. Les 364 patients participants ont reçu de l’adalimumab 40 mg toutes les 2 semaines jusqu’à un maximum de 362 semaines. Les données ont été analysées jusqu’à 150 semaines. Le paramètre d’évaluation principal est la quiescence, définie par l’absence de nouvelle lésion active inflammatoire choriorétinienne ou vasculaire rétinienne, un grade cellulaire de la chambre antérieure de 0,5+ ou moins dans les 2 yeux et un grade d’opacité du vitré de 0,5+ ou moins dans les 2 yeux.
Les principaux résultats, portant sur la population en intention de traiter, à la semaine 150 sont les suivants :
� 85 % des patients avaient une quiescence, soit 80 % de ceux qui avaient une uvéite active à l’inclusion et 96 % de ceux qui avaient une uvéite inactive;
� La quiescence sans corticostéroïdes a été atteinte par 54 % des patients qui avaient une uvéite active à l’inclusion et 89 % de ceux qui avaient une uvéite inactive;
� La dose moyenne de corticostéroïde systémique utilisée par les patients est passée de 9,4 mg à la semaine 0 à 1,5 mg.
Les résultats indiquent que l’adalimumab permettrait de maintenir une quiescence ainsi qu’une quiescence sans corticostéroïdes à long terme. De plus, ce traitement permet de diminuer l’usage des corticostéroïdes à long terme.
Étude SYCAMORE
Il s’agit d’une étude multicentrique, à répartition aléatoire et à double insu, qui a pour but d’évaluer l’efficacité et l’innocuité de l’adalimumab chez des enfants âgés de 2 ans ou plus atteints d’uvéite. Pour être inclus, les patients devaient avoir une uvéite antérieure active associée à l’arthrite juvénile idiopathique et recevoir 1 dose hebdomadaire stable de méthotrexate de 10 à 20 mg/m2 (maximum 25 mg) depuis au moins 12 semaines. L’uvéite active était définie par un grade cellulaire de la chambre antérieure d’au moins 1+ selon les critères SUN, et ce, à au moins 2 reprises durant les 12 semaines avant l’inclusion, malgré l’usage de méthotrexate et d’un glucocorticoïde topique ou systémique.
23 OPTOMÉTRISTE | MAI | JUIN 2023
Les patients étaient répartis de manière à recevoir toutes les 2 semaines, selon un ratio 2 :1, l’adalimumab à la dose de 20 mg pour les patients de moins de 30 kg et de 40 mg pour ceux de 30 kg ou plus, ou un placebo. Le paramètre d’évaluation principal est un critère composé du temps écoulé avant l’échec du traitement dans au moins 1 œil, échec défini par la présence d’au moins 1 des éléments suivants : l’utilisation de médicaments non autorisés, l’arrêt du traitement à l’étude de façon intermittente ou continue pour une période cumulative de plus de 4 semaines, l’aggravation d’une condition oculaire coexistante à l’inclusion 3 mois après le début de l’étude, ou 1 des éléments suivants en lien avec le grade cellulaire de la chambre antérieure :
� augmentation d’au moins 2 grades lors de 2 visites consécutives;
� aucun changement lors de 2 mesures consécutives chez les patients qui avaient un grade 3 ou plus à l’inclusion;
� diminution d’un grade ou aucun changement par rapport à la valeur initiale, ainsi que le développement d’une autre condition oculaire coexistante et soutenue sur une période de 2 visites consécutives;
� grade 1 ou 2 à l’inclusion toujours présent 6 mois après le début de l’étude, lors de 2 visites consécutives.
RÉFÉRENCES
1. https ://www.sandoz.ca/fr/news/media-releases/sandozcanada-recoit-l%27autorisation-de-sante-canada-delancer-le-nouveau
2. https ://www.realites-ophtalmologiques.com/2017/01/20/ interet-anti-tnf-alpha-traitement-uveites-non-infectieuses/
3. Nakamura S, Yamakawa T, Sugita M et al. The role of tumor necrosis factor-alpha in the induction of experimental autoimmune uveoretinitis in mice. Invest Ophthalmol Vis Sci, 1994;35 :3884-3889.
4. Suhler EB, Smith JR, Wwertheim MS et al. A prospective trial of infliximab therapy for refractory uveitis : preliminary safety and efficacy outcomes. Arch Ophthalmol, 2005;123 :903-912.
5. Kruh JN, Yang P, Suelves AM et al. Infliximab for the treatment of refractory noninfectious Uveitis : a study of 88 patients with long-term follow-up. Ophthalmology, 2014;121 :358-364.
6. Suhler EB, Lowder CY, Goldstein DA et al. Adalimumab therapy for refractory uveitis : results of a multicentre, open-label, prospective trial. Br J Ophthalmol, 2013;97 :481486.
7. Díaz-llopis M, Salom D, Garcia-De-Vicuña C et al. Treatment of refractory uveitis with adalimumab : a prospective multicenter study of 131 patients. Ophthalmology, 2012;119 :1575-1581.
8. Dobner BC, Max R, Becker MD et al. A three centre experience with adalimumab for the treatment of noninfectious uveitis. Br J Ophthalmol, 2013;97 :134-138.
9. Vallet H, Seve P, Biard l et al. Infliximab versus Adalimumab in the treatment of refractory inflammatory uveitis : a multicenter study from the French Uveitis Network. Arthritis Rheumatol, NJ, 2016;68 :1522-1530.
Les principaux résultats, obtenus sur la population en intention de traiter, sont les suivants :
� Le rapport des risques instantanés (RRI) du temps écoulé avant l’échec du traitement à l’adalimumab par rapport au placebo est de 0,25 (intervalle de confiance à 95 % [IC 95 %] :0,12 à 0,49); p < 0,0001).
� Le traitement a échoué chez 27 % des patients recevant l’adalimumab, comparativement à 60 % des patients recevant le placebo (risque relatif : 0,40 [IC 95 % = 0,22 à 0,73]; p = 0,002).
� Parmi les patients qui recevaient des corticostéroïdes topiques à l’inclusion, 47 % de ceux du groupe adalimumab et 16 % de ceux du groupe placebo les ont cessés (RRI : 3,58 [IC 95 % : 1,24 à 10,32], p = 0,02).
Les résultats démontrent que l’adalimumab est plus efficace que le placebo pour réduire le risque d’échec du traitement défini par l’un des éléments du critère composé. Ces bénéfices sont considérés comme cliniquement significatifs. De plus, parmi les patients qui recevaient des corticostéroïdes topiques à l’inclusion, la proportion de ceux les ayant cessés est plus élevée dans le groupe adalimumab que dans le groupe placebo. Bien qu’il s’agisse de résultats exploratoires, ces résultats sont pertinents, puisque l’arrêt des corticostéroïdes est un objectif de traitement en pratique clinique.
10. Schaap-Fogler M, Amer R, Friling r et al. Anti- TNF-α agents for refractory cystoid macular edema associated with noninfectious uveitis. Graefes Arch Clin Exp Ophthalmol, 2014;252 :633-640.
11. Mercier AE, Ribeiro E, Korobelnik JF et al. Efficacy of anti-TNF-alpha therapy for the treatment of non-infectious uveitis : a retrospective study of 21 patients. Ocul : 1-8 [epub ahead of print] Immunol Inflamm, 2016.
12. https ://fr.wikipedia.org/wiki/Adalimumab :
13. https ://www.newswire.ca/fr/news-releases/ humira-r-adalimumab-un-medicament-d-abbvieest-homologue-par-sante-canada-pour-letraitement-de-l-uveite-anterieure-non-infectieusechronique-chez-les-enfants-867774729.html
14. Feurer E, Bielefeld P, Saadoun D, Sève P. Uvéites et biothérapies [Biologics in uveitis]. Rev Med Interne. 2015 Feb;36(2) :107-16. French. doi : 10.1016/j. revmed.2014.07.008. Epub 2014 Sep 16. PMID : 25239400.
15. https ://www.vidal.fr/actualites/21740-humira-40-mg0-4-ml-adalimumab-desormais-remboursable-dansl-uveite-non-infectieuse-intermediaire-posterieure-etla-panuveite.html
16. https ://www.apmnews.com/freestory/10/338420/ladalimumab-superieur-a-l-infliximab-dans-l-uveite-duea-la-maladie-de-behcet
17. https ://www.inesss.qc.ca/thematiques/medicaments/ medicaments-evaluation-aux-fins-dinscription/extraitdavis-au-ministre/hulio-6158.html
18. https ://www.inesss.qc.ca/fileadmin/doc/INESSS/ Inscription_medicaments/Avis_au_ministre/Juillet_2022/ Hyrimoz_2022_06.pdf
24 OPTOMÉTRISTE | MAI | JUIN 2023
Révolutionnezvotrepratique!
Leeye-light® permetletraitementdemanièreefficaceetnon invasived’unegrandevariétédemaladiesdelasurface oculaire,notammentlasécheresseoculaire,ladysfonctiondes glandesdeMeibomiusetlablépharite.

EncombinantlestechnologiesIPLetLLLT,on réduitl'inflammation,tuelesbactérieset favoriselaréparationdestissus.


Leeye-light® estefficace,facileà utiliseretconvivialpourlespatients.

Communiquez avecnouspouren savoirplus

www.axismedical.ca
Les nouveaux produits ophtalmiques topiques pour le segment antérieur

Les récents développements thérapeutiques ophtalmiques qui ont fait la une des journaux dans le traitement des affections oculaires du segment postérieur ont éclipsé les nombreux développements thérapeutiques utilisant des agents ophtalmiques administrés par voie topique dans le traitement des affections du segment antérieur. Les agents ophtalmiques administrés par voie topique en phase finale de développement et ceux qui font l’objet d’une évaluation réglementaire sont véritablement innovants et se concentrent sur les premières indications de leur catégorie et sur les progrès en matière d’administration de médicaments.

Voici un aperçu des données cliniques pertinentes qui, dans l’attente de l’évaluation réglementaire et de l’autorisation de mise en marché, éclaireront notre utilisation dans le monde réel des agents thérapeutiques très attendus en cours de développement pour le traitement des affections du segment antérieur.
Inflammation et sécheresse oculaire
La régulation de l’inflammation au niveau de la surface oculaire, un facteur central de la sécheresse oculaire, peut être traitée par l’utilisation à long terme d’agents immunomodulateurs ophtalmiques topiques ayant des propriétés anti-inflammatoires1 L’identification de nouvelles cibles thérapeutiques jouant un rôle important dans la cascade inflammatoire a conduit à un groupe croissant de médicaments en phase finale d’investigation pour traiter la sécheresse oculaire ainsi que la conjonctivite allergique et l’uvéite antérieure aigüe.
26 OPTOMÉTRISTE | MAI | JUIN 2023
ARTICLE 3
PAR LE DOCTEUR JEAN-PIERRE LAGACÉ OPTOMÉTRISTE, M.Sc.
Reproxalap
Le reproxalap (Aldeyra Therapeutics) est un modulateur des espèces aldéhydes réactives (RASP) en cours d'évaluation pour le traitement de la sécheresse oculaire et de la conjonctivite allergique, ainsi que pour des applications anti-inflammatoires systémiques.2 La modulation des RASP réduit l'inflammation en diminuant la libération de cytokines et l'activité de l'inflammasome3,4
Identifiant ClinicalTrials.gov : NCT03404115
Étude clinique multicentrique, randomisée, à double masque, en groupes parallèles, contrôlée par véhicule, visant à évaluer l’innocuité et l’efficacité de la solution ophtalmique reproxalap chez des sujets atteints de sécheresse oculaire
Résumé : Étude clinique multicentrique de phase 2b, randomisée, à double masque, en groupes parallèles, contrôlée par véhicule, visant à évaluer l’innocuité et l’efficacité du collyre reproxalap (0,25 % et 0,1 %) par rapport au véhicule chez des sujets souffrant de sécheresse oculaire5
300 participants
Titre officiel : Étude clinique multicentrique de phase 2b, randomisée, à double masque, en groupes parallèles, contrôlée par véhicule, visant à évaluer l’innocuité et l’efficacité de la solution ophtalmique reproxalap (0,25 % et 0,1 %) par rapport à un véhicule chez des sujets atteints de sécheresse oculaire.
Date réelle du début de l’étude : 2 janvier 2018
Date réelle de fin de l’étude primaire : 11 juillet 2018
Date réelle de l’achèvement de l’étude : 11 juillet 2018
Identifiant ClinicalTrials.gov : NCT05424549
Essai clinique visant à évaluer l’innocuité et l’efficacité du reproxalap chez les adultes atteints de sécheresse oculaire
Résumé : Essai clinique croisé randomisé, en double aveugle, contrôlé par véhicule, visant à évaluer l’efficacité et l’innocuité de la solution ophtalmique reproxalap 0,25 % par rapport au véhicule chez des sujets atteints de sécheresse oculaire6
63 participants
Titre officiel : Un essai clinique croisé randomisé, à double insu et contrôlé par véhicule pour évaluer l’efficacité et l’innocuité de la solution ophtalmique reproxalap à 0,25 % par rapport au véhicule chez des sujets atteints de sécheresse oculaire.
Date réelle de début de l’étude : 9 mars 2022
Date réelle d’achèvement de l’étude primaire : 9 mai 2022
Date réelle d’achèvement de l’étude : 9 mai 2022
Essai clinique de phase 2b sur la sécheresse oculaire, multicentrique, randomisé, en double aveugle, en groupes parallèles et contrôlé par véhicule, visant à évaluer l’innocuité et l’efficacité du reproxalap topique oculaire, un nouvel inhibiteur de RASP
Objet : Le reproxalap, un nouvel agent séquestrant les espèces aldéhydes réactives (RASP), représente une nouvelle classe de médicaments anti-inflammatoires en phase avancée de développement pour le traitement de la sécheresse oculaire, ainsi que de l’uvéite antérieure non infectieuse et de la conjonctivite allergique. Un essai clinique contrôlé de phase 2b a été mené pour confirmer le critère d’évaluation et la sélection de la dose pour un programme de phase 3 sur la sécheresse oculaire7
Méthodes : Dans le cadre d’un essai multicentrique, randomisé, en double aveugle, en groupes parallèles et contrôlé par véhicule, portant sur la solution ophtalmique de reproxalap (0,25 % et 0,1 %), 300 sujets atteints de sécheresse oculaire ont été randomisés (1 :1 :1) pour recevoir soit du reproxalap (0,25 %), soit du reproxalap (0,1 %), soit la solution ophtalmique du véhicule, de façon bilatérale, quatre fois par jour (QID), pendant 12 semaines. Les symptômes et les signes de la dermatite atopique ont été évalués au début de l’étude, puis après 2, 4, 8 et 12 semaines de traitement.
Résultats : Les deux groupes reproxalap ont montré une activité jusqu’à la semaine 12. Le groupe reproxalap 0,25 % s’est révélé statistiquement supérieur au groupe véhicule en ce qui concerne l’amélioration par rapport à l’état initial de la gêne oculaire globale (p < 0,05), de la sécheresse (p < 0,05) et des picotements (p < 0,05), mesurés par le questionnaire Ora Calibra® Ocular Discomfort and 4 Symptom (OD4SQ). Chez les sujets dont les scores initiaux des symptômes de sécheresse étaient égaux ou supérieurs à la médiane, l’amélioration dans le groupe 0,25 % était statistiquement supérieure à celle du véhicule aux semaines 2 et 12.
Des différences statistiquement significatives de changement par rapport à la ligne de base en faveur du reproxalap 0,1 % par rapport au véhicule ont été observées dans la coloration de la région nasale à la fluorescéine à la semaine 12, et avec le reproxalap 0,25 % par rapport au véhicule à la semaine 8, comme mesuré par l’échelle Ora Calibra® Corneal and Conjunctival Staining Scale. L’amélioration dans le groupe 0,25 % était statistiquement supérieure à celle du groupe véhicule aux semaines 2, 8 et 12 chez les patients dont les scores de coloration de la région nasale à la fluorescéine étaient égaux ou supérieurs à la médiane. Les analyses des répondeurs par équation d’estimation généralisée ont démontré la supériorité statistique du reproxalap 0,25 % par rapport au véhicule dès la semaine 2. Dans la plupart des analyses, une relation dose-réponse a été observée.
Conclusions : Le reproxalap, un inhibiteur de RASP au mécanisme novateur, s’est avéré statistiquement supérieur à l’excipient pour de multiples symptômes et signes de la dermatite atopique. Conformément à un essai clinique antérieur de phase 2a, des améliorations des symptômes et des signes ont été observés dès deux semaines de traitement. Le reproxalap 0,25 % fera l’objet d’un programme de phase 3 pour le traitement de la dermatite atopique.
27 OPTOMÉTRISTE | MAI | JUIN 2023
Le reproxalap améliore les signes et symptômes de la conjonctivite allergique dans une chambre d’allergènes : Un modèle réel d’exposition aux allergènes
Objectif : Évaluer l’activité prophylactique et thérapeutique du reproxalap, un nouvel inhibiteur des espèces aldéhydes réactives, dans un modèle réel d’exposition aux allergènes8
Méthodes : Dans le cadre d’un essai de phase 2 randomisé, en double aveugle, contrôlé par véhicule et croisé, 70 patients adultes ayant des antécédents de conjonctivite allergique modérée à sévère depuis ≥2 ans, un test cutané positif au pollen d’ambroisie et des scores de démangeaisons et de rougeurs oculaires induites par la chambre à allergènes respectivement de ≥2,5 et de ≥2 (les deux échelles vont de 0 à 4) ont été randomisés 1 :1 :1 dans l’une des trois séquences suivantes : 0,25 % de reproxalap, 0,5 % de reproxalap et placebo; 0,5 % de reproxalap, placebo et 0,25 % de reproxalap; ou placebo, 0,25 % de reproxalap et 0,5 % de reproxalap. Les symptômes et la rougeur conjonctivale ont été évalués pendant 3,5 heures dans une chambre d’allergènes contenant du pollen d’ambroisie en aérosol (3 500 grains/m3). L’article testé a été administré bilatéralement juste avant l’entrée dans la chambre et 90 minutes après l’entrée dans la chambre.
Résultats : Reproxalap a été sûr et bien toléré; 66 des 70 patients inscrits ont participé à toutes les visites. Par rapport au véhicule, les deux concentrations de reproxalap ont montré des améliorations statistiquement significatives et cliniquement pertinentes des démangeaisons oculaires, du larmoiement et de la rougeur pendant la durée de l’exposition dans la chambre (P < 0,001 pour toutes les évaluations). L’activité prophylactique et thérapeutique du médicament a été démontrée.
Conclusion : Dans une chambre d’allergènes, le reproxalap, un nouvel inhibiteur des espèces d’aldéhydes réactives, s’est avéré statistiquement supérieur au véhicule en ce qui concerne les symptômes et signes typiques de la conjonctivite allergique. Ces données font partie des premiers résultats cliniques rigoureux démontrant l’amélioration du médicament dans la conjonctivite allergique dans une chambre d’allergènes, un modèle réel d’exposition aux allergènes.
Essai de phase 2a randomisé en double aveugle pour évaluer l’activité et la sécurité du reproxalap topique oculaire, un nouvel inhibiteur de RASP, dans la maladie de l’œil sec.
Objectif : Déterminer si le reproxalap, un nouvel inhibiteur des espèces aldéhydes réactives (RASP), est sûr et efficace pour le traitement des signes et symptômes de la sécheresse oculaire9
Méthodes : Dans le cadre d’un essai de phase 2a randomisé en double aveugle et en groupes parallèles portant sur 3 formulations topiques de reproxalap oculaire (solution ophtalmique à 0,1 %, solution ophtalmique à 0,5 % et solution ophtalmique lipidique à 0,5 %), 51 patients souffrant de sécheresse oculaire ont été répartis de manière aléatoire dans une proportion de 1 :1 :1 sur un seul site aux États-Unis. Les yeux ont été traités bilatéralement 4 fois par jour pendant 28 jours et les signes et symptômes standards de la dermatite atopique ont été évalués au départ et après 7 et 28 jours de traitement.
Les niveaux de RASP dans les larmes ont été évalués au départ et au 28e jour.
Résultats : L’effet du traitement sur les signes et les symptômes de la sécheresse oculaire était similaire dans tous les groupes de traitement, et les données regroupées de la période de traitement de 28 jours ont montré une amélioration significative par rapport à la ligne de base du score de l’évaluation des symptômes de la sécheresse oculaire (P = 0,003), du score sur l’échelle d’inconfort oculaire (P < 0,0001), du score global sur l’échelle d’inconfort oculaire et le questionnaire des 4 symptômes (P = 0,0004), du test de Schirmer (P = 0,008), de l’osmolarité des larmes (P = 0,003) et du score de coloration totale au vert de lissamine (P = 0,002). L’amélioration des symptômes de la dermatite atopique était évidente au bout d’une semaine de traitement, et les tailles d’effet approchaient ou dépassaient généralement 0,5. Aucune modification significative des mesures de sécurité n’a été observée.
Conclusion : Les résultats suggèrent que le reproxalap, nouvel inhibiteur de RASP, a le potentiel d’atténuer les signes et les symptômes de la dermatite atopique et peut représenter une nouvelle approche thérapeutique rapide et largement active pour la dermatite atopique (NCT03162783).
Activité cliniquement pertinente du nouvel inhibiteur de RASP reproxalap dans la conjonctivite allergique : l’essai de phase 3 ALLEVIATE
Objectif : Évaluer l’activité post-aigüe et l’utilité clinique du reproxalap, un nouvel inhibiteur des espèces aldéhydes réactives (RASP), par rapport au véhicule chez des patients atteints de conjonctivite allergique saisonnière10 Conception : Essai de phase 3 randomisé, en double aveugle, en groupes parallèles.
Méthodes : Deux concentrations topiques oculaires de reproxalap (0,25 % et 0,5 %) ont été évaluées par rapport au véhicule chez des patients atteints de conjonctivite allergique, randomisés 1 :1 :1 et traités avec l’article testé 10 minutes avant la provocation conjonctivale par l’allergène saisonnier. Le critère d’évaluation principal était l’aire sous la courbe du score de démangeaison oculaire post-aigüe (intervalle = 0-4) de 10 à 60 minutes après la provocation. Le principal critère d’évaluation secondaire était la proportion de sujets présentant une amélioration de ≥2 points par rapport à leur score de démangeaison oculaire maximale au départ.
Résultats : Au total, 318 patients ont été randomisés dans 11 sites américains. Les deux concentrations de reproxalap (0,25 % et 0,5 %) ont atteint le critère d’évaluation principal (P < 0,0001 et P = 0,003, respectivement) et le critère d’évaluation secondaire clé (P = 0,0005 et P = 0,02, respectivement). Le temps nécessaire à la disparition complète des démangeaisons oculaires était statistiquement plus rapide pour les deux concentrations de reproxalap que pour le véhicule (P < 0,0001 et P = 0,001, respectivement). Aucun problème de sécurité ou de tolérabilité n’a été relevé. L’effet indésirable le plus fréquent était une irritation légère et transitoire du site d’instillation.
28 OPTOMÉTRISTE | MAI | JUIN 2023
Conclusion : Le reproxalap a été efficace pour réduire les démangeaisons oculaires chez les patients atteints de conjonctivite allergique. L’activité de reproxalap était cliniquement pertinente, telle qu’évaluée par les analyses basées sur les répondeurs et les analyses de distribution. ALLEVIATE représente l’un des premiers essais de phase 3 sur la conjonctivite allergique portant sur un nouveau mécanisme d’action depuis des décennies et est unique parmi les essais de provocation allergénique conjonctivale en évaluant la pertinence clinique à l’aide de techniques standards et validées.
Apparition précoce et large activité du reproxalap dans un essai de phase 2b randomisé, en double aveugle, contrôlé par véhicule, dans la maladie de l’œil sec
Objectif : Évaluer l’activité du reproxalap, un nouvel inhibiteur des espèces aldéhydes réactives (RASP), par rapport au véhicule chez des patients souffrant de sécheresse oculaire.
Plan : Essai de phase 2b randomisé, en double aveugle, contrôlé par véhicule.
Méthodes : Trois cents patients souffrant de sécheresse oculaire ont été répartis au hasard 1 :1 :1 sur plusieurs sites aux États-Unis pour recevoir 0,1 % de reproxalap topique oculaire, 0,25 % de reproxalap topique oculaire ou le véhicule. Les yeux ont été traités bilatéralement 4 fois par jour pendant 12 semaines. Les signes et symptômes standards de la dermatite atopique ont été évalués au début de l’étude et aux semaines 2, 4, 8 et 12.11
Résultats : Une réponse à la dose a été observée pour les signes et les symptômes de la dermatite atopique. Par rapport au véhicule sur 12 semaines de traitement, l’amélioration symptomatique la plus importante a été observée au niveau de la sécheresse oculaire (0,25 %, P = 0,047), et l’amélioration du signe objectif la plus importante a été observée au niveau de la coloration à la fluorescéine de la région nasale (0,25 %, P = 0,030). Une plus grande proportion de patients recevant 0,25 % de reproxalap par rapport au véhicule a rapporté des scores de sécheresse de 0 (P = 0,012). L’amélioration des symptômes combinés de la dermatite atopique était évidente dès la première visite après la ligne de base (semaine 2, 0,25 %, P < 0,0001) chez les patients dont les scores de base étaient supérieurs ou égaux aux valeurs médianes. Aucune modification significative des mesures de sécurité n’a été observée.
Conclusion : Le reproxalap, nouvel inhibiteur de RASP, a démontré un contrôle symptomatique rapide, large et cliniquement pertinent, conjointement à une amélioration statistiquement significative par rapport à l’excipient des signes de la dermatite atopique tel que démontré par la coloration à la fluorescéine, chez les patients atteints de dermatite atopique sur une période de 12 semaines de traitement. Ces résultats constituent la première preuve contrôlée par véhicule du potentiel thérapeutique de l’inhibition de RASP pour atténuer les signes et les symptômes de la sécheresse oculaire.
Essai randomisé de phase 2 du reproxalap, nouvel inhibiteur des espèces réactives d’aldéhyde, chez des patients atteints d’uvéite antérieure non infectieuse : modèle de remplacement des corticostéroïdes
Objectif : Les corticostéroïdes topiques utilisés pour traiter l’inflammation oculaire sont associés à un risque élevé de toxicités cliniquement significatives. C’est pourquoi il est nécessaire d’avoir recours à des médicaments épargnant les corticostéroïdes pour traiter l’inflammation oculaire. L’uvéite antérieure non infectieuse (UAN) est une affection inflammatoire oculaire qui menace la vue et qui est généralement traitée par des corticostéroïdes topiques. Cet essai comparatif contrôlé par corticostéroïdes examine la sécurité et l’efficacité du reproxalap, un nouvel inhibiteur des espèces aldéhydes réactives (RASP), pour le traitement de l’inflammation oculaire, en utilisant l’UVA comme modèle12
Méthodes : Quarante-cinq patients souffrant d’une UAN aigüe légère à modérée ont été randomisés 1 :1 :1 pour recevoir du reproxalap 0,5 % en solution ophtalmique (4 fois par jour pendant 6 semaines), de la prednisolone
1 % en solution ophtalmique (Pred Forte®, 4 fois par jour en diminution progressive pendant 6 semaines), ou une combinaison de reproxalap 0,5 % en solution ophtalmique (4 fois par jour pendant 6 semaines) et de prednisolone 1 % en solution ophtalmique (2 fois par jour en diminution progressive pendant 6 semaines).
Résultats : Tous les traitements ont amélioré le nombre et le grade des cellules antérieures et aucune différence n’a été observée entre les groupes en ce qui concerne le changement par rapport à la ligne de base. La monothérapie par reproxalap et la thérapie combinée étaient statistiquement non inférieures à la prednisolone. La proportion de patients nécessitant un traitement de secours était comparable entre les groupes de traitement. Aucun problème de sécurité n’a été identifié chez les patients traités par reproxalap, alors que le traitement par prednisolone a entraîné une augmentation moyenne de la pression intraoculaire de 2 mm Hg.
Conclusions : Le reproxalap peut être une alternative sûre et efficace aux corticostéroïdes topiques pour les patients atteints d’UAN et d’autres formes d’inflammation oculaire. Ces résultats représentent une première preuve clinique de l’importance des RASP dans l’inflammation oculaire et de l’applicabilité de l’inhibition des RASP à la modulation immunitaire dans les maladies oculaires. Essai clinique (NCT02406209).
Une nouvelle demande de médicament (NDA) est en cours d’évaluation par la FDA pour le reproxalap dans le traitement des signes et symptômes de la sécheresse oculaire2. La demande est étayée par les données de 5 essais cliniques, qui comprennent l’évaluation d’environ 2 000 patients2,5,12. Une variété de critères d’évaluation primaires et secondaires subjectifs et objectifs ont été utilisés tout au long des essais de phase 2 et 3, notamment la réduction des niveaux de RASP présents dans les larmes, les mesures du score de Schirmer, la rougeur conjonctivale, les symptômes de la sécheresse oculaire et la coloration à la fluorescéine2,12,15
29 OPTOMÉTRISTE | MAI | JUIN 2023
Bien que l’essai TRANQUILITY de phase 2/3 (NCT04674358) n’ait pas atteint le critère d’évaluation primaire préspécifié lié à la rougeur conjonctivale, il a atteint un critère d’évaluation objectif lié au test de Schirmer, qui a servi de base à l’essai TRANQUILITY 2 de phase 3 (NCT05062330). TRANQUILITY 2 a inclus 361 participants auxquels le collyre reproxalap (0,25 %) a été administré 7 fois sur 2 jours consécutifs avant l’exposition à une chambre de sécheresse oculaire à faible humidité pendant 90 minutes. Les principaux critères d’évaluation évalués et satisfaits étaient le changement moyen du test de Schirmer par rapport à l’état initial et le changement supérieur ou égal à 10 mm du test de Schirmer par rapport à l’état initial, ainsi qu’un critère d’évaluation secondaire, la rougeur conjonctivale12,14
Identifiant ClinicalTrials.gov : NCT04674358
L’essai TRANQUILITY : Essai clinique visant à évaluer l’efficacité et l’innocuité chez des sujets atteints de sécheresse oculaire16
Résumé : L’essai TRANQUILITY : Essai clinique multicentrique de phase 2/3, randomisé, en double aveugle, contrôlé par véhicule, visant à évaluer l’efficacité et l’innocuité de la solution ophtalmique reproxalap 0,25 % par rapport au véhicule chez des sujets souffrant de sécheresse oculaire.
331 participants
Titre officiel : L’essai TRANQUILITY : Essai clinique multicentrique de phase 2/3 randomisé, en double aveugle, de conception parallèle et contrôlé par véhicule pour évaluer l’efficacité et l’innocuité de la solution ophtalmique reproxalap 0,25 % par rapport à un véhicule chez des sujets atteints de sécheresse oculaire.
Date réelle de début de l’étude : 21 novembre 2020
Date réelle de fin de l’étude primaire : 12 septembre 2021
Date réelle d’achèvement de l’étude : 12 septembre 2021
Identifiant ClinicalTrials.gov : NCT05062330
L’essai TRANQUILITY 2 : Essai clinique de phase 3 visant à évaluer l’efficacité et l’innocuité chez des sujets atteints de sécheresse oculaire
Résumé : L’essai TRANQUILITY 2 : Essai clinique de phase 3 multicentrique, randomisé, en double aveugle, contrôlé par véhicule, visant à évaluer l’efficacité et l’innocuité de la solution ophtalmique reproxalap 0,25 % par rapport au véhicule chez des sujets souffrant de sécheresse oculaire17
361 participants
Titre officiel : L’essai TRANQUILITY 2 : Essai clinique de phase 3 multicentrique, randomisé, en double aveugle, de conception parallèle, contrôlé par véhicule, visant à évaluer l’efficacité et l’innocuité de la solution ophtalmique reproxalap 0,25 % par rapport à un véhicule chez des sujets atteints de sécheresse oculaire.
Date réelle de début de l’étude : 28 août 2021
Date réelle de fin de l’étude primaire : 4 mars 2022
Date réelle d’achèvement de l’étude : 4 mars 2022
Bien qu’il puisse être fastidieux d’examiner les données d’efficacité liées à différents points finaux dans de nombreux essais, la conception des études TRANQUILITY et TRANQUILITY 2 est potentiellement pertinente d’un point de vue clinique. L’administration fréquente (7 fois/ jour) de reproxalap avec des critères d’évaluation évalués au jour 2 permet de comprendre l’action rapide de l’agent, démontrée par une amélioration objective rapide4,12 Les effets indésirables ont été fréquents dans l’essai de phase 2b (NCT03404115/2018), mais légers dans l’ensemble15. Au total, 93 % des 100 patients traités par reproxalap 0,25 % ont signalé une gêne lors de l’instillation, et 92,4 % de tous les cas ont présenté des EI oculaires considérés comme légers8. Sur la base des EI oculaires décrits, si reproxalap 0,25 % doit être approuvé et mis sur le marché, une attention particulière à la sélection des patients ainsi qu’un conseil approfondi, y compris une compréhension claire des attentes des patients, seront essentiels à l’observance.
Aldeyra Therapeutics annonce des résultats positifs de l’essai clinique de phase 2 de reproxalap, un nouveau médicament expérimental, comparé à Xiidra®, dans le cadre de l’étude Dry Eye Chamber
� Reproxalap est statistiquement inférieur à Xiidra pour les deux critères d’évaluation de l’essai : inconfort oculaire (p = 0,002) et démangeaisons oculaires (p = 0,01).
� Résultats conformes aux données de la comparaison de la tolérance oculaire post-aigüe de reproxalap et de Xiidra chez les patients souffrant de sécheresse oculaire.
Aldeyra, une société de biotechnologie qui fait de la recherche pour mettre au point des thérapies innovantes pour le traitement des maladies à médiation immunitaire, a annoncé aujourd’hui les résultats positifs d’un essai clinique de phase 2 comparant les scores d’inconfort oculaire et de démangeaisons de reproxalap solution ophtalmique 0,25 % (reproxalap), un nouveau médicament expérimental, à ceux de Xiidra® (lifitegrast solution ophtalmique 5 %) chez des patients souffrant de sécheresse oculaire. La gêne oculaire (p = 0,002) et les démangeaisons (p = 0,01) rapportées par les patients étaient statistiquement plus faibles avec reproxalap qu’avec Xiidra18
Aldeyra Therapeutics, inc. a annoncé les résultats positifs d’un essai clinique de phase 2 comparant les scores de gêne oculaire et de démangeaisons du reproxalap en solution ophtalmique 0,25 % (reproxalap), un nouveau médicament expérimental, à ceux du Xiidra® (lifitegrast en solution ophtalmique 5 %) chez des patients souffrant de sécheresse oculaire. L’inconfort oculaire (p = 0,002) et les démangeaisons (p = 0,01) rapportés par les patients étaient statistiquement plus faibles avec reproxalap qu’avec Xiidra®
« L’amélioration statistiquement significative des symptômes observée dans cet essai avec le reproxalap par rapport au Xiidra renforce les données d’un essai clinique antérieur démontrant les avantages en ce qui a trait à la tolérance du reproxalap par rapport au Xiidra chez les patients souffrant de sécheresse oculaire, a déclaré Todd C. Brady, M.D., Ph. D., président et directeur général d’Aldeyra.
30 OPTOMÉTRISTE | MAI | JUIN 2023
La combinaison d’une activité rapide et d’une meilleure tolérabilité mise en évidence par le reproxalap dans les essais cliniques a le potentiel de résoudre les problèmes importants d’observance du traitement actuellement disponible, dont les taux médians d’arrêt sont d’environ un mois »2
« La réduction cliniquement pertinente et statistiquement significative de l’activité symptomatique suggère que le reproxalap, s’il est approuvé, a le potentiel de devenir un traitement de première ligne pour la sécheresse oculaire, a déclaré Peter Couroux, M.D., directeur médical en chef mondial pour Cliantha Research et chercheur principal de l’essai clinique. En tant que premier modulateur de RASP développé pour les maladies de la surface oculaire, reproxalap représente un nouveau mécanisme d’action qui pourrait élargir les options thérapeutiques disponibles pour les patients souffrant de sécheresse oculaire. »
L’essai clinique de phase 2, doublement masqué, croisé, monocentrique, mené auprès de 56 patients atteints de sécheresse oculaire, a évalué l’activité de reproxalap par rapport à Xiidra pour deux critères d’évaluation : le score des symptômes d’inconfort oculaire et le score des symptômes de démangeaisons oculaires. Une dose unique de l’article testé a été administrée dans les deux yeux environ 5 minutes avant une exposition de 45 minutes dans une chambre de sécheresse oculaire, au cours de laquelle l’humidité a été maintenue à de faibles niveaux dans un environnement où le débit d’air, la température et les tâches visuelles étaient régulés. Les symptômes ont été évalués environ 15 minutes avant l’entrée dans la chambre et toutes les 5 minutes à partir de l’entrée dans la chambre.
Aucun signal de sécurité n’a été observé au cours de l’essai et il n’y a pas eu d’arrêt de traitement ni d’effets indésirables modérés ou graves liés au médicament. L’événement indésirable le plus fréquent dans les deux groupes de traitement était une légère gêne au niveau du site d’instillation. reproxalap a maintenant été évalué chez plus de 1 500 patients. Le schéma posologique commercial approuvé de Xiidra et le schéma posologique commercial prévu de reproxalap comprennent l’administration répétée du médicament.
Aldeyra prévoit présenter
Lors de l’évaluation des données d’efficacité et de tolérabilité, l’impact des ingrédients inactifs d’un traitement est souvent sous-estimé. Bien que l’efficacité des produits ophtalmiques à base de cyclosporine soit bien établie en ce qui concerne la réduction de l’inflammation associée à la sécheresse oculaire, un traitement expérimental à base de cyclosporine utilise un véhicule alternatif qui peut avoir un impact sur son efficacité et sa tolérabilité.
Identifiant ClinicalTrials.gov : NCT05102409
Essai clinique exploratoire visant à évaluer l’innocuité et la tolérabilité chez des sujets atteints de sécheresse oculaire
Résumé : Essai clinique exploratoire, unicentrique, croisé et à double insu visant à évaluer l’innocuité et la tolérabilité de la solution ophtalmique reproxalap 0,25 % par rapport à Xiidra® chez des sujets atteints de la maladie de l’œil sec dans une chambre de sécheresse oculaire19
56 participants
Titre officiel : Un essai clinique exploratoire, unicentrique, croisé et à double masque pour évaluer l’innocuité et la tolérabilité de la solution ophtalmique reproxalap à 0,25 % par rapport à Xiidra® chez des sujets souffrant de sécheresse oculaire dans une chambre de sécheresse oculaire.
Date réelle de début de l’étude : 9 septembre 2021
Date réelle d’achèvement de l’étude primaire : 25 octobre 2021
Date réelle d’achèvement de l’étude : 25 octobre 2021
CyclASol
CyclASol (Novaliq), 0,1 % de cyclosporine A dans EyeSol20, fait actuellement l’objet d’une évaluation par la FDA, avec une date PDUFA (Prescription Drug User Fee Act) fixée au 8 juin 2023. EyeSol est une technologie sans eau qui augmente le temps de contact avec la surface oculaire afin d’accroître la biodisponibilité et qui, en raison de la faible tension superficielle, permet de réduire la taille des gouttes par rapport aux produits à base d’eau21 Dans l’étude ESSENCE-1 de phase 2b/3 (NCT03292809), des patients atteints de sécheresse oculaire à prédominance aqueuse ne répondant pas aux larmes artificielles ont reçu CyclaSol 0,1 % deux fois par jour, les critères d’efficacité principaux étant la coloration à la fluorescéine cornéenne et l’amélioration des symptômes à l’aide du questionnaire OSDI (Ocular Surface Disease Index), évalués à la semaine 422
Bien que le critère d’évaluation primaire objectif d’amélioration de la surface de base de la coloration moyenne totale à la fluorescéine cornéenne ait été atteint par rapport au groupe véhicule, les deux groupes ont montré une amélioration statistiquement significative du score OSDI sans différence statistiquement significative entre le groupe véhicule et le groupe traitement (P = 0,2634)22
Bien qu’aucun EI grave lié au traitement n’ait été relevé, 7 personnes du groupe traité ont interrompu l’essai et les 3 personnes du groupe traité par le véhicule ont interrompu l’essai11. Les raisons invoquées pour l’interruption dans le groupe traité sont le « choix du patient » dans 3 cas, des événements indésirables (sensation de corps étranger et œdème de la paupière) dans 2 cas, et des raisons administratives dans 2 cas22. Les EI oculaires les plus fréquents ont été la baisse de l’acuité visuelle (3,1 % dans le groupe traité contre 1,8 % dans le groupe véhicule), la douleur au site d’instillation (2,5 % contre 1,2 %, respectivement) et la vision floue (1,2 % contre 2,4 %, respectivement)22
31 OPTOMÉTRISTE | MAI | JUIN 2023
les données de l’essai lors d’une prochaine réunion médicale.
Les résultats préliminaires d’ESSENCE-2 étaient cohérents avec les résultats d’ESSENCE-1, avec une amélioration objective par rapport au placebo de la coloration à la fluorescéine cornéenne et une amélioration des symptômes par rapport à la ligne de base, et comparables à l’amélioration observée dans le groupe traité par le véhicule23
Les agents anti-inflammatoires épargnant les stéroïdes, y compris les agents biologiques, sont un pilier de l’immunomodulation systémique actuelle. En raison de leur complexité moléculaire et de leur poids moléculaire élevé, les anticorps monoclonaux entiers, y compris les inhibiteurs du TNF-α disponibles dans le commerce, bien qu’efficaces lorsqu’ils sont administrés par voie intraveineuse ou sous-cutanée, ne devraient pas pénétrer dans la cornée pour atteindre des niveaux thérapeutiques s’ils pouvaient être composés dans une préparation ophtalmique.
Licaminlimab
Récemment, le licaminlimab (Oculis), un fragment d’anticorps à chaîne unique, a été mis au point et, dans une étude pilote de phase 2 (NCT02482129), il a montré une réponse (définie comme une réduction de deux étapes par rapport à l’inflammation de la chambre antérieure) chez 56 % des personnes atteintes d’uvéite antérieure aiguë24. On a déterminé que tous les EI oculaires dans le groupe de traitement sont très probablement liés à la maladie sous-jacente plutôt qu’au traitement24. Les premiers résultats positifs justifient la poursuite de l’étude d’un agent biologique ophtalmique topique épargnant les stéroïdes24
Dysfonction des glandes de Meibomius
L’hygiène des paupières, les compléments alimentaires et les traitements basés sur des procédures ont constitué la base du traitement réussi du dysfonctionnement des glandes de Meibomius, avec des défis réels associés à l’adhésion et à l’accès aux thérapies.
NOV03
Premier traitement pharmaceutique potentiel des signes et symptômes de la sécheresse oculaire associée au dysfonctionnement des glandes de Meibomius, NOV03 (100 % perfluorohexyloctane [F6H8]; Bausch + Lomb, Novaliq) est un composé sans eau et sans conservateur en cours d’examen par la FDA, la date cible de la PDUFA étant fixée au 28 juin 202325
NOV03 empêche l’évaporation aqueuse et stabilise le film lacrymal grâce à son interaction avec la couche lipidique naturelle du film lacrymal15,26. NOV03 a été évalué dans l’essai de phase 2 SEECASE (NCT03333057) et dans les essais de phase 3 GOBI (NCT04139798) et MOJAVE (NCT04567329)25,28
Les critères d’évaluation primaires de la coloration totale de la cornée à la fluorescéine et de la sécheresse oculaire subjective sur l’échelle visuelle analogique au jour 57 ont été atteints dans l’essai MOJAVE avec une posologie de 4 fois par jour26
Les EI oculaires ont été similaires dans les groupes de traitement et de contrôle (9,6 % contre 9,7 %, respectivement), la blépharite étant l’EI oculaire le plus fréquemment signalé, soit chez 1,6 % des patients de l’étude contre 0,3 % des patients du groupe de contrôle26
Identifiant ClinicalTrials.gov : NCT04139798
Perfluorohexylcotane (NOV03) pour le traitement des signes et symptômes de la sécheresse oculaire associée à un dysfonctionnement des glandes de Meibomius (étude Gobi)
Résumé : Cet essai évaluera l’efficacité, l’innocuité et la tolérabilité de la solution ophtalmique NOV03 par rapport à une solution saline de contrôle pour le traitement des signes et symptômes de la sécheresse oculaire associée au dysfonctionnement des glandes de Meibomius.
599 participants
Titre officiel : Essai de phase 3, multicentrique, randomisé, en double aveugle, contrôlé par une solution saline pour évaluer l’effet de NOV03 (perfluorohexyloctane) sur les signes et symptômes de la sécheresse oculaire associée à un dysfonctionnement des glandes de Meibomius (étude Gobi).
Date réelle du début de l’étude : 20 juillet 2020
Date réelle d’achèvement de l’étude primaire : 12 mars 2021
Date réelle d’achèvement de l’étude : 12 mars 2021
Source : https ://clinicaltrials.gov/ct2/show/NCT04139798
Identifiant ClinicalTrials.gov : NCT04567329
Effet de NOV03 sur les signes et les symptômes de la sécheresse oculaire associée à un dysfonctionnement des glandes de Meibomius (étude Mojave)
Résumé : Les objectifs de cette étude sont d’évaluer l’efficacité, l’innocuité et la tolérabilité de la solution ophtalmique NOV03 par rapport à une solution saline pour le traitement des signes et des symptômes de la sécheresse oculaire associée au dysfonctionnement des glandes de Meibomius.
622 participants
Titre officiel : Essai de phase 3, multicentrique, randomisé, en double aveugle, contrôlé par une solution saline pour évaluer l’effet de NOV03 sur les signes et symptômes de la sécheresse oculaire associée au dysfonctionnement des glandes de Meibomius (étude Mojave).
Date réelle de début de l’étude : 18 novembre 2020
Date réelle d’achèvement de l’étude primaire : 30 août 2021
Date réelle d’achèvement de l’étude : 30 août 2021
Source : https ://clinicaltrials.gov/ct2/show/NCT04567329
32 OPTOMÉTRISTE | MAI | JUIN 2023
AZR-MD-001
L’AZR-MD-001 0,5 % (Azura Ophthalmics) est également à l’étude pour le traitement du dysfonctionnement des glandes de Meibomius; les résultats positifs d’un essai de phase 2b (NCT03652051) ont été récemment annoncés, ainsi que des plans pour procéder à un essai pivot de phase 3 en 202 329. L’AZR-MD-001 est une pommade ophtalmique à base de sulfure de sélénium qui perturbe l’hyperkératinisation qui se produit dans le dysfonctionnement des glandes de Meibomius en réduisant les liaisons disulfures29
Dans l’essai de phase 2b, l’AZR-MD-001 0,5 % a été appliqué sur la paupière inférieure au moment du coucher, les critères d’évaluation principaux étant une amélioration significative du nombre de glandes sécrétant du meibum et des améliorations significatives du score OSDI par rapport à la ligne de base29
Demodex blepharitis
TP-03
Reproduit du secteur vétérinaire, l’agent antiparasitaire formulé comme agent ophtalmique topique TP-03 (lotilaner solution ophtalmique 0,25 %; Tarsus Pharmaceuticals) a montré des résultats positifs dans son essai clinique pivot de phase 2b/3 SATURN-1 (NCT04475432) et l’essai de phase 3 SATURN-2 (NCT04784091) formant la base de la NDA acceptée en novembre 2022 avec une date PDUFA fixée au 25 août 202330
Identifiant ClinicalTrials.gov : NCT04784091
Essai visant à évaluer l’innocuité et l’efficacité du TP-03 pour le traitement de la blépharite à Demodex (Saturn-2)
Résumé : Le but de cette étude est de comparer l’innocuité et l’efficacité du TP-03, un collyre, à celles de son véhicule de contrôle pour le traitement de la blépharite due au Demodex, un acarien microscopique que l’on trouve fréquemment dans les follicules pileux humains.
Description détaillée : Cette étude de phase 3 est un essai randomisé, contrôlé, multicentrique, doublement masqué et parallèle visant à comparer l’innocuité et l’efficacité du TP-03 à celles du véhicule témoin pour le traitement de la blépharite à Demodex. L’objectif principal de l’étude est d’évaluer la sécurité et l’efficacité du TP-03, 0,25 % comparé à son véhicule du jour 1 au jour 43 chez des participants adultes atteints de blépharite à Demodex légère à sévère. Le critère principal d’efficacité sera la guérison basée sur les collerettes. La sécurité sera déterminée par l’évaluation des effets indésirables liés au traitement ainsi que par l’évaluation de tout changement dans l’acuité visuelle, la pression intraoculaire, la biomicroscopie à la lampe à fente, la densité des cellules endothéliales, l’hématologie, la chimie du sang et l’analyse d’urine.
412 participants
Titre officiel : Essai de phase 3 randomisé, contrôlé, multicentrique, doublement masqué, parallèle, visant à évaluer la sécurité et l’efficacité du TP-03 pour le traitement de la blépharite à Demodex.
Date réelle du début de l’étude : 29 avril 2021
Date réelle d’achèvement de l’étude primaire : 9 mai 2022
Date réelle d’achèvement de l’étude : 9 mai 2022
Source : https ://clinicaltrials.gov/ct2/show/NCT04784091
Dans l’étude SATURN-1, l’administration biquotidienne de lotilaner en solution ophtalmique à 0,25 % pendant 43 jours a montré une différence statistiquement significative dans la proportion de patients n’ayant pas plus de 2 collerettes sur la paupière supérieure par rapport au véhicule seul (81,3 % contre 23,0 %), dans la proportion de patients dont les acariens Demodex ont été éradiqués (44,0 % contre 7,4 %) et dans la proportion de sujets n’ayant pas plus de 2 collerettes et aucun érythème sur la paupière supérieure (13,9 % contre 1,0 %)31. 91,9 % des patients recevant le TP-03 ont déclaré que la goutte était « neutre à très confortable » à la fin de l’étude, sans différence statistiquement significative par rapport au groupe véhicule20,31. La douleur au site d’instillation a été l’EI oculaire le plus fréquemment rencontré dans 11,8 % du groupe d’étude et 7,7 % du groupe de contrôle. Dans l’ensemble, les EI oculaires étaient légers et ont été ressentis par 19,8 % du groupe d’étude et 21,5 % du groupe de contrôle31
Inversion de la mydriase Nyxol
Le développement de Nyxol (solution ophtalmique de phentolamine sans conservateur 0,75 %; Ocuphire Pharma) met en évidence et offre une solution potentielle aux problèmes visuels symptomatiques que rencontrent les patients après une dilatation pupillaire pharmacologique, quel que soit l’agent diagnostique utilisé pour la pigmentation de l’iris32. La phentolamine est un bloqueur α1 et α2 non sélectif qui agit pour détendre le muscle dilatateur de l’iris lorsqu’il est appliqué par voie topique32. La phentolamine est approuvée par la FDA et utilisée pour l’administration systémique dans le traitement du phéochromocytome et pour l’inversion de l’anesthésie orale.
La soumission de la NDA pour la solution ophtalmique de phentolamine à 0,75 % a été annoncée le 6 décembre 2022. La demande est étayée par les données de l’essai de phase 2b MIRA-1 (NCT04024891), des essais de phase 3 MIRA-2 (NCT04620213) et MIRA-3 (NCT05134974), et de l’essai de phase 3 MIRA-4 (NCT05223478) chez des patients pédiatriques âgés de 3 ans et plus32,34
33 OPTOMÉTRISTE | MAI | JUIN 2023
Dans les études MIRA-2 et MIRA-3, les yeux ont été dilatés avec 2,5 % de phényléphrine, 1 % de tropicamide ou 1 % d’hydroxyamphétamine et 0,25 % de tropicamide (Paremyd; Akorn). Une heure plus tard, 2 gouttes de phentolamine 0,75 % ou de placebo ont été instillées dans l’œil étudié et 1 goutte dans l’autre œil35. Le principal critère d’évaluation était le pourcentage d’yeux à l’étude dont le diamètre de la pupille était revenu à la valeur de base après 90 minutes. Les points finaux primaires ont été atteints dans les études MIRA-2 et MIRA-3.
Dans l’étude MIRA-3, 58 % des sujets ont retrouvé leur diamètre pupillaire initial (à 0,2 mm près) après 90 minutes, contre 6 % des sujets du groupe placebo33 Après 60 minutes, 42 % des yeux de l’étude ont retrouvé leur diamètre pupillaire initial (à 0,2 mm près), contre 2 % dans le groupe placebo. Aucun EI grave n’a été signalé. Une légère hyperémie conjonctivale transitoire a été observée chez 11 % des patients, aucun autre EI ne s’étant produit chez plus de 5 % des patients de l’étude33 Du point de vue de la pertinence clinique potentielle, la tolérance à la phentolamine 0,25 % semble bien étayée par les données de l’étude MIRA-3, où aucun patient ne s’est retiré de l’étude en raison d’EI33
Identifiant ClinicalTrials.gov : NCT05134974
Innocuité et efficacité de Nyxol (solution ophtalmique de phentolamine à 0,75 %) pour inverser la mydriase induite par la pharmacologie (MIRA-3)
Résumé : Les objectifs de cette étude sont les suivants :
• Évaluer l’efficacité de Nyxol pour accélérer l’inversion de la mydriase pharmacologiquement induite par de multiples agents mydriatiques, en mettant l’accent sur la phényléphrine.
• Évaluer l’efficacité de Nyxol pour ramener les sujets à l’accommodation de base après une aggravation (avec les agents cycloplégiques tropicamide et Paremyd).
• Évaluer l’innocuité du Nyxol.
• Évaluer les avantages supplémentaires de l’inversion de la mydriase induite par la pharmacologie.
• Évaluer l’exposition systémique de Nyxol sur l’échantillonnage pharmacocinétique.
Description détaillée : Une étude de phase 3 randomisée, à bras parallèles, en double aveugle, contrôlée par placebo sur au moins 330 sujets randomisés, évaluant l’innocuité et l’efficacité de Nyxol chez des sujets présentant une mydriase pharmacologiquement induite.
Une fois la sélection terminée, chaque sujet sera stratifié en fonction de la couleur de ses yeux et sera ensuite randomisé simultanément entre l’agent mydriatique (non masqué) et le traitement (masqué). La randomisation du traitement sera de 2 :1, Nyxol ou placebo (véhicule). La stratification en fonction de la couleur de l’iris sera de 1 :1, manteaux clairs ou foncés. La randomisation de l’agent mydriatique sera de 3 :1 :1 (2,5 % de phényléphrine, 1 % de tropicamide et Paremyd).
Lors de la visite de traitement, les sujets qui ont été randomisés et stratifiés en fonction de la couleur de l’iris (1 :1 [clair/obscur]) recevront l’un des trois agents mydriatiques approuvés environ une heure avant de recevoir le traitement de l’étude. Les mesures seront effectuées avant (-1 heure/ligne de base) et 60 minutes après (maximum/0 minute) l’instillation de l’agent mydriatique dans chaque œil (c’est-à-dire juste avant l’administration du traitement à l’étude), et 30 minutes, 60 minutes, 90 minutes, 2 heures, 3 heures, 4 heures et 6 heures après l’administration du traitement. Les mesures porteront sur le diamètre de la pupille (PD), l’acuité visuelle de loin et de près, l’accommodation et la rougeur dans chaque œil.
Des prélèvements sanguins pour les mesures pharmacocinétiques du Nyxol seront effectués sur un sous-ensemble d’environ 30 sujets adultes dans environ deux sites d’étude sélectionnés.
Lors de la visite de suivi, qui a lieu un jour après la visite 1, les mesures seront à nouveau enregistrées 24 heures après l’administration du traitement.
368 participants
Titre officiel : Étude randomisée, à bras parallèles, en double aveugle, contrôlée par placebo, de l’innocuité et de l’efficacité de Nyxol (solution ophtalmique de phentolamine à 0,75 %) pour inverser la mydriase induite par la pharmacologie chez des sujets en bonne santé.
Date réelle du début de l’étude : 18 novembre 2021
Date réelle d’achèvement de l’étude primaire : 18 mars 2022
Date réelle d’achèvement de l’étude : 29 mars 2022
Source : https ://clinicaltrials.gov/ct2/show/NCT05134974
Les agents ophtalmiques topiques à l’étude pour le traitement des affections du segment antérieur ne font pas toujours les gros titres de la même manière que ceux qui traitent ou retardent la progression des maladies du segment postérieur qui menacent la vision. Mais des années de développement, l’application de la technologie et des ressources et la volonté constante d’améliorer les résultats pour les patients et leur qualité de vie ont préparé le terrain pour ce qui pourrait être une année remarquable pour les innovations thérapeutiques dans la prise en charge des affections du segment antérieur.
34 OPTOMÉTRISTE | MAI | JUIN 2023
RÉFÉRENCES
1. Craig JP, Nichols KK, Akpek EK, et al. TFOS DEWS II Definition and Classification Report. Ocul Surf 2017;15(3):276-283. doi:10.1016/j.jtos.2017.05.008.
2. Aldeyra Therapeutics submits new drug application to the U.S. Food and Drug Administration for reproxalap for the treatment of signs and symptoms of dry eye disease. News release. Aldeyra Therapeutics. November 29, 2022. Accessed December 6, 2022. https://ir.aldeyra.com/ news-releases/news-release-details/aldeyra-therapeuticssubmits-new-drug-application-us-food-and.
3. Higdon A, Diers AR, Oh JY, Landar A, Darley-Usmar VM. Cell signalling by reactive lipid-species: new concepts and molecular mechanisms. Biochem J. 2012;442(3):453-464. doi:10.1042/BJ20111752.
4. Kauppinen A, Niskanen H, Suuronen T, Kinnunen K, Salminen A, Kaarniranta K. Oxidative stress activates NLRP3 inflammasomes in ARPE-19 cells—implications for age-related macular degeneration (AMD). Immunol Lett. 2012;147(1-2):29-33. doi:10.1016/j.imlet.2012.05.005.
5. https://clinicaltrials.gov/ct2/show/NCT03404115
6. https://clinicaltrials.gov/ct2/show/NCT05424549
7. https://iovs.arvojournals.org/article. aspx?articleid=2744573
8. https://pubmed.ncbi.nlm.nih.gov/35018093/
9. https://pubmed.ncbi.nlm.nih.gov/33450164/
10. https://pubmed.ncbi.nlm.nih.gov/33945820/
11. https://pubmed.ncbi.nlm.nih.gov/33529588/
12. https://pubmed.ncbi.nlm.nih.gov/32955967/
13=6. Aldeyra Therapeutics announces top-line results from the phase 3 TRANQUILITY trial in dry eye disease. News release. Aldeyra Therapeutics. December 20, 2021. Accessed December 6, 2022. https://ir.aldeyra.com/ news-releases/news-release-details/aldeyra-therapeuticsannounces-top-line-results-phase-3.
14=7. The TRANQUILITY 2 trial: a phase 3 clinical trial to assess the efficacy and safety in subjects with dry eye disease. ClinicalTrials.gov. Updated August 3, 2022. Accessed December 4, 2022. https://clinicaltrials.gov/ct2/show/ NCT05062330?term=reproxalap+ Ophthalmic+Solution&draw=2&rank=7.
15=8. Clark D, Tauber J, Sheppard J, Brady TC. Early onset and broad activity of reproxalap in a randomized, doublemasked, vehicle-controlled phase 2b trial in dry eye disease. Am J Ophthalmol. 2021;226:22-31. doi:10.1016/j. ajo.2021.01.011.
16. https://clinicaltrials.gov/ct2/show/NCT04674358
17. https://clinicaltrials.gov/ct2/show/NCT05062330
18. https://www.biospace.com/article/releases/aldeyratherapeutics-announces-positive-top-line-data-fromphase-2-dry-eye-chamber-clinical-trial-of-reproxalapan-investigational-new-drug-compared-to-xiidra-/
19. https://clinicaltrials.gov/ct2/show/NCT05102409
20. Novaliq announces FDA acceptance of the new drug application for CyclaSol for the treatment of dry eye disease. News release. Novaliq. October 24, 2022. Accessed December 6, 2022. https://www.novaliq.com/ press-releases/2022/10/24/novaliq-announces-fdaacceptance-of-the-new-drug-application-for-cyclasolfor-the-treatment-of-dry-eye-disease/
21. Agarwal P, Scherer D, Günther B, Rupenthal ID. Semifluorinated alkane based systems for enhanced corneal penetration of poorly soluble drugs. Int J Pharm 2018;538(1-2):119-129. doi:10.1016/j.ijpharm.2018.01.019.
22. Sheppard JD, Wirta DL, McLaurin E, et al. A water-free 0.1% cyclosporine A solution for treatment of dry eye disease: results of the randomized phase 2B/3 ESSENCE study. Cornea. 2021;40(10):1290-1297. doi:10.1097/ ICO.0000000000002633.
23. Novaliq announces positive topline results for second phase 3 trial (Essence-2) of CyclASol in dry eye disease. News release. Novaliq. December 21, 2021. Accessed December 6, 2022. https://www.novaliq.com/press-releases/2021/12/21/ novaliq-announces-positive-topline-results-for-secondphase-3-trial-essence-2-of-cyclasol-in-dry-eye-disease/
24. Pasquali TA, Toyos MM, Abrams DB, Scales DK, Seaman JW 3rd, Weissgerber G. Topical ocular anti-TNFα agent licaminlimab in the treatment of acute anterior uveitis: a randomized phase II pilot study. Transl Vis Sci Technol 2022;11(6):14. doi:10.1167/tvst.11.6.14.
25. Bausch + Lomb and Novaliq announce U.S. FDA filing acceptance for investigational treatment NOV03 (perfluorohexyloctane). News release. Bausch + Lomb. September 6, 2022. Accessed December 6, 2022. https://www.prnewswire.com/news-releases/ bausch--lomb-and-novaliq-announce-us-fda-filingacceptance-for-investigational-treatment-nov03perfluorohexyloctane-301617943.html
26. Tauber J, Wirta DL, Sall K, Majmudar PJ, Willene D, Krösser S; SEECASE study group. A randomized clinical study (SEECASE) to assess efficacy, safety, and tolerability of NOV03 for treatment of dry eye disease. Cornea. 2021;40(9):1132-1140. doi:10.1097/ ICO.0000000000002622
27. Sheppard JD, Kurata FK, Epitropoulos A, Krösser S, Vittitow J. Efficacy of NOV03 (perfluorohexyloctane) on signs and symptoms of dry eye disease associated with meibomian gland dysfunction: the Mojave study. Invest Ophthalmol Vis Sci. 2022;63(7):1531-A0256.
28. Bausch + Lomb presents data from second pivotal phase 3 trial of investigational treatment NOV03 (perfluorohexyloctane) at the Association for Research in Vision and Ophthalmology Annual Meeting. News release. Bausch + Lomb. May 3, 2022. Accessed December 6, 2022. https://ir.bauschhealth.com/news-relea ses/2022/05-03-2022-115916452
29. Azura Ophthalmics presents positive results from phase 2b clinical trial of AZR-MD-001 in meibomian gland dysfunction at Ophthalmology Innovation Summit XII. News release. Azura Ophthalmics. December 9, 2022. Accessed December 9, 2022. https://azuraophthalmics. com/press-releases/azura-ophthalmics-presents-positiveresults-from-phase-2b-clinical-trial-of-azr-md-001in-meibomian-gland-dysfunction-at-ophthalmologyinnovation-summit-xii/
30. Tarsus Pharmaceuticals. Tarsus Corporate Presentation. December 2022. Accessed December 9, 2022. https:// ir.tarsusrx.com/static-files/a4f36edb-9d92-46a2-a8c449a3efd6ea94
31. Yeu E, Wirta DL, Karpecki P, Baba SN, Holdbrook M; Saturn I Study Group. Lotilaner ophthalmic solution, 0.25%, for the treatment of Demodex blepharitis: results of a prospective, randomized, vehicle-controlled, doublemasked, pivotal trial (Saturn-1). Cornea. Published online August 11, 2022. doi:10.1097/ICO.0000000000003097.
32. Ocuphire Pharma announces submission of new drug application to FDA for Nyxol eye drops for reversal of mydriasis. News release. Ocuphire Pharma. December 6, 2022. Accessed December 9, 2022. https://www.ocuphire. com/news-media/press-releases/detail/393/ocuphirepharma-announces-submission-of-new-drug
33. Ocuphire announces positive topline results from MIRA-3 phase 3 FDA registration trial for Nyxol in the reversal of mydriasis. News release. Ocuphire Pharma. March 29, 2022. Accessed December 9, 2022. https://www.ocuphire. com/news-media/press-releases/detail/367/ocuphireannounces-positive-topline-results-from-mira-3
34. Karpecki PM, Foster SA, Montaquila SM, et al. Phentolamine eye drops reverse pharmacologically induced mydriasis in a randomized phase 2b trial. Optom Vis Sci. 2021;98(3):234-242. doi:10.1097/ OPX.0000000000001656.
35. Safety and efficacy of Nyxol (0.75% phentolamine ophthalmic solution) to reverse pharmacologicallyinduced mydriasis. ClinicalTrials.gov. Updated March 18, 2021. Accessed December 9, 2022. https://clinicaltrials. gov/ct2/show/NCT04620213
35 OPTOMÉTRISTE | MAI | JUIN 2023
HUMAINES
514 861-9724
sylvie.bacon@mnp.ca
Des conseils pour retenir vos employés
Avec la pénurie de main-d’œuvre qui fait rage, la compétition est forte pour mettre la main sur les meilleurs talents. Est-il possible de concurrencer les gros joueurs et de conserver à votre emploi vos ressources humaines ? Une experte de MNP, Sylvie Bacon, propose quelques stratégies simples et efficaces pour y parvenir.
La tâche est loin d’être aisée pour les employeurs qui doivent jongler avec ces différentes exigences, surtout dans le cas d’une petite organisation. En effet, si les salaires doivent demeurer concurrentiels, il n’en reste pas moins qu’il ne sera pas toujours possible pour les petites entreprises d’offrir autant que les grandes entreprises. Il faut donc se distinguer autrement. Voici quelques pistes de réflexion à explorer.
Le salaire n’est pas tout
Qui est Sylvie Bacon ?
Sylvie Bacon est directrice principale, Services-conseils-Ressources humaines chez MNP. Ses longues années d’expérience lui permettent de porter un regard aiguisé sur les grands enjeux liés à l’attraction et à la rétention des employés.

La gestion des ressources humaines est plus complexe que jamais. En effet, avant même la pandémie, la rareté de la main-d’œuvre commençait déjà à poindre à l’horizon. Et lorsque la pandémie a frappé, de nombreuses personnes ont revu leurs priorités et parfois même leur plan de carrière. Résultat : certaines ont changé d’emploi, sont retournées aux études, ont déménagé en région ou à la campagne, ou encore, ont décidé de travailler à temps partiel. Des pans entiers de l’économie mis sur pause durant la pandémie ont également vu leurs employés déserter et se reconvertir dans d’autres domaines.
Autre enjeu majeur : pour la première fois, quatre générations se côtoient sur le marché du travail. On parle ici des baby-boomers, et des générations X, Y et Z, dont les aspirations et le rapport au travail sont très différents les uns des autres (voir tableau).

En matière de rétention, il y a certains éléments essentiels à retenir. Tout d’abord le salaire n’est pas tout, car les employés veulent aussi se sentir respectés, avoir le sentiment qu’ils contribuent à quelque chose de plus grand qu’eux et qu’ils continuent d’apprendre. Ils attachent aussi une grande importance à l’équilibre travail-famille et ne sont plus prêts à se consacrer corps et âme à leur emploi au détriment de leur vie personnelle.
Autre aspect à considérer : l’environnement de travail se doit d’être exempt de conflits. Dans le cas contraire, un climat difficile ou toxique pourrait inciter les individus à quitter leur emploi pour trouver mieux ailleurs. C’est pourquoi les gestionnaires doivent s’efforcer de déterminer rapidement les sources de conflits et de les régler avant que cela ait un impact négatif sur l’environnement de travail.
36 OPTOMÉTRISTE | MAI | JUIN 2023
CHRONIQUE LES CONSEILS D’AFFAIRES MNP
PAR MADAME SYLVIE BACON, CRHA DIRECTRICE PRINCIPALE, SERVICES-CONSEILSRESSOURCES
Il faut aussi se rappeler qu’il n’y a pas de recette unique et magique. Autrement dit, ce qui fonctionne pour une entreprise ne sera pas nécessairement couronné de succès dans une autre. Une table de ping-pong ou de billard, par exemple, ne fera pas nécessairement l’unanimité, organiser des 5 à 7 non plus. Cela peut être apprécié par certains employés, mais pas par d’autres. En effet, comment trouver le temps de se rendre à un apéro entre collègues de travail si l’on doit aller chercher ses jeunes enfants à la garderie ?
Il faut donc se montrer à l’écoute de ses employés et respecter leurs différents besoins et attentes. À cet égard, un bref sondage pour en apprendre davantage sur leurs souhaits vous fournira de bons indices. Une courte activité de remue méninges à l’heure du lunch peut aussi vous aider à savoir ce que les employés désirent. Ne soyez pas surpris si les demandes sont très variées, cela nécessitera simplement d’avoir recours à différentes méthodes.
Reconnaissance au travail
Une autre bonne façon de retenir ses ressources humaines et de maintenir un niveau élevé de motivation est de leur offrir de la reconnaissance au travail, afin que chacun sente que sa contribution est reconnue. Si autrefois les employeurs se bornaient à souligner les bons coups de leurs employés par une petite tape dans le dos, la situation a radicalement changé aujourd’hui. Ici aussi, s’appuyer sur un seul type de programme de reconnaissance qui conviendrait à tout le monde ne suffit plus. Il faut en faire davantage, et surtout avoir à cœur de donner des signes de reconnaissance qui seront réellement appréciés par ceux auxquels ils sont destinés.
Si vous comptez plusieurs générations parmi vos employés, assurez-vous que chacune reçoive la reconnaissance appropriée en fonction de ses attentes. Pour limiter les coûts et vous assurer d’atteindre la cible, alternez les activités de reconnaissance tous les trois mois par exemple, en vous concentrant sur une génération à la fois.
Mettre sur pied des concours avec un tirage de prix créera aussi une certaine effervescence au sein du groupe, tout en générant un excellent retour sur investissement. Par exemple, les quelques centaines de dollars que vous coûtera une fin de semaine pour deux offerte dans un hôtel de Mont-Tremblant seront largement compensées par le sentiment de reconnaissance que cela aura généré. Autre piste : pourquoi ne pas offrir des heures rémunérées aux employés en échange d’activités de bénévolat pour l’organisme de leur choix ?
Aspirations
Baby Boomers
Devoirs : professionnel conjugal familial
Le rapport au travail
Baby boomers
Génération X
Avoirs : emploi statut famille
Génération Y
Vivre : équilibre entre vie privée et vie professionnelle
Génération Z
Socialiser : partage liens avec les autres
Génération X Génération Y Génération Z
Job pour la vie Investi dans sa carrière
1 carrière, 1 statut Moyen de progresser
Rapport dur avec l’employeur
Importance du salaire
Travailler « avec » et non « pour »
Travail fait partie d’un projet global
Monde du travail en constante évolution
Carrières multiples possible
Importance des collègues et des relations de travail
Relation donnant-donnant
37 OPTOMÉTRISTE | MAI | JUIN 2023
Dans ce contexte, l’agilité et la capacité de s’adapter ainsi que la créativité sont des incontournables. Il sera essentiel de proposer un bon éventail d’offres, susceptibles de répondre aux attentes des différentes générations.
Si nécessaire, faites également preuve de flexibilité dans les horaires de travail notamment en accordant la semaine de quatre jours ou des après-midi de congé.
CONSEILS :
� Le salaire ne suffit pas à garder ses employés motivés et fidèles à l’entreprise. Ils veulent aussi se sentir respectés et reconnus, avoir des occasions de se former et de croître à l’interne.
� Sondez vos employés pour savoir quel type de reconnaissance ils aimeraient vraiment recevoir au travail.
� Misez sur une offre diversifiée qui saura répondre aux attentes de chacun.
� Nul besoin de se ruiner : une offre moins coûteuse, mais bien ciblée sera beaucoup plus efficace.

Rappelez-vous : le salaire n’est pas tout. Bien souvent des employés préfèreront demeurer dans une entreprise où ils se sentent respectés et entendus, où ils ont un potentiel de croissance et de développement de carrière, même si on leur proposait une rémunération plus élevée ailleurs.
En investissant dans la rétention de vos talents, vous créez non seulement une dynamique positive au sein de votre équipe et de votre organisation, mais vous évitez aussi les coûts considérables que représente la perte d’un employé, tant sur le plan financier qu’en ce qui concerne l’expertise.

� Proposez des activités différentes pour que chaque génération se sente reconnue.
� Faites preuve de flexibilité, notamment dans les horaires de travail; c’est aussi une forme de reconnaissance.
38 OPTOMÉTRISTE | MAI | JUIN 2023
Au bout du compte, ces gestes de reconnaissance créeront un sentiment d’appartenance envers le groupe et pas seulement vis-à-vis de l’employeur.
Voyez-y clair avec notre équipe dévouée aux professionnels de la vue Nos experts peuvent vous aider avec la rétention de vos employés. Sylvie Bacon, CRHA | Directrice principale, Services-conseils - Ressources humaines 514.861.9724 | sylvie.bacon@mnp.ca MNP.ca Partout où mènent les affaires
CANDORVISION™ CÉLÈBRE 10 ANNÉES DE PATIENTS HEUREUX
ontréal, Avril 2023. CandorVision célèbre 10 années de patients heureux avec les gouttes ophtalmiques lubrifiantes HYLO® et HYLO® Gel. Ce furent les premières gouttes ophtalmiques multidoses, sans agents de conservation et sans phosphate sur le marché et elles continuent encore aujourd'hui à soulager la sécheresse oculaire auprès de patients canadiens de tous âges!
La famille de collyres lubrifiants HYLO® de CandorVision a transformé la vie d'innombrables patients souffrants de sécheresse oculaire, d'allergies ou en convalescence après une intervention chirurgicale.
"Nous sommes ravis de célébrer cet événement marquant et nous sommes reconnaissants aux professionnels de la santé canadiens pour la confiance et le soutien qu'ils nous accordent. Ensemble, nous continuons à faire une différence dans la vie de nombreux patients", affirme le Dr Frank Heidemann, PDG et fondateur de CandorVision. "Avec l'introduction d'HYLO® il y a dix ans, nous avons considérablement élevé la norme de soins offerts aux patients canadiens souffrant de sécheresse oculaire. De plus, HYLO® a nettement réduit le coût de la lubrification ophtalmique sans agents de conservation par rapport aux gouttes uni-dose."
HYLO® ainsi que HYLO® Gel sont sans agents de conservation et sans phosphates, et ils sont aussi approuvés pour l'usage post-chirurgical et l'usage à long terme.

Dévouée à la recherche et l'innovation, CandorVision a étendu sa gamme de traitements ophtalmiques pour combler les besoins et améliorer la santé et le bien-être de millions de patients canadiens. En pleine croissance, CandorVision continue de faire l'objet de nombreux témoignages de patients et a été acclamée pour son service à la clientèle distingué et l'excellence de ses opérations.
Au-delà de la science, CandorVision est engagé à soutenir des causes qui lui tiennent à cœur. Parmi d'autres projets ad-hoc, CandorVision soutient depuis plusieurs années la Sjögren’s Society of Canada, la fondation INCA et la clinique ophtalmologique mobile de RDVC.
"Nous sommes ravis de célébrer cet événement marquant et nous sommes reconnaissants aux professionnels de la santé canadiens pour la confiance et le soutien qu'ils nous accordent. Ensemble, nous continuons à faire une différence dans la vie de nombreux patients"
Dr. Frank Heidemann, PDG et fondateur de CandorVision
La fine pointe de la technologie allemande et les ingrédients de qualité d'HYLO®, jumelés à l'approche de CandorVision qui est axée sur le patient, ont permis à HYLO® de se démarquer auprès des ophtalmologues, des optométristes, des opticiens et d’autres professionnels de la santé dont les phar maciens. HYLO® rend leur pratique plus efficace, optimisant ainsi le temps de consultation et leur permettant de se focaliser sur leur objectif principal: soigner leurs patients.
Le flacon multidose HYLO®, de conception allemande, est à la fois pratique et convivial. Son système de pompe sans air garantit la stérilité du contenu sans avoir recours à des agents de conservation chimiques, et il distribue avec précision au moins 300 gouttes, une goutte à la fois.
L'hyaluronate de sodium de haute qualité et de masse moléculaire élevée contenu dans HYLO® assure une lubrification optimale de la cornée et un soulagement durable de la sécheresse oculaire sans affecter l'acuité visuelle.
Attentive aux besoins économiques de ses fidèles usagers, CandorVision a également mis en place un programme pour les patients depuis 2020.
"Nous restons engagés à fournir la meilleure qualité de service aux patients et aux professionnels de la santé", a déclaré Tatiana Shchukina, vice-présidente des opérations et de l'administration de CandorVision. "Alors que nous entamons la prochaine décennie, nous sommes convaincus que CandorVision continuera d'avoir un impact positif sur la vie des membres de nos communautés locales et à l'échelle nationale".
À propos de CandorVision™:
CandorVision (une division de CandorPharm Inc.) est une entreprise canadienne (détenue et dirigée par un Canadien) qui développe et commercialise des instruments médicaux ophtalmiques de la plus haute qualité pour le traitement de la sécheresse oculaire et l'hygiène des paupières au Canada.
CandorVision offre aux professionnels de la santé une technologie inégalée, axée sur la sécurité des patients et la protection de l'environnement. Pour de plus amples informations, veuillez nous contacter au numéro suivant: 514-380-5270; ou bien par courriel à l'adresse suivante:info@candorvision.com.
OF PATIENT SUCCESS DE PATIENTS HEUREUX © 2023 CANDORVISION | A DIVISION OF CANDORPHARM INC. CP 23073 MONTREAL, QC H4A 1T0, CANADA | T : 514-380-5270 SUIVEZ-NOUS : candorvision.com
PAR ME DIANA BALTAZAR, AVOCATE GROUPE FBA

1 877 579-7052
Êtes-vous un consommateur aguerri ?
Vrai ou Faux
Au Québec, la Loi sur la protection du consommateur (ci-après « LPC ») prévoit des règles spécifiques qui s’appliquent dans le cadre d’une transaction entre un consommateur et un commerçant pour l’achat de biens ou de services. En vertu de cette loi, les consommateurs bénéficient de nombreuses protections qui s’ajoutent aux principes généraux prévus au Code civil du Québec. Mettez à l’épreuve vos connaissances avec ce questionnaire ludique et fort instructif.
Vous vous gâtez pour votre anniversaire ! Vous achetez un véhicule luxueux neuf auprès d’un concessionnaire automobile. Vous le paierez en plusieurs mensualités grâce à un financement obtenu directement chez ce concessionnaire. Contrat en main, vous rentrez chez vous et votre conjointe vous annonce l’arrivée d’un nouveau petit membre dans la famille dans neuf mois. Vous regrettez immédiatement l’achat de votre voiture, réalisant que vous aurez désormais besoin d’un véhicule plus spacieux.
Avec l’arrivée du printemps et plein de bonnes intentions, vous vous êtes inscrit dans un centre de conditionnement physique pour vous remettre en forme. Vous avez pris un abonnement annuel de 12 mois. Or, quatre semaines plus tard, vous préférez fréquenter les terrasses plutôt que de vous entraîner.

Vrai ou Faux : Vous ne pouvez pas annuler votre abonnement ni demander un remboursement.
FAUX. Dans le cadre d’un contrat conclu avec un centre d’entraînement ou de contrôle de poids, la LPC prévoit qu’il est possible pour le consommateur d’annuler l’abonnement dans un délai inférieur ou égal à 1/10e de la durée totale du contrat1. Dans ce cas, le commerçant peut exiger une pénalité ne pouvant pas excéder un dixième du prix total du contrat. Dans l’exemple qui précède, si votre abonnement annuel vous a couté 300 $, puisque que vous annulez le contrat au cours des 36 premiers jours, le centre peut vous réclamer une pénalité d’au plus 30 $ et devra vous remettre les sommes que vous avez payées en avance.
Si vous désirez annuler votre abonnement après les 36 premiers jours, les règles générales du Code civil du Québec s’appliquent. S’agissant d’un contrat de service, en tant que client, vous avez le droit d’annuler votre abonnement en tout temps, mais vous devez payer la valeur des services obtenus. À titre d’exemple, si vous annulez votre abonnement annuel au coût total de 300 $ après quatre mois, vous devrez payer 100 $ de frais.
Vrai ou Faux : Vous pouvez annuler l’achat de votre voiture.
VRAI. En matière d’achat automobile, la possibilité d’annuler le contrat dépend de votre mode de paiement. Lorsque le véhicule est payé en plusieurs versements par un contrat de financement signé avec le concessionnaire, la transaction peut être annulée par le consommateur dans les deux jours de la remise d’un double du contrat au client2. Dans cette mise en situation, puisque le contrat vous a été remis au moment même de la signature, vous aurez 2 jours pour l’annuler.
Cependant, si vous payez le véhicule comptant ou moyennant un prêt personnel, il est généralement impossible d’annuler le contrat, à moins qu’une clause spécifique ne soit prévue au verso du contrat prévoyant une pénalité en cas d’annulation. En l’absence d’une telle clause, vous devrez respecter vos engagements.
40 CHRONIQUE
OPTOMÉTRISTE | MAI | JUIN 2023
JURIDIQUE
1 Article 203 de la Loi sur la protection du consommateur 2 Article 73 de la Loi sur la protection du consommateur
Votre réfrigérateur de marque GHT ne fonctionne plus : la pièce réfrigérante devra être remplacée. Vous avez acheté votre réfrigérateur il y a à peine 6 mois au magasin Frigos à Volonté, mais n’aviez pas acheté la garantie prolongée offerte par le magasin. La bonne nouvelle : la pièce est toujours garantie par le fabricant GHT et vous sera offerte sans frais.
Vrai ou Faux : Vous devrez payer la maind’œuvre du technicien pour le remplacement de la pièce.
FAUX. Peu importe si vous avez acheté la garantie prolongée du commerçant ou non, il y a une garantie légale prévue dans la LPC3. Cette garantie prévoit qu’un bien qui fait l’objet d’un contrat de consommation doit être tel qu’il puisse servir à un usage normal pendant une durée raisonnable eu égard notamment à son prix et aux conditions d’utilisation. Tant le commerçant que le fabricant du bien sont responsables de respecter cette garantie légale. Ceci signifie que, dans l’exemple qui précède, vous pouvez vous adresser tant à GHT qu’à Frigos à Volonté pour faire remplacer sans frais la pièce réfrigérante, ce qui comprend pièce et main-d’œuvre. Souvent, il y aura une entente entre commerçant et fabricant, l’un fournira la pièce et l’autre la main-d’œuvre.
Cependant, il faut noter qu’une certaine dépréciation pourrait être applicable compte tenu de l’usure du bien défectueux. La jurisprudence a établi que les électroménagers ont une durée de vie raisonnable d’environ 12 à 15 ans. Par conséquent, si, dans ce même exemple, le réfrigérateur avait cessé de fonctionner au bout de 5 ans et qu’il est impossible de le réparer, vous auriez droit à un dédommagement correspondant au tiers du prix que vous aviez payé pour acheter le réfrigérateur il y a 5 ans4
des litiges entre un consommateur et un commerçant via sa plateforme Parle.
Il s’agit d’un service gratuit qui permet de régler un bon nombre de conflits notamment en matière de garantie légale, dans un délai moyen de 25 jours, sans s’adresser aux tribunaux. Informez-vous !
Votre prochain voyage approche à grands pas et vous tombez sous le charme d’une publicité sur Facebook pour l’achat de deux nouvelles valises vendues par une entreprise basée à l’étranger. Vous payez avec votre carte de crédit. Deux semaines plus tard, vous recevez votre colis. Or, à votre grande surprise, plutôt que des valises, vous retrouvez dans votre paquet une tasse de café et un mot du commerçant vous présentant ses excuses. N’ayant plus de valises en stock, il vous offre cette belle tasse en guise de compensation.

Vrai ou Faux : Votre émetteur de carte de crédit pourrait vous rembourser.
VRAI. Il s’agit de la rétrofacturation5, qui peut être demandée à votre émetteur de carte de crédit dans le cadre des transactions conclues à distance, soit lorsque le contrat est conclu alors que vous n’êtes pas face à face et dans le même lieu que le commerçant (par exemple, en ligne, par téléphone, par la poste). Lorsque le commerçant est en défaut, le consommateur doit tout d’abord s’adresser à ce dernier pour demander un remboursement. Si le commerçant refuse, il est alors possible de demander à l’émetteur de la carte de crédit la rétrofacturation de toutes les sommes payées dans le cadre de cette transaction. Cette demande doit être faite dans les 60 jours du défaut.
Dans l’exemple qui précède, ce serait une tâche ardue que de tenter de retrouver le commerçant établi à l’étranger afin de le poursuivre au Québec pour tenter d’avoir un remboursement. Même en ayant gain de cause, le jugement serait difficilement exécutable. Cette procédure de rétrofacturation directement auprès de l’émetteur de la carte de crédit facilite grandement le processus pour les consommateurs québécois.
41 OPTOMÉTRISTE | MAI | JUIN 2023
Sachez que l’Office de la protection du consommateur met à votre disposition un service d’aide au règlement
3 Article 38, 53 et 54 de la Loi sur la protection du consommateur 4 Lemieux c. Electrolux Canada Corp, 2021 QCCQ 2265
5 Articles 54.14 de la Loi sur la protection du consommateur
Un commerçant s’est présenté chez vous et vous avez accepté de lui acheter une thermopompe. Il vous remet alors un exemplaire de votre contrat d’achat et il repassera le lendemain pour vous livrer et installer ladite thermopompe. Dans les jours qui suivent l’installation, vous réalisez que le prix que vous avez payé est trop élevé et vous regrettez cet achat.

Vrai ou Faux : Vous pouvez annuler l’achat de cette thermopompe et demander au commerçant de venir reprendra sa thermopompe.
VRAI. Lorsqu’un commerçant se présente chez vous pour vous offrir des biens ou services, il s’agit d’un « commerçant itinérant » au sens la LPC. Un contrat conclu avec ce type de commerçant peut être annulé dans un délai de 10 jours suivant la remise d’un exemplaire signé du contrat6. Ce droit de résolution existe même si le commerçant vous a déjà remis ou installé le bien acheté.
Vous devez vous adresser au commerçant pour demander l’annulation de votre contrat et celui-ci aura ensuite 15 jours pour vous rembourser. Les frais de retour du bien sont d’ailleurs à la charge du commerçant. Dans l’exemple qui précède, le commerçant devra également remettre les lieux dans leur état initial, ce qui implique notamment de réparer le mur sur lequel il a installé la thermopompe. Si vous avez des questions sur ce sujet ou sur toute autre question juridique, vous pouvez contacter les avocats de votre ligne d’assistance téléphonique juridique gratuite du lundi au vendredi de 8 h à 18 h en composant le 1-877-579-7052.
 6 Article 59 de la Loi sur la protection du consommateur
6 Article 59 de la Loi sur la protection du consommateur




Références : 1. Données internes, CVI. Basé sur la gamme de produits stockés et MTO disponibles aux États-Unis et en Europe en juin 2021. 2. Données internes 2021. Base de données sur la couverture des Rx ; 14-70 ans. 3. [MyDayMD à usage unique et BiofinityMD] sont définis comme des commandes et comprennent le produit [MyDayMD à usage unique, MyDayMD toric à usage unique, MyDayMD multifocal à usage unique, BiofinityMD sphere, BiofinityMD XR, BiofinityMD Energys, BiofinityMD toric, BiofinityMD XR toric, BiofinityMD multifocal et BiofinityMD toric multifocal] vendu et distribué par CooperVision au Canada. 4. L’empreinte plastique neutre nette est établie par l’achat de crédits auprès de Plastic Bank. Un crédit représente le recueil et la conversion d’un kilogramme de plastique susceptible d’atteindre ou de se retrouver dans un cours d’eau à l’échelle mondiale. CooperVision achète un nombre de crédits égal au poids du plastique dans les commandes de [MyDayMD à usage unique et BiofinityMD] au cours d’une période précise. Le plastique de [MyDayMD à usage unique et BiofinityMD] est déterminé par le poids du plastique dans l’emballage-coque, les lentilles et l’emballage secondaire, y compris les stratifiés, les adhésifs et les ajouts auxiliaires (par exemple, l’encre). RÉFÉRENCE : Données internes, CVI, 2022. ©2023 CooperVision. BiofinityMD Chronologie des innovations
NEUTRE PLASTIQUEENNET GRÂCE À PARTENARIATNOTREAVEC PLASTIC BANK3,4 Pour en savoir plus, visitez coopervision.ca/fr
MAINTENANT
PAR LE DOCTEUR JEAN-PIERRE LAGACÉ OPTOMÉTRISTE, M.Sc CHRONIQUE ACTUALITÉS

Contrairement à la CRSC induite par les stéroïdes (CRSCs), les sous-types idiopathiques (CRSCi) peuvent présenter un rapport plus important entre l’épaisseur de la couche des gros vaisseaux choroïdiens et l’épaisseur choroïdienne sous-fovéale, ainsi qu’un rapport plus important entre la surface luminale et la surface choroïdienne totale.
Un nouveau paradigme dans le traitement de la choriorétinopathie séreuse centrale (CRSC) est en train d’émerger : il s’agit moins d’attendre et d’observer pendant précisément 3 mois avant de traiter ce trouble que de considérer les caractéristiques structurelles de présentation dans un continuum.
« Je pense que le plus grand obstacle avec cette maladie est que nous l’avons appelée aiguë et chronique », a déclaré le Dr Jay Chhablani, spécialiste de la chirurgie vitréo-rétinienne au Centre de l’œil de l’université de Pittsburgh, professeur associé d’ophtalmologie et membre du comité de rédaction de l’American Journal of Ophthalmology. Il arrive que les patients ne consultent qu’après que la CRSC ait déjà causé des dommages en dehors de la fovéa. Le Dr Chhablani traite donc en fonction de l’état des dommages plutôt que du temps écoulé depuis la présentation.
« En d’autres termes, les yeux atteints de CRSC idiopathique présentent des caractéristiques pachychoroïdiennes induites par des perturbations de l’écoulement à travers la sclérotique », a déclaré le Dr Koizumi. « De nombreux troubles présentent des manifestations similaires, comme le décollement séreux de la rétine, et les structures intrachoroïdiennes sont des marqueurs utiles pour poser le bon diagnostic de CRSC idiopathique ». Étant donné que les structures intrachoroïdiennes des yeux atteints de CRSC idiopathique sont plus faciles à repérer que celles des yeux atteints de CRSC, il peut être avantageux d’utiliser plus que la seule tomographie par cohérence optique (TCO) pour distinguer la CRSC des yeux normaux ou d’autres pathologies maculaires, a-t-il ajouté.
Les travaux les plus récents du Dr Koizumi et de ses collègues portent sur l’examen des dossiers médicaux de 110 patients atteints de CRSC qui ont consulté un centre ophtalmologique universitaire au Japon2. Les dossiers étudiés comprenaient 96 yeux atteints de CRSCi et 14 yeux atteints de CRSCs, comme l’a rapporté en février Ophthalmology Science. Les diagnostics de CRSC étaient fondés sur l’imagerie par TCO, l’angiographie à la fluorescéine et l’angiographie au vert d’indocyanine (AVI), qui illustraient des modifications des schémas circulatoires choroïdiens, telles qu’un retard de remplissage précoce, une dilatation moyenne ou tardive des vaisseaux et une hyperperméabilité vasculaire.
Selon des recherches récentes et les observations d’experts cliniques, il se pourrait que l’approche « attendre et voir » lors de la prise en charge des patients atteints de CRSC s’applique à un nombre plus restreint de personnes que ce que l’on pensait auparavant. Il ne fait aucun doute que la CRSC disparaît souvent spontanément en trois mois ou moins. Cependant, la pathologie peut trouver son origine à la périphérie de la rétine sans être détectée.
« Je dirais que ces patients sont (parfois) nettement sous-traités », a déclaré le Dr Chhablani. Il ajoute qu’une petite quantité de liquide peut ne pas susciter d’inquiétude, car la vision est toujours de 6/6. « Ce n’est pas parce qu’elle est de 6/6 et que nous avons ce qu’on appelle l’histoire naturelle de la maladie, qui dit qu’elle va se résoudre d’elle-même; ce qu’elle va laisser derrière elle, personne ne le comprend. » Pour commencer, lui et son équipe de recherche font largement appel à l’imagerie multimodale1

D’abord, utiliser davantage l’imagerie multimodale

Hideki Koizumi, MD, Ph. D., chercheur clinique, professeur et président de l’Université des Ryukyus, Okinawa, Japon, utilise l’imagerie multimodale pour discerner les sous-types de la maladie.
Les chercheurs ont comparé les structures de la CRSCi et de la CRSCs et ont constaté que l’épaisseur moyenne de la sclère était significativement plus fine dans la cohorte CRSCs que dans le groupe CRSCi. Ce facteur suggère que la sclérotique est moins impliquée dans la pathogenèse de la maladie chez les personnes atteintes de troubles induits par les stéroïdes2
La pathogénie exacte de la choriorétinopathie séreuse centrale n’est pas entièrement connue, bien que les chercheurs soupçonnent une relation avec le stress, en particulier chez les hommes, les patients âgés de 30 à 60 ans, les patients fumeurs, ceux dont la longueur axiale est courte ou ceux qui ont été exposés aux corticostéroïdes. Un groupe de recherche japonais a mis en évidence une sclère plus épaisse chez les patients atteints de CRSC idiopathique (CRSCi) par rapport aux yeux normaux, et a émis l’hypothèse que la circulation choroïdienne pouvait être perturbée par l’épaississement de la sclère.
Cette équipe a maintenant mené la première étude comparant l’épaisseur sclérale de patients atteints de CRSC idiopathique à celle de patients présentant des signes de CRSC induite par les stéroïdes, comme le rapporte Ophthalmology Science. L’étude montre que l’épaisseur de la sclère est significativement plus fine chez les patients atteints de CRSCs que chez ceux atteints de CRSCi, ce qui suggère que la sclère est moins impliquée dans la pathogenèse de la maladie dans le premier groupe.
44 OPTOMÉTRISTE | MAI | JUIN 2023
Pour la choriorétinopathie séreuse centrale, il n’est plus nécessaire d’attendre et d’observer
Les chercheurs ont examiné les dossiers médicaux de 110 yeux de 110 patients atteints de CRSC entre octobre 2018 et octobre 2020. Les dossiers étudiés comprenaient 96 yeux avec CRSCi et 14 yeux avec CRSCs. Pour les personnes atteintes de CRSCs, l’exposition aux stéroïdes comprenait des médicaments dermiques, inhalés, intranasaux, oraux et topiques.
Les diagnostics de CRSC étaient fondés sur l’imagerie par tomographie par cohérence optique, angiographie à la fluorescéine et angiographie au vert d’indocyanine (AVI), qui illustraient des modifications des schémas circulatoires choroïdiens, notamment un retard de remplissage précoce, une dilatation des vaisseaux médians ou tardifs et une hyperperméabilité vasculaire. L’épaisseur sclérale a été mesurée à 6 mm en arrière de l’éperon scléral, verticalement du bord antérieur au bord postérieur de la sclère. L’épaisseur sclérale moyenne était significativement plus fine dans la cohorte CRSCs que dans le groupe CRSCi aux points mesurés en supérieur (P = 0,001), inférieur (P = 0,002), nasal (P = 0,001) et temporal (P = 0,018).
Les patients de l’ensemble CRSCs étaient plus nombreux à être des femmes (P = 0,015), ce qui concorde avec des études antérieures montrant que les patients féminins atteints de CRSCs sont plus affectés par l’utilisation de corticostéroïdes que les hommes. Dans l’analyse multivariable, les facteurs significatifs influençant l’apparition du CRSCs se sont révélés être l’épaisseur sclérale moyenne aux quatre points directionnels (P = 0,002), et le sexe féminin (P = 0,046). L’enquête suppose que les différences entre les femmes et les hommes dans la régulation des hormones sexuelles peuvent créer des conditions uniques influençant le rôle que jouent les stéroïdes dans le déclenchement de la CRSC.
Source : https ://www.ophthalmologyadvisor.com/topics/retina-vitreous/scleralthickness-less-involved-in-steroid-linked-CRSC-than-idiopathic/
L’angiographie par TCO (A-TCO) peut également être utile. Une revue exhaustive publiée en mai 2021 par Survey of Ophthalmology a exploré l’utilisation de l’A-TCO pour détecter les changements structurels de la CRSC et caractériser les lésions néovasculaires choroïdiennes (NVC), comme l’ont rapporté 59 études3. Dans plusieurs enquêtes, on a constaté une perfusion mixte au début de la maladie et une hyperperfusion après la résolution, avec des « modèles de flux mixtes » à différents stades de la CRSC. Par conséquent, même en présence de facteurs de confusion, l’A-TCO a permis d’obtenir une image claire des changements capillaires délicats, mieux que les outils traditionnels, selon l’analyse documentaire.
Un certain nombre d’études ont examiné les changements dans la choriocapillaire (CC), y compris des résultats classant les schémas de flux en zones concentriques de signaux de flux faibles et élevés, ou « un schéma en mosaïque de signaux de flux faibles et élevés aléatoires ». Dans l’ensemble, l’A-TCO s’est révélée fiable pour découvrir des changements dans les vaisseaux choroïdiens superficiels et profonds. De plus, l’A-TCO a révélé des signaux CC perturbés et d’autres changements importants dans les yeux controlatéraux3
Deuxièmement, regarder la périphérie de la rétine et l’autre œil
Le Dr Chhablani étudie toujours les deux yeux. « Ne considérez pas cela comme une maladie d’un seul œil, il y a certainement, probablement quelque chose qui se passe dans l’autre œil », a-t-il expliqué. « Et une chose très importante, dont je parle dans de nombreuses réunions, et que je dis toujours, c’est qu’il ne faut pas ignorer un fluide peu profond de longue date, même avec 6/6 ».
Il a ajouté que, même si un patient se présente chez l’ophtalmologiste pour la première fois, après examen, il pourrait être clair que les dommages ne sont pas récents. Dans ce cas, il proposerait un traitement plutôt hâtif que tardif. À l’inverse, si le patient a une apparition récente et qu’il n’y a que des changements limités dans des zones limitées, il attend généralement et observe attentivement pendant environ 2 mois. Si le liquide ne se résorbe pas dans ce laps de temps, il propose alors une option de traitement.
Le Dr Koizumi observe un délai similaire. Il veut prévenir les dommages causés par le décollement de la rétine. « Dans le cas de la choriorétinopathie séreuse centrale idiopathique, j’attends généralement 3 mois, à moins que le patient ne souhaite un traitement précoce, car des études expérimentales antérieures ont suggéré que les photorécepteurs pourraient commencer à présenter une apoptose en présence d’un décollement de la rétine après 4 mois », a-t-il déclaré. Dans le cas d’une CRSC induite par les stéroïdes, les deux yeux d’un patient peuvent être affectés et il consulte son médecin pour savoir si le stéroïde peut être interrompu en toute sécurité.
Troisièmement, vérifier si c’est vraiment une CRSC
Le Dr Chhablani est l’un des auteurs principaux de l’article systématique « Masqueraders of Central Serous Chorioretinopathy », publié dans Survey of Ophthalmology1 La CRSC est souvent mal diagnostiquée en raison de caractéristiques structurelles qui se chevauchent avec celles d’autres troubles, ou de patients présentant des signes atypiques.
Les chercheurs ont analysé près de 100 articles en langue anglaise à partir d’une recherche documentaire approfondie. Ils ont découvert que les troubles imitant la CRSC pouvaient être classés en 5 grandes catégories :
1) Maladies vasculaires choroïdiennes;
2) Conditions inflammatoires;
3) Maladies vasculaires de la rétine;
4) Anomalies anatomiques;
5) « Autres », y compris la prolifération mélanocytaire uvéale diffuse bilatérale, les bestrophinopathies et le syndrome d’effusion uvéale1
« Franchement, je pense que l’une des conditions les plus courantes est la dégénérescence maculaire liée à l’âge (DMLA) », a expliqué le Dr Chhablani. Il a ajouté que la vasculopathie choroïdienne polypoïdale est un autre masque fréquent. Il a également observé que les dépôts vitelliformes sont parfois confondus avec la CRSC.
45 OPTOMÉTRISTE | MAI | JUIN 2023
Les bestrophinopathies, l’ensemble des maladies causées par la mutation du gène BEST1, peuvent également entraîner une perte de vision centrale. Dans la dystrophie maculaire vitelliforme de BEST, des lésions ressemblant à un jaune d’œuf peuvent apparaître au niveau des macules. Les dépôts sous-rétiniens imagés par TCO peuvent être vus comme hyperréfléchissants, mais les dépôts peuvent être « remplacés par un fluide clair » et imiter un dépôt sous-rétinien typique du CRSC1
Le signe de la double couche aide à détecter la néovascularisation maculaire
En ce qui concerne les tests non invasifs, davantage de cliniques ont accès à la TCO qu’à l’A-TCO et un paramètre structurel, le signe de la double couche (SDC), est censé aider à identifier les patients à risque de néovascularisation maculaire (NVM) secondaire à la CRSC. Le SDC a été défini comme une région surélevée de l’épithélium pigmentaire rétinien (EPR) d’une longueur minimale de 1 000 μm et d’une hauteur maximale de 150 μm, et examiné comme une aide au diagnostic, y compris les caractéristiques principales sous l’EPR surélevé, selon une nouvelle étude rétrospective publiée dans American Journal of Ophthalmology4
En utilisant l’A-TCO comme norme de référence, les investigateurs du Royaume-Uni ont examiné les dossiers médicaux de 163 yeux de 132 patients ayant reçu un diagnostic clinique de CRSC. L’âge moyen des participants était de 55,2 ±12,2 ans au moment des scans, réalisés entre novembre 2016 et mars 2020.
Les investigateurs ont calculé que la sensibilité du SDC pour détecter la NVM était de 87,0 % et la spécificité de 56,0 %. Notamment, les caractéristiques de l’espace sous-épithélial se sont révélées être indépendamment liées à la NVM : hyperréflectivité (P = 0,001) et non-homogénéité (P = 0,02). Après avoir incorporé l’hyperréflectivité et la non-homogénéité au SDC dans tous les yeux ayant reçu un diagnostic de CRSC, la sensibilité pour discerner la NVM était légèrement inférieure, à 85,2 %, mais la spécificité atteignait 82,6 %.
« Un espace non homogène et hyperréfléchissant sous un EPR élevé, quelle que soit sa longueur ou sa hauteur, indique un œil présentant un risque plus élevé de NVM que de SDC », selon l’analyse. « L’A-TCO devrait au moins être réalisée pour ces yeux afin de confirmer la présence de NVM et de traiter en conséquence»4
Garder à l’esprit les phénotypes liés à l’EPR et à la choroïde Une étude prospective et interventionnelle a suivi pendant deux ans 96 yeux de 96 patients atteints d’une nouvelle CRSC et 210 yeux de 210 personnes témoins dans le cadre d’une analyse d’imagerie multimodale visant à distinguer deux sous-types : la CRSC liés à l’épithélium pigmentaire de la rétine (CRSC-EPR) et la CRSC liée à la choroïde (CRSC-C), selon l’article publié dans Translational Vision Science & Technology5
Les chercheurs ont constaté que le phénotype CRSCEPR présentait une épaisseur choroïdienne normale, ainsi qu’une « hypofluorescence irrégulière dans les phases tardives de l’AVI (angiographie au vert d’indocyanine) avec des atténuations correspondantes du signal de la bande rétinienne externe sur la TCO structurelle ».
Le type CRSC-C présentait une pachychoroïde, y compris une dilatation des vaisseaux choroïdiens dans les premières phases de l’AVI, dans les dernières phases de l’AVI, un fond isofluorescent a été observé, sans déficiences dans la bande rétinienne externe. La NVM a été trouvée dans 19 % de l’échantillon global. Parmi ceux-ci, 72 % étaient membres du sous-groupe CRSC-EPR et 28 % du sous-groupe CRSC-C5
Questions sur le stress et les stéroïdes
Le Dr Chhablani a noté qu’un autre défi avec la CRSC est qu’elle touche une population plus jeune, souvent une population active. « Leur vision peut être très bonne en chiffres, comme 20/40, 20/60, mais ils sont quand même très perturbés et cela affecte leur qualité de vie », a-t-il expliqué.
Un ensemble de travail peut être plus affecté par le stress, le cortisol et les stéroïdes endogènes et exogènes. « Ce ne sont encore que des spéculations, mais l’usage à long terme de stéroïdes pourrait induire des changements d’épaisseur ou de qualité de la sclère », a déclaré le Dr Koizumi. « Les stéroïdes peuvent éventuellement modifier le nombre et la disposition des faisceaux de fibres de collagène et/ou la quantité et la qualité de la matrice dans la sclère ». Cependant, il a ajouté que l’effet des stéroïdes sur la qualité et l’épaisseur de la sclère n’est toujours pas clair.
Il est intéressant de noter que les stéroïdes peuvent entraver l’absorption de la norépinéphrine par les cellules gliales et ainsi augmenter le niveau de norépinéphrine au niveau des terminaisons nerveuses sympathiques, ce qui favorise la domination du système nerveux sympathique2
« L’utilisation de stéroïdes exogènes peut avoir un effet additif sur la choroïde dans la CRSC induite par les stéroïdes. L’augmentation de l’activité sympathique provoque hypothétiquement une augmentation du débit cardiaque au niveau systémique, et une vasoconstriction artérielle et le déséquilibre du flux sanguin qui en résulte dans la choroïde au niveau local », explique le Dr Koizumi.
Un rapport de cas notable publié dans Retinal Cases & Brief Reports présente le cas de 2 couples mariés, chacun des conjoints a reçu un diagnostic de CRSC6. L’analyse émet l’hypothèse que les 2 couples aient pu être exposés à des facteurs de stress communs ou à une exposition secondaire aux stéroïdes. Le premier couple s’est présenté à la clinique le même jour, mais aucun des deux individus n’était au courant d’un quelconque contact avec des stéroïdes. À l’inverse, le mari du second couple (34 ans) souffrait de sinusite chronique et prenait des stéroïdes par voie nasale et orale. Il avait une histoire d’un mois de « vision floue » dans son œil droit. L’AV de cet œil était de 20/30. Son fluide sous-rétinien ne s’étant pas résorbé au bout de trois mois, il a subi une thérapie photodynamique (TPD). Trois jours après ce traitement, sa femme (38 ans) s’est plainte d’une vision floue bilatérale, bien que 6/6. La TCO a mis en évidence une choroïde épaisse dans les deux yeux, un grand décollement de l’épithélium pigmentaire (DEP) dans l’œil droit et trois petits DEP dans l’œil gauche. Elle a signalé des niveaux élevés de stress récents6
46 OPTOMÉTRISTE | MAI | JUIN 2023
Lors d’une conférence donnée en 2018 à l’Université de Floride du Sud, le Dr Steven Cohen, professeur clinicien d’ophtalmologie, a parlé d’un autre cas unique de ce trouble chez une patiente âgée de 12 ans7. Elle s’est présentée à la clinique avec un historique de deux semaines de perte de la vision centrale de l’œil droit, avec une AV de 6/120, l’œil gauche était à 6/6. La patiente venait d’avoir ses premières règles, présentait des antécédents d’hypothyroïdie et utilisait un vaporisateur nasal de stéroïdes pour une infection des sinus.
L’examen, la TCO et l’AF ont révélé un léger gonflement autour du nerf optique et un grand décollement séreux de la rétine dans la macula de l’œil droit. Soucieux des différentiels pédiatriques, comme une augmentation de la pression intracrânienne, le Dr Cohen n’a pas voulu attendre longtemps. Cependant, sa vision s’est améliorée à 6/12 en 3 jours après l’arrêt du vaporisateur intranasal, et le décollement séreux de la rétine a presque disparu. Après 1 mois, l’AV est revenue à 6/6 avec des maculas normales7
La thérapie laser à faible seuil est souvent choisie
Les thérapies actuelles souvent choisies pour la CRSC comprennent la thérapie photodynamique (TPD), le laser à onde continue et le laser à faible seuil ou à microimpulsion. Le Dr Chhablani prend en compte l’endroit où se produit la fuite. « Si la fuite ou le laser concerne la zone centrale, je dirais que le laser conventionnel n’est absolument pas une option, mais le laser à faible seuil ou la thérapie photodynamique le sont », explique-t-il. « Et si les deux sont disponibles, je préférerais le laser à faible seuil, car il n’entraîne aucun dommage structurel ». Il emploie cette thérapie depuis 6 à 7 ans avec de bons résultats et se dit convaincu qu’en cas de besoin, elle peut être répétée.
La micro-impulsion permet de contrôler l’augmentation de la température dans le tissu et déclenche une réponse biologique anti-angiogénique et réparatrice qui entraîne la réabsorption du fluide sous-rétinien par la restauration des cellules de l’EPR8
Des chercheurs polonais ont démontré l’efficacité d’un traitement précoce transfovéal au laser à micropulse sous le seuil chez 32 patients, âgés en moyenne de 48,2 ±11,0 ans, qui ont développé une CRSC – avec une durée moyenne des symptômes de 3,4 ±2,3 mois (fourchette de 3 semaines à 6 mois), selon l’enquête publiée en 2019 par le Journal of Clinical Medicine9. Après la micropulsion, le liquide sous-rétinien était complètement résolu chez 81,25 % des participants. Notamment, les patients qui ont reçu un traitement dans les 2 mois suivant l’apparition des symptômes ont connu une meilleure MAVC moyenne à 0,09 ±0,09 logMAR, que ceux qui ont obtenu une micropulsion 2 à 6 mois après le début des symptômes, 0,34 ±0,20 logMAR (P = 0,00003).
Par rapport aux patients qui ont répondu au traitement, ceux qui n’ont pas répondu avaient tendance à avoir une moins bonne AV initiale, mais pas nécessairement une maladie plus longue. « À la lumière de ces résultats, il semble que, même dans les cas de CRSC autolimités, les dommages rétiniens potentiellement limitants sur le plan visuel commencent avec l’apparition de la maladie et s’aggravent au fur et à mesure que la maladie persiste », suggère l’analyse9
L’éplérénone et les thérapies combinées fonctionnent pour certains
Le Dr Chhablani a obtenu des résultats mitigés avec l’éplérénone, notant que certains patients ne montrent aucune réponse, et que d’autres ont bien répondu.
« C’est pourquoi je garde l’éplérénone dans mon arsenal thérapeutique, car si les patients ne répondent à rien, on aimerait parfois qu’ils essaient l’éplérénone, ou parfois je l’utilise dans une thérapie combinée », explique-t-il.
Une vaste étude en double aveugle examine les résultats de 114 participants de 22 hôpitaux du Royaume-Uni randomisés 1 :1 pour recevoir de l’éplérénone orale plus les soins habituels ou un placebo plus les soins habituels pendant une période de 12 mois entre janvier 2017 et février 201810
La posologie de l’éplérénone était de 25 mg par jour pendant 1 semaine, puis augmentée à 50 mg par jour jusqu’à 1 an. Le principal résultat mesuré était la MAVC en lettres ETDRS (Early Treatment Diabetic Retinopathy Study).
La moyenne modélisée de la MAVC à 1 an n’était pas significativement différente entre les cohortes : 80,4 ±4,6 lettres pour ceux prenant de l’éplérénone contre 79,5 ±4,5 pour le placebo, avec une différence moyenne ajustée de 1,73 lettre (P = 0,24). L’enquête déconseille l’utilisation de l’éplérénone comme mode de traitement de première intention10
D’autres recherches ont porté sur les injections d’anti-VEGF pour la CRSC.
Le médicament anti-facteur de croissance endothélial vasculaire (VEGF) bévacizumab a donné des résultats à long terme chez les patients atteints de choriorétinopathie séreuse centrale (CRSC), selon une nouvelle étude1 Environ 90 % des yeux atteints de CRSC ont présenté au moins une rémission complète au cours d’un suivi moyen de 35 mois, selon la recherche1. Cependant, la moitié des yeux qui ont connu au moins une résolution complète ont développé une récidive1
L’étude a pris en compte 45 yeux de 44 patients du Collège de médecine de l’Université catholique Kwandong, Hôpital international St. Mary’s, à Incheon, en Corée. Les patients atteints de CRSC aiguë ou chronique ont reçu des injections intravitréennes de bévacizumab (IIVB) à intervalles de 4 semaines, selon les besoins, pour résoudre le liquide sous-rétinien détecté à l’imagerie. Les chercheurs ont étudié les résultats à long terme des injections intravitréennes de bévacizumab et ont examiné les facteurs prédictifs des récidives de CRSC impliquant la macula.
Au cours d’une période de suivi d’au moins 2 ans, 88,9 % des patients (40 yeux) atteints de CRSC ont développé au moins une résolution complète avec une moyenne de 2,7 IIVB, ont écrit les auteurs de l’étude. Sur les 40 yeux qui ont présenté au moins une résolution complète, 20 ont développé une ou plusieurs récidives1. Selon les chercheurs, une épaisseur choroïdienne sous-fovéale supérieure ou égale à 300,0 μm était associée à un plus grand risque de récidive1. Ils supposent que l’épaisseur choroïdienne sous-fovéale moyenne peut signifier l’activité de la maladie, y compris l’hyperperméabilité choroïdienne, une choroïde plus mince chez les patients atteints de CRSC « peut indiquer une pression hydrostatique plus faible»1
47 OPTOMÉTRISTE | MAI | JUIN 2023
La thérapie photodynamique (TPD) a donné des résultats plus cohérents que les IIVB dans les cas de CRSC, mais elle peut avoir des complications, selon la littérature1, 2. Ces complications peuvent inclure une néovascularisation choroïdienne secondaire et une hypoperfusion choroïdienne1, 2
État actuel du financement et des essais
Le Dr Chhablani fait remarquer que la DMLA est une maladie menant à la cécité bien connue, qui reçoit la part du lion du financement des nouveaux essais, la CRSC reçoit moins de soutien de la part de l’industrie et des organismes subventionnaires publics. Par conséquent, la compréhension de la pathogenèse de cette maladie et la normalisation des meilleurs traitements sont encore difficiles. Il a établi des liens avec un groupe international d’ophtalmologistes intéressés, travaillant sur de nouvelles études axées sur les systèmes de classification et examinant l’efficacité des options thérapeutiques.
RÉFÉRENCES
1. Sahoo NK, Singh SR, Rajendran A, Shukla D, Chhablani J. Masqueraders of central serous chorioretinopathy. Survey of Ophthalmology. 2019;64(1) :30-44. doi :10.1016/ jsurvophthal.2018.09.001.
2. Sawaguchi S, Terao N, Imanaga N, et al. Scleral thickness in steroid-induced central serous chorioretinopathy. Ophthalmol Science. Published online on February 7, 2022. doi :10.1016/j.xops.2022.100124.
Les ophtalmologistes pratiquent souvent l’observation pour les cas de CRSC, car la majorité des cas se résolvent sans intervention en 3 mois environ1. La nouvelle étude suggère qu’une intervention précoce pourrait être plus demandée que ce que l’on pensait auparavant, car la CRSC aiguë peut se reproduire moins longtemps après les IIVB en réduisant l’hyperperméabilité choroïdienne au stade précoce de la maladie1
En raison de la petite taille de leur échantillon, de l’absence de groupe témoin dans l’étude et des 10 % de patients qui n’ont pas montré une résolution complète du liquide sous-rétinien après plusieurs IIVB, les chercheurs recommandent de comparer davantage les modalités de traitement : observation, IIVB avec thérapie photodynamique et une combinaison de thérapies1
Une recherche de 2015 a souligné les effets bénéfiques limités du bévacizumab dans l’amélioration de l’acuité visuelle et la réduction du liquide sous-rétinien sans complications significatives. Cette étude a expliqué que la CRSC, bien que non associée à une augmentation des niveaux oculaires de VEGF, pourrait bénéficier d’un traitement anti-VEGF pour réduire l’hyperperméabilité choroïdienne. Elle a également introduit l’hypothèse selon laquelle la voie minéralocorticoïde (MR) joue un rôle important dans le développement et le traitement de la maladie2

RÉFÉRENCES
1. Kang HM, Choi JH, Koh HJ, Lee SC. Long-term treatment response after intravitreal bevacizumab injections for patients with central serous chorioretinopathy. PLoS One. 2020 :15(9) : e0238725 : doi : 10.1371/journal.pone.0238725.
2. Daruich A, Matet A, Dirani A, et al. Central serous chorioretinopathy : Recent findings and new physiopathology hypothesis. Progress in Retinal and Eye Research. 2015 :48(9) :82-118. doi : 10.1016/j. preteyeres.2015.05.003.
Source : https ://www.ophthalmologyadvisor.com/topics/retina-vitreous/anti-vegfinjections-affirmed-for-some-CRSC/
3. Pujari A, Surve A, Azad SV, et al. Optical coherence tomography angiography in central serous chorioretinopathy : The current clinical role and future perspectives. Surv Ophthalmol. 2022;67(1) :68-82. doi :10.1016/j.survophthal.2021.05.003.
4. Hagag AM, Rasheed R, Chandra S, Jeffery G, Sivaprasad S. The diagnostic accuracy of double-layer sign in detection of macular neovascularization secondary to central serous chorioretinopathy. Am J Ophthalmol. Published online first October 23, 2021. doi :10.1016/j.ajo.2021.10.021.
5. Arrigo A, Aragona E, Bordato A, et al. Acute central serous chorioretinopathy subtypes as assessed by multimodal imaging. Trans Vis Sci Tech. 2021;10(13) :6. doi :10.1167/tvst.10.13.6
6. Kanesa-thasan A, Fawzi AA, Gill MK. Presentation of central serous chorioretinopathy in two husband and wife couples. Retinal Cases & Brief Reports.2018;12(2) :100-102. doi :10.1097/ICB.0000000000000452.
7. Cohen S. Central serous chorioretinopathy. Resident lecture February 2018. https ://www.youtube.com/ watch ?v=nRod55lYARU. Published February 5, 2018. Accessed February 14, 2022.
8. Munir Escaf, MD. Laser therapy may offer fast-acting option for CSR resolution. https ://www.modernretina. com/view/laser-therapy-may-offer-fast-acting-option-csrresolution Modern Retina. Published November 12, 2018. Accessed February 11, 2022.
9. Gawęcki M, Jaszczuk-Maciejewska A, Jurska-Jaśko A, Kneba M, Grzybowski A. Transfoveal micropulse laser treatment of central serous chorioretinopathy within six months of disease onset. J Clin Med. 2019;8(9) :1398. doi :10.3390/jcm809139810.
10. Lotery A, Sivaprasad S, O’Connell A, Harris RA, Culliford L, et al. Eplerenone for chronic central serous chorioretinopathy in patients with active, previously untreated disease for more than 4 months (VICI) : a randomized, double-blind, placebo-controlled trial. The Lancet. 2020;395(10220) :294-303. doi :10.1016/S01406736(19)32981-2.
Source : https://www.ophthalmologyadvisor.com/topics/retina-vitreous/leading-expertsadvise-not-to-default-to-a-wait-and-see-model-for-CRSC/#:~:text=A%20 new%20paradigm%20in%20the,structural%20characteristics%20along%20a%20 continuum.
48 OPTOMÉTRISTE | MAI | JUIN 2023
Les verres de lunettes SightGlass ont réduit la longueur axiale chez les enfants après 3 ans
Les verres de lunettes de la technologie de l’optique de diffusion étaient sûrs et réduisaient de manière statistiquement significative la longueur axiale à 3 ans chez les enfants ayant commencé le traitement entre 6 et 10 ans, selon une étude présentée à l’Academy 2022.
Les solutions actuelles de contrôle de la myopie sont rarement évaluées chez les enfants myopes dès l’âge de 6 ou 7 ans, selon cette étude menée par Deborah Laughton, MSOptom, FBCLA, Ph. D., de SightGlass Vision, et ses collègues.
« L’étude CYPRESS a été conçue pour étudier la sécurité et l’efficacité des lunettes à technologie d’optique de diffusion chez 256 enfants myopes âgés de 6 à 10 ans », a déclaré Laughton dans sa présentation. « Nous avons effectué des analyses à 12, 24 et 36 mois ».
Les enfants qui ont passé un premier examen ont été répartis au hasard dans l’un des trois groupes de traitement et ont reçu des lunettes au début de l’étude, a-t-elle précisé.
Les lentilles de test ont été conçues pour réduire légèrement le contraste rétinien à l’aide de milliers de micropoints qui diffusent doucement la lumière, selon un communiqué de presse de la société.
Les chercheurs ont effectué une réfraction cycloplégique, mesuré la longueur axiale et évalué la sensibilité aux contrastes élevés et faibles ainsi que l’acuité visuelle périphérique à 1 mois, 6 mois et tous les 6 mois par la suite, a déclaré Laughton.
« Nous avons inclus des enfants aussi jeunes que 6 et 7 ans », a-t-elle précisé. « Nous savons que ce sont les enfants qui ont le plus de risques de devenir très myopes. Il n’existe aucune option approuvée par la FDA pour ces jeunes enfants. »
Un éventail d’ethnies a été inclus, a-t-elle ajouté.
« Les événements indésirables ont été très faibles et similaires entre les groupes, a déclaré Laughton. L’acuité visuelle était similaire entre les groupes test et témoin et stable tout au long de l’étude, pour les mesures à fort contraste, de loin, de près et à faible contraste. »
« L’étude a satisfait aux critères d’évaluation principaux, à savoir une réduction statistiquement significative de la longueur axiale dans le groupe test par rapport au groupe témoin, poursuit Laughton. La réfraction équivalent sphérique [RES] était orientée dans la bonne direction ».
Elle a noté que l’âge de base et le respect du calendrier de port influençaient les performances. « Les enfants qui n’enlevaient pas leurs lunettes pour les tâches de vision de près étaient considérés comme conformes », a déclaré Laughton.
Selon l’étude, la modification moyenne de la longueur axiale par rapport à la valeur initiale était de 0,59 ±0,04 mm dans le groupe test et de 0,72 ±0,04 mm dans le groupe témoin (P = 0,018), et la modification moyenne de la RES par rapport à la valeur initiale était de -0,83 ±0,09 D dans le groupe test et de -1,16 ±0,09 D dans le groupe témoin (P = 0,0084).
Dans le sous-groupe des enfants de 6 et 7 ans (n = 48), la variation moyenne de la longueur axiale par rapport au départ était de 0,71 ±0,07 mm dans le groupe test et de 1,03 ±0,07 mm dans le groupe témoin, et la variation moyenne de la RES était de -0,89 ±0,17 D dans le groupe test et de -1,73 ±0,18 D dans le groupe témoin.
La différence des moyennes par rapport au niveau de référence pour la longueur axiale et la RES était statistiquement et cliniquement significative, ont rapporté les chercheurs.
« Les lentilles de la technologie de l’optique de diffusion sont sûres et efficaces, a déclaré Laughton. Cependant, sur la base des performances initiales à 12 mois, nous nous attendions à des niveaux d’efficacité plus élevés que ceux que nous avons observés après 3 ans. »
En utilisant les données de l’étude d’extension, les chercheurs peuvent prédire ce qui pourrait se passer après la période initiale de trois ans, a déclaré Mme Laughton.
« Il y a un léger aplatissement de la courbe, a-t-elle déclaré. Nous n’avons pas constaté une réduction de la progression de la myopie; il semble que la progression s’accélère à un rythme plus important que prévu.
« Alors, que s’est-il passé après nos 12 mois initiaux et avant l’étude d’extension ? a-t-elle poursuivi. Il s’est passé quelque chose avec notre groupe de contrôle. Cette période tombait en effet pendant la pandémie. Mais si nous oublions cela, nous pouvons voir des résultats prometteurs. »
Les données au point de 6 mois représentent environ la moitié de ce que les chercheurs ont vu au cours des 12 premiers mois de l’étude d’extension, a déclaré Laughton.
« Nous nous attendons à ce que ces lignes se maintiennent pour le point de données à 48 mois, a-t-elle dit. Mais que s’est-il passé ? Lorsque nous pensons aux enfants, en particulier aux États Unis, nous avons constaté une baisse des notes et des résultats en lecture. Peut-être que ces enfants ne passent pas autant de temps à étudier ou à travailler à proximité. Nous avions un bon mélange de lieux urbains et ruraux. La plupart de nos enfants avaient accès à une cour ou à un parc; peut-être passent-ils plus de temps à l’extérieur. »
« Je suis satisfait de notre groupe de contrôle, a déclaré Laughton. Il n’y a pas beaucoup de progression myopique. Mais cela a eu un impact sur l’étude de l’effet de notre traitement. »
Elle a dit qu’elle présentera les données sur 48 mois lors de la réunion de l’académie l’année prochaine.
Source : https ://www.healio.com/news/optometry/20221111/sightglass-spectaclelenses-reduced-axial-length-in-children-after-3-years# :~ :text=SAN%20 DIEGO%20%E2%80%94%20Diffusion%20Optics%20Technology,study%20 presented%20at%20Academy%202022.

49 OPTOMÉTRISTE | MAI | JUIN 2023
Les risques et les avantages du contrôle de la myopie
Objectif : La prévalence de la myopie augmente dans le monde entier, ce qui stimule l’intérêt pour les méthodes permettant de ralentir sa progression. La principale justification du ralentissement de la progression de la myopie est de réduire le risque de perte de la vision par des caractéristiques pathologiques oculaires menaçant la vue à un âge avancé. Cet article analyse si les avantages potentiels du ralentissement de la progression de la myopie de 1 dioptrie (D) justifient les risques potentiels associés aux traitements.
Méthodes : Tout d’abord, on résume les risques connus associés aux diverses méthodes de contrôle de la myopie, en mettant l’accent sur le port de lentilles de contact. Sur la base des données disponibles, on fait une estimation du risque de déficience visuelle et des années prédites de déficience visuelle pour une gamme de niveaux d’incidence. Ensuite, on examine le risque accru d’affections potentiellement dangereuses pour la vue associé à différents niveaux de myopie. Enfin, on crée un modèle du risque de déficience visuelle en fonction du niveau de myopie, et on examine les années de déficience visuelle associées à différents niveaux de myopie ainsi que les années de déficience visuelle prédites.
Enfin, on développe un modèle du risque de déficience visuelle en fonction du niveau de myopie et on fait une estimation des années de déficience visuelle associées à différents niveaux de myopie et des années de déficience visuelle qui pourraient être évitées avec des niveaux réalisables de contrôle de la myopie.
Résultats : En supposant une incidence de kératite microbienne comprise entre 1 et 25 pour 10 000 patients-années et que 15 % des cas entraînent une perte de vision, on peut conclure qu’il faut exposer entre 38 et 945 patients à 5 ans de port pour produire 5 ans de perte de vision.
Chaque 1 D supplémentaire de myopie est associé à une augmentation de 58 %, 20 %, 21 % et 30 % du risque de maculopathie myopique, de glaucome à angle ouvert, de cataracte sous-capsulaire postérieure et de décollement de la rétine, respectivement. Les années moyennes prédites de déficience visuelle vont de 4,42 ans pour une personne ayant une myopie de e3 D à 9,56 ans pour une personne ayant une myopie de e8 D, et une réduction de 1 D réduirait ces années de 0,74 et 1,21 an, respectivement.


Conclusions : Les avantages potentiels du contrôle de la myopie l’emportent sur les risques : le nombre de personnes à traiter pour prévenir 5 ans de déficience visuelle se situe entre 4,1 et 6,8, tandis que moins d’une personne sur 38 subira une perte de vision suite au contrôle de la myopie.
Source : https ://www.aaojournal.org/article/S0161-6420 (21) 00326-2/fulltext
Vision pédiatrique et médias numériques : une mauvaise combinaison
Les recherches indiquent que l’utilisation excessive de la technologie a des effets négatifs sur la vue.
La santé oculaire pédiatrique est importante dans tous les aspects de la vie et du développement d’un enfant. La vision n’est pas simplement une question de clarté; c’est un système fonctionnel qui, idéalement, est flexible et efficace. Il s’agit d’une entrée sensorielle primaire qui influence l’apprentissage, le développement, le comportement et l’endurance de l’enfant, et qui est biologiquement inadaptée aux exigences excessives de la vision de près de la culture numérique dans laquelle se trouvent les enfants.
Les familles d’aujourd’hui doivent gérer un assaut de médias numériques dans la vie des enfants, notamment les contenus télévisés, les téléphones cellulaires, les tablettes et les ordinateurs. Les dispositifs de médias numériques peuvent élargir les outils de communication, fournir un accès facile et immédiat à l’information, et s’adapter aux forces et aux défis des enfants. Mais les avantages de la technologie s’accompagnent de risques. L’exposition actuelle aux médias numériques a un effet profond sur les enfants. Nous n’avons jamais eu une génération de nourrissons et de tout-petits avec une telle augmentation de la demande visuelle proche et de la stimulation sensorielle provoquée par les téléphones portables et les tablettes avec lesquels ils interagissent quotidiennement. Ces exigences excessives auxquelles sont soumis les enfants de tous âges se traduisent par un système visuel fatigué et incapable de fonctionner efficacement.
Common Sense Media a signalé en 2021 que l’utilisation des médias de divertissement approchait les 9 heures par jour chez les adolescents (13-18 ans) et les 6 heures par jour chez les préadolescents (8-12 ans). Pour les préadolescents et les adolescents, l’utilisation des médias sur écran a augmenté de 17 % depuis le début de la pandémie COVID-19. Ces statistiques sont stupéfiantes et conduisent souvent les parents à se sentir impuissants face aux habitudes de leurs enfants en matière de temps d’écran.
L’utilisation excessive des médias numériques peut également conduire les enfants à devenir dépendants des appareils, des médias sociaux et des jeux. Il s’agit de conséquences très réelles et graves qui sont constatées dans la population pédiatrique.
En 2018, l’Organisation mondiale de la santé a ajouté le trouble du jeu à la Classification internationale des maladies, onzième révision. Les études d’IRM révèlent que les dépendances aux jeux et aux téléphones intelligents modifient la structure physique du cerveau d’une manière parallèle aux dépendances aux drogues et aux jeux d’argent.
50 OPTOMÉTRISTE | MAI | JUIN 2023
Effet du temps d’écran sur l’efficacité visuelle
En tant qu’optométristes, nous savons que la puissance du système d’accommodation (mise au point) dépend de l’âge. L’utilisation excessive de ce système sans une hygiène visuelle appropriée use la force et l’endurance de l’accommodation.
Dans les cabinets d’optométrie d’aujourd’hui, de nombreux patients reçoivent un diagnostic d’insuffisance d’accommodation en raison d’un monde où les exigences numériques sont excessives. Ces exigences révèlent des résultats cliniques d’accommodation considérablement réduits, notamment une acuité visuelle réduite et variable et la détection de faibles quantités d’astigmatisme contre la règle. La reconnaissance de ces résultats cliniques, en plus de l’asthénopie, des maux de tête et de la fatigue qui accompagnent les problèmes d’accommodation, est essentielle pour traiter correctement les patients.
Outre le système d’accommodation, le système de vision binoculaire, c’est-à-dire le processus par lequel deux yeux travaillent ensemble pour former une seule image, est soumis à un stress inhérent. Le développement de la vision binoculaire commence dans le cerveau et il existe des préoccupations neurologiques valables selon lesquelles l’activité sur écran stimule le traitement visuel plus fortement que même les systèmes de traitement sensoriel, interrompant ainsi le développement de la vision binoculaire.
Dans nos cabinets, nous observons des dysfonctions de la vision binoculaire sous la forme d’un excès de convergence (avoir une posture éso de près) et d’une insuffisance de convergence (avoir une posture exo de près importante) qui sont influencées par le temps excessif passé devant un écran par les jeunes d’aujourd’hui. Une distance de vision rapprochée lors de la consultation d’appareils numériques influence également l’assaut de symptômes visuels.
Des études cliniques révèlent que la distance d’observation rapprochée qui accompagne souvent l’utilisation d’appareils numériques portatifs devient encore plus rapprochée en cas d’utilisation prolongée. L’une des principales plaintes des parents qui amènent leurs jeunes enfants pour un examen de la vue est l’observation de la distance à laquelle l’enfant regarde son téléphone portable ou sa tablette. Plus la distance d’observation est proche, et plus l’utilisation est excessive, plus le nombre de diagnostics de problèmes de vision accommodative et binoculaire et des symptômes visuels qui les accompagnent augmente.
Il existe plusieurs options de traitement pour les problèmes de vision accommodative et binoculaire. Les lunettes de lecture et les lunettes à double foyer sont prescrites pour soutenir les systèmes visuels et réduire les symptômes visuels. La thérapie visuelle est une autre option de traitement des problèmes de vision accommodative et binoculaire, qui vise à améliorer l’efficacité de tous les aspects de la fonction visuelle.
La progression de la myopie est influencée par des facteurs génétiques et environnementaux, mais l’utilisation des médias numériques a également une influence sur la progression du développement de la myopie.
L’accent mis aujourd’hui sur le traitement de la myopie, avec pour objectif de réduire la progression, oblige l’optométriste à examiner les habitudes de ses patients en matière de temps passé devant l’écran. Nous savons qu’il existe des comportements modifiables qui influencent le développement de la myopie.

La recherche scientifique démontre qu’une exposition accrue à l’extérieur réduit le développement de la myopie4. La cause exacte de ce phénomène n’est pas entièrement comprise, mais le temps passé à l’extérieur contribue probablement à limiter les demandes de près et aura un impact plus positif sur le système visuel.
Un article paru dans le JAMA en janvier 2021 indique que « le confinement à domicile dû à [COVID-19] semble être associé à un changement myopique substantiel chez les enfants »5. Cette observation démontre l’effet d’un temps d’écran excessif sur le développement de la myopie.
Effet du temps d’écran sur le développement de l’enfant
Au-delà de l’influence qu’ils exercent sur le système visuel de l’enfant, les médias numériques ont également un impact important sur le développement global de notre population pédiatrique. Nous savons que l’exposition précoce aux médias numériques a un impact négatif sur le développement intellectuel, social et émotionnel de l’enfant. L’utilisation élevée des médias numériques entraîne plus particulièrement une diminution de la cognition et des compétences linguistiques. En outre, la façon dont les enfants utilisent les médias numériques a une forte corrélation avec leur santé mentale.
Un décollement de la rétine peut résulter du traitement par gouttes de la presbytie
Dans les deux cas inclus ci-dessous, l’utilisation de la pilocarpine topique a précédé l’événement oculaire grave.
Depuis la récente approbation par la FDA de Vuity, le premier collyre commercialisé pour traiter la presbytie, et d’autres suivront, les patients et les médecins manifestent un intérêt croissant pour la valeur clinique de son ingrédient actif, la pilocarpine. La nouvelle utilisation de ce médicament ophtalmique de longue date attire de nombreux utilisateurs et prestataires en raison de son potentiel pour éliminer le besoin de lunettes ou de lentilles de contact. Bien que le traitement se soit avéré sûr et efficace dans divers essais cliniques, la recherche doit continuer à étudier les risques éventuels et les indications cliniques de l’utilisation topique de la pilocarpine.
Une récente série de cas multicentriques a identifié une association possible entre le risque de décollement de la rétine et l’utilisation de collyres à la pilocarpine. L’équipe de recherche a identifié deux cas de décollement de la rétine chez deux patients utilisant la pilocarpine topique comme traitement de la presbytie. Ils ont émis l’hypothèse que le médicament pouvait provoquer une migration du cristallin antérieur, ce qui pourrait transmettre des forces de traction sur la rétine.
51 OPTOMÉTRISTE | MAI | JUIN 2023
Le premier patient, un homme de 47 ans presbyte, utilisait des gouttes de pilocarpine 1,25 % depuis un mois avant de se présenter en se plaignant de flashs et de flotteurs bilatéraux qui s’intensifiaient depuis quelques jours après le début du traitement. Lors de l’examen dilaté, le médecin a observé « un décollement de la rétine inférotemporale dans l’œil droit avec une déchirure rétinienne associée inférotemporale. » En outre, il a noté que l’œil gauche du patient « présentait un décollement de la rétine dans le quadrant supérieur avec une déchirure en fer à cheval associée à 12 heures. »
Le second patient, un presbyte de 46 ans, s’est présenté dans une clinique de la rétine cinq semaines après avoir commencé à prendre de la pilocarpine à 1,25 %, se plaignant d’un défaut du champ visuel nasal qui avait commencé à affecter sa vision centrale. Les chercheurs ont noté que l’examen dilaté de ce patient a montré « un décollement de la rétine supérieure de 11 à 3 heures avec un liquide sous-rétinien s’étendant dans la macula. »
Sur la base des informations tirées de ces trois cas de décollement de la rétine suite à l’utilisation de la pilocarpine topique, les chercheurs ont suggéré que le lien entre les deux devrait être exploré dans des études futures. En outre, ils recommandent de dépister les patients pour déterminer s’ils présentent un risque plus élevé de décollement de la rétine avant de prescrire la pilocarpine pour la presbytie, ainsi que d’informer les patients sur les symptômes de déchirure ou de décollement de la rétine. Al-khersan H., Flynn H. W. Jr., Townsend J. H. Retinal detachments associated with topical pilocarpine use for presbyopia. Am J Ophthalmol. May 20, 2022. [Epub ahead of print].
Source : https ://www.reviewofoptometry.com/news/article/retinal-detachmentmay-result-from-presbyopia-drop-treatment# :~ :text=A%20recent%20 multicenter%20case%20series,topical%20pilocarpine%20as%20presbyopia%20treatment.

Contrôle de la myopie avec des lentilles de contact multifocales souples –suivi de 18 mois
Objectif : L’étude visait à établir les résultats des lentilles de contact multifocales (LCMF) (Multistage + 1,50 D et Proclear + 3,00 D) sur la progression de la myopie et l’allongement de la longueur axiale sur une période de 18 mois.

Bien qu’aucun lien de causalité ne puisse être déterminé entre le nouveau traitement de la presbytie et les cas de décollement de la rétine, les chercheurs ont souligné que « l’incidence peu de temps après le début du traitement est préoccupante. Ils poursuivent : En particulier, l’apparition d’un décollement de la rétine bilatéral et simultané chez le premier patient qui est devenu symptomatique avec des flashs et des flotteurs trois jours seulement après avoir commencé à prendre les gouttes topiques de pilocarpine 1,25 % justifie une enquête plus approfondie sur les décollements de la rétine comme effet indésirable possible du traitement. »
La pilocarpine est un miotique, une classe de médicaments soupçonnée depuis longtemps d’exposer les patients à un risque plus élevé de décollement de la rétine, en particulier chez ceux qui souffrent de myopie ou de dégénérescence rétinienne. En fait, l’étiquette de la FDA pour la pilocarpine 1,25 % comprend un avertissement sur un risque possible de décollement de la rétine dû aux miotiques chez « les personnes sensibles et celles qui ont une maladie rétinienne préexistante », bien qu’aucun dépistage ou examen spécial ne soit actuellement requis avant de délivrer une ordonnance à ces patients.
Méthodes : Trente écoliers myopes (5 hommes et 25 femmes) âgés de 13 à 15 ans ont été assignés de manière aléatoire au port d’une lentille de contact simple vision (LCSV), d’une LCMF Multistage + 1,50 D ou d’une LCMF Proclear +3,00 D pendant 1½ an selon un plan à double insu. La réfraction cycloplégique, la courbure cornéenne et la longueur axiale ont été mesurées.
Résultats : La progression de la myopie a été contrôlée de 38,6 % et 66,6 % chez les enfants portant les lentilles LCMF Multistage + 1,50 D et Proclear +3,00 D, respectivement, par rapport aux enfants portant la LCSV sur une période de 18 mois. En termes d’élongation axiale, cette étude a constaté un contrôle de 31,1 % et 63,2 % de l’élongation axiale sur 18 mois de traitement par rapport au groupe LCSV. Aucune différence statistiquement significative de la courbure cornéenne n’a été trouvée entre la première et la dernière visite pour les trois groupes (LCSV, P = 0,90; Multistage +1,50 LCMF, P = 0,78, et Proclear +3,00 LCMF, P = 0,05).
Conclusion : Il a été révélé que la LCMF Proclear +3,00 D entraînait un développement plus lent de la myopie et de l’élongation axiale chez les écoliers myopes. Les LCMF avec des puissances d’addition élevées pourraient avoir un effet plus efficace sur la progression de la myopie par rapport aux puissances d’addition modérées.
52 OPTOMÉTRISTE | MAI | JUIN 2023
Modifications de l’allongement axial relatif lors des visites de suivi à 6, 12 et 18 mois chez des écoliers myopes.

Évolution de la progression relative de la myopie lors des visites de suivi à 6, 12 et 18 mois chez des écoliers myopes.
Source : https ://www.saudijophthalmol.org/article.asp ?issn=1319-4534;year=2021; volume=35;issue=4;spage=325;epage=331;aulast=Raffa

53 OPTOMÉTRISTE | MAI | JUIN 2023 Figure 1 0.5 0.4 0.3 0.2 0.1 0 -0.1 -0.2 Longueur axiale Temps (mois) Départ 6 m 12 m 18 m Changements longueur axiale (mm) SVCL Multistage +1.50D Proclear +3.00D Temps (mois) SVCL Multistage +1.50D Proclear +3.00D 0.2 0.1 0 -0.1 -0.2 -0.3 -0.4 -0.5 -0.6 -0.7 -0.8 Progression
myopie Départ 6 m 12 m 18 m Changements myopie (D)
de la
Figure 2 0.5 0.4 0.3 0.2 0.1 0 -0.1 -0.2 Longueur axiale Temps (mois) Départ 6 m 12 m 18 m Changements longueur axiale (mm) SVCL Multistage +1.50D Proclear +3.00D Temps (mois) SVCL Multistage +1.50D Proclear +3.00D -0.6 -0.7 -0.8 Départ 6 m 12 m 18 m Changements
half-page ad_registration.indd 1 2023-03-30 3:32:43 PM
OFFRE PRÉVENTE CELIAPP
VOUS AVEZ BIEN HÂTE D’OUVRIR UN CELIAPP, ALORS QUE LA DATE DE SA MISE EN PLACE OFFICIELLE DEMEURE INCERTAINE ?
Profitez de l’option prévente CELIAPP Fonds FMOQ1 et démarrez votre épargne dès aujourd’hui.
Une fois le CELIAPP Fonds FMOQ disponible, vous pourrez y transférer les montants accumulés à titre de cotisation2
INFORMEZ-VOUS !
MONTRÉAL : 514 868-2081 ou 1 888 542-8597
QUÉBEC : 418 657-5777 ou 1 877 323-5777

info@fondsfmoq.com | FONDSFMOQ.COM
1 L’ouverture d’un compte dans le cadre de l’offre prévente CELIAPP ne constitue pas une adhésion au CELIAPP.
2 L’adhésion au CELIAPP Fonds FMOQ sera possible uniquement si vous remplissez encore les conditions d’admissibilité au moment de signer la demande d’adhésion. Une fois votre CELIAPP ouvert, vous pourrez y transférer votre placement fait dans le cadre de la prévente CELIAPP (8 000 $ maximum), lequel pourrait avoir varié entretemps. Par ailleurs, vous pourriez être assujetti à diverses incidences fiscales. Votre conseiller pourra vous renseigner à cet égard.
EN PARTENARIAT AVEC
CELIAPP, un nouveau coup de pouce pour les premiers acheteurs
Le compte d'épargne libre d’impôt pour l’achat d’une première propriété (CELIAPP) est un nouvel outil d’épargne qui vous permettra, dès 2023, d’accumuler de l’argent en vue d’acquérir une habitation.
Il est possible d’ouvrir plus d’un compte CELIAPP, mais le montant total de tous vos comptes doit respecter les plafonds annuels et à vie. Un impôt de 1 % s’appliquera sur les cotisations versées en trop.
Au Canada, l’indice d’accessibilité à la propriété se dégrade. C’est pourquoi le gouvernement fédéral a entrepris la mise en place du CELIAPP, un compte destiné aux futurs acheteurs d’une première habitation. Il offre une déduction fiscale lors de la cotisation, puis un retrait libre d’impôt à l’achat d’une propriété.
Admissibilité
Pour bénéficier du CELIAPP, vous devez être âgé d’au moins 18 ans. Vous disposez ensuite de 15 ans pour utiliser vos fonds. Après le 31 décembre de l’année du 15e anniversaire de l’ouverture du compte, votre CELIAPP doit être fermé ou transféré. Il doit aussi l’être si vous atteignez l’âge de 71 ans.
Seuls les résidents canadiens peuvent se prévaloir du CELIAPP. Si vous ouvrez un compte et que vous émigrez ailleurs par la suite, vous n’aurez pas le droit d’effectuer un retrait admissible. Vous serez assujetti à une retenue d’impôt sur tout retrait.
Le CELIAPP s’adresse strictement aux acheteurs d’une première habitation. Pour vous qualifier au régime, vous ne devez pas avoir habité votre propriété (ou celle de votre conjoint) pendant la partie de l’année qui précède l’ouverture de votre compte ou les quatre années civiles précédentes. Cette modalité doit également être respectée au moment du retrait afin que celuici soit libre d’impôt.

Cotisations
Le CELIAPP entre en vigueur le 1er avril 2023. Vous avez le droit de cotiser la totalité du plafond annuel de 2023 dès l’ouverture de votre compte. La cotisation maximale est fixée à 8 000 $ par année et à 40 000 $ à vie. Ainsi, en y versant le maximum permis annuellement, vous atteindrez le plafond de cotisation en cinq ans.
Dans l’éventualité où vous ne pourriez pas épargner le maximum pendant une année donnée, vous pourrez reporter vos cotisations inutilisées à l’année suivante. Il sera permis de cotiser un maximum de 16 000 $ par année, incluant le rattrapage des cotisations inutilisées de l’année antérieure. Par exemple, si vous versez 5 000 $ à un CELIAPP en 2023, il restera 3 000 $ à additionner aux 8 000 $ permis en 2024, pour une cotisation totale de 11 000 $ cette année-là. Vos droits de cotisation s’accumuleront uniquement après l’ouverture de votre compte.
Placements admissibles
Dans un CELIAPP, vous pouvez détenir un large éventail de placements, en suivant les mêmes règles qui s’appliquent à d’autres régimes enregistrés, comme le CELI. Fonds communs de placement, titres négociés en Bourse, obligations gouvernementales, obligations de sociétés et certificats de placement garanti sont tous acceptés. Il y est toutefois interdit d’effectuer des placements dans des entités avec lesquelles vous avez un lien de dépendance, dans les immeubles, les actions de sociétés privées et les parts de sociétés en nom collectif.

55 OPTOMÉTRISTE | MAI | JUIN 2023
CHRONIQUE FONDS FMOQ
Impôt et CELIAPP : les avantages fiscaux
Avec le CELIAPP, vous pouvez demander une déduction d’impôt pour vos cotisations pour l’année civile où elles ont été versées ou encore les déduire au moment opportun, par exemple au cours d’une année d’imposition ultérieure pendant laquelle vous avez un revenu plus élevé. En tant que titulaire d’un CELIAPP, vous êtes le seul contribuable autorisé à demander des déductions pour vos cotisations. Si vous cotisez aussi au compte de votre conjoint, vous ne pouvez pas demander de déduction pour ce montant.
Vous n’avez aucun impôt à payer sur le revenu de placement généré dans votre CELIAPP ni sur les retraits admissibles au moment d’acheter votre maison. Ces derniers n’ont donc aucune incidence sur votre revenu imposable ni sur votre admissibilité aux prestations ou crédits gouvernementaux, comme l’Allocation canadienne pour enfants. Tout comme pour le CELI, les pertes en capital subies dans le régime ne sont pas déductibles.
Retraits non imposables
Au moment du retrait du CELIAPP, vous devez toujours vous qualifier à titre de premier acheteur et avoir, en plus, une entente écrite d’achat ou de construction d’une habitation avant le 1er octobre de l’année suivant celle du retrait. Par exemple, si vous voulez retirer vos fonds en décembre 2024, vous devez détenir une promesse d’achat acceptée pour une transaction avant le 1er octobre 2025. Vous devez également avoir l’intention d’occuper cette propriété à titre de résidence principale dans l’année suivant l’achat (ou la construction). Ces conditions doivent être remplies pour que votre retrait soit non imposable.
Contrairement à ce qui prévaut avec l’utilisation des REER au titre du régime d’accession à la propriété (RAP), les retraits du CELIAPP n’ont pas à être remboursés par la suite. De plus, vos fonds peuvent être retirés en une seule ou en plusieurs fois.
Si vous faites un retrait non admissible, ce dernier sera inclus dans votre revenu imposable. L’institution financière où vous détenez votre compte devra percevoir une retenue d’impôt. De plus, un retrait non admissible ne rétablira pas vos plafonds de cotisation.
RAP ou CELIAPP : des différences
Le RAP est toujours en vigueur et demeurera disponible conformément aux règles existantes. Les deux régimes (RAP et CELIAPP) possèdent chacun leurs atouts. Pour en profiter pleinement, vous avez avantage à les combiner. De cette manière, vous bonifierez considérablement votre mise de fonds.
De prime abord, le CELIAPP propose un plafond plus élevé que le RAP, ce qui le rend très intéressant. En y cotisant le maximum, vous pourrez en retirer 40 000 $, plus votre rendement, dans cinq ans. Avec le RAP, impossible de retirer plus de 35 000 $.
Le grand intérêt du CELIAPP est aussi attribuable au fait que vous n’avez jamais à rembourser les fonds retirés, un autre élément qui le distingue du RAP. En effet, en utilisant vos REER, vous devez les rembourser par la suite. En résumé, le CELIAPP donne droit à une déduction fiscale, n’est pas imposable au retrait et ne doit pas être remboursé.
En revanche, le RAP offre l’avantage de devenir propriétaire dans un délai beaucoup plus court : nul besoin d’attendre cinq ans pour verser le maximum admissible, l’acheteur doit juste s’assurer que les cotisations versées à un REER y demeurent au moins 90 jours avant de retirer les sommes à titre de RAP. C’est une solution idéale pour un premier acheteur ayant déjà suffisamment de liquidités et qui ne souhaite pas attendre cinq ans pour accumuler le maximum permis dans le CELIAPP.
Les transferts du REER vers le CELIAPP sont possibles sans conséquence fiscale. Il faut tout de même respecter les limites de cotisation du CELIAPP. Notez également que ce transfert de fonds ne vous donne pas droit à une déduction d’impôt et ne rétablit pas vos droits de cotisation REER.
Et si vous n’utilisez pas votre CELIAPP ?
Dans l’éventualité où la vie vous amène ailleurs et que vous n’effectuez pas de retrait admissible dans les 15 années suivant l’ouverture du compte, votre épargne n’est pas perdue. Les fonds peuvent être transférés à votre REER de manière non imposable (ou FERR, selon votre âge). Ils seront toutefois assujettis à l’imposition au moment du retrait, comme pour le REER. Vous pouvez aussi choisir de retirer vos fonds d’un coup et vous imposer sur le montant retiré.
En cas de rupture d’union ou de décès
Dans le cadre d’un règlement à la suite de la rupture d’un mariage (ou d’une union de fait) ou du décès, un montant peut être transféré directement du CELIAPP d’un des conjoints au CELIAPP (ou au REER) de l’autre, à condition de satisfaire aux critères d’admissibilité pour ouvrir un compte.
Dans le cas où le conjoint survivant n’a pas le droit d’ouvrir un CELIAPP, les fonds peuvent être transférés à son REER (ou FERR), ou bien être retirés de manière imposable. Si le bénéficiaire de votre CELIAPP est une personne autre que votre conjoint, par exemple votre enfant, les fonds doivent être retirés et le montant sera inclus dans son revenu aux fins de l’impôt.
Conclusion
Les avantages du CELIAPP sont indéniables. Cependant, il est encore plus pertinent de combiner le REER et le CELIAPP pour bénéficier d’un maximum d’avantages fiscaux. N’hésitez pas à consulter des professionnels afin de trouver la stratégie qui vous convient le mieux.
56 OPTOMÉTRISTE | MAI | JUIN 2023
ŒIL SANTÉ MD
Des cliniques modernes et à la fine pointe de la technologie pour mieux vous servir
TRAITEMENTS OCULAIRES SPÉCIALISÉS
• Cataracte
• Dégénérescence maculaire
• Maladies rétiniennes
• Glaucome
• Maladies de la cornée
www.oeilsantemd.com
CLINIQUE DÉCARIE
8000 boul. Décarie, bureau 440 Montréal (Québec)
H4P 2S4
Tél. : 514-340-3937
infodecarie@oeilsantemd.com
CLINIQUE CENTRE-VILLE DE MONTRÉAL
625 av. du Président-Kennedy, bureau 1503, Montréal (Québec)
H3A 1K2
Tél. : 514-849-9215
infopresidentkennedy@oeilsantemd.com
CLINIQUE POINTE-CLAIRE

Méga Centre des Sources
2415A rte Transcanadienne, Pointe-Claire (Québec)
H9R 5Z5
Tél. : 514-340-3937
infopointeclaire@oeilsantemd.com
EN SOINS
LES PLUS HAUTS STANDARDS
OPHTALMIQUES!
L’assurance frais de bureau

L’assurance frais généraux représente donc une garantie importante, voire essentielle, pour protéger votre compagnie. Elle soulage l’adhérent de certaines de ses obligations financières et lui permet de se concentrer sur son rétablissement.
Distinction entre assurance invalidité et assurance frais généraux de bureau
L’assurance invalidité
Avez-vous déjà songé à ce qu’il adviendrait de votre clinique si vous deveniez invalide ?
L’objectif de l’assurance frais généraux de bureau : préserver la viabilité de votre cabinet en cas d’invalidité.
L’assurance frais généraux de bureau s’adresse principalement aux travailleurs autonomes et aux propriétaires de cliniques, dont la survie de l’entreprise dépend essentiellement de leur capacité à travailler.
Avec cette protection, les dépenses nécessaires au bon fonctionnement de votre entreprise telles que :
� loyer;
� électricité;
� taxes;
� salaire des employés;
� honoraires professionnels;
� primes d’assurances commerciales, seront honorées.
Votre compagnie continuera son activité normale et vous ne craindrez pas de perdre votre personnel qualifié pour défaut de paiement, ou encore, votre clientèle en raison de contrats non honorés.
A pour but de vous assurer un revenu personnel afin de couvrir vos dépenses quotidiennes pour votre subsistance et celle de votre famille.
L’assurance frais généraux de bureau
Vous permet de maintenir l’activité de votre entreprise en cas d’invalidité suite à un accident ou une maladie.
À
assurance
Pour plus d’information sur l’assurance frais généraux ou l’assurance invalidité, communiquez avec votre conseiller. Ce dernier se fera un plaisir de vous orienter selon vos besoins vers des solutions adaptées à votre situation financière.

58 OPTOMÉTRISTE | MAI | JUIN 2023 CHRONIQUE LUSSIER 1 877 543-2960
Ainsi, nul besoin de toucher à vos économies ou encore à votre prestation d’assurance invalidité. De plus, sachez que les primes de cette police sont déductibles à titre de dépenses d’affaires.
noter que cette
n’affecte aucunement le montant des prestations d’invalidité, elle en est plutôt un complément idéal.
Strøm spa nordique
Planifiez votre visite au Strøm en vous procurant une carte-cadeau à prix réduit et profitez de rabais exclusifs. Offrez-vous un moment de détente sans pareil. Visitez la page d’offres exclusives comprenant des rabais, des lectures favorisant l’équilibre et des concours mensuels : stromspa.com/partenaires
Optimum Paiement
• Visa standard : 1,25 %
• Mastercard standard : 0,92 %
• Interchange-Plus : 0,075 %
• Interac : 0,03 $
• Location terminal : 25 $ par mois
• Aucuns frais d’administration
• Aucuns frais annuels
• Aucuns frais d’installation
• Aucuns frais d’autorisation
• Nous payons vos frais d’annulation jusqu’à concurrence de 500 $ optimumpayment.ca
TELUS Santé
Notre solution de demandes de règlement en ligne est un moyen simple et sécuritaire de facturer directement un nombre grandissant d’assureurs au nom de vos patients.
Xacte
Votre facturation RAMQ sera réglée en seulement quelques clics avec notre outil Web intégré.


CS Paiement
Nos terminaux Clover Mini et Clover Flex vous permettent d’obtenir le meilleur des deux mondes, soit gérer votre entreprise et accepter les paiements à partir du même système.

Gestion d’Achats Ram Inc. Économisez en achetant vos fournitures informatiques directement auprès du principal distributeur québécois.



Nautilus Plus
Profitez d’un rabais sur un abonnement annuel dans les centres Nautilus Plus. Pour s’inscrire, simplement vous présenter dans l’une des succursales avec une preuve de membre de l’AOQ.

La plateforme virtuelle d’entraînement et de nutrition ULTIMEFIT est aussi offerte à prix préférentiel.
Découvrez les nombreuses offres sur le site aoqnet.qc.ca, section membres.

59
L’AOQ vous invite à découvrir les nombreuses offres ainsi que les rabais accordés à ses membres.
Assurance automobile : la fièvre du printemps
Remplacement de véhicule
Voici un exemple où votre assurance automobile dépasse la « notion » de véhicule désigné au contrat. Votre assurance actuelle couvre un véhicule de catégorie compact, de l’année 2018. Vous détenez les couvertures d’assurance de la responsabilité civile, la collision, le feu, le vol et le vandalisme. Avec l’arrivée du printemps, vous décidez de changer votre automobile pour un modèle intermédiaire de l’année qui vous coûte 40 000 $. Votre nouveau véhicule vous est livré à la fin de la semaine. Le lendemain, vous êtes impliqué dans un accident et votre nouvelle acquisition subit des dommages pour le tiers de son coût d’achat. Soudainement, vous êtes inquiet, car vous réalisez que vous avez négligé de communiquer avec votre courtier d’assurance avant de prendre livraison de votre voiture neuve.

Modification de l’assurance automobile
Heureusement, ce genre de situation est prévu dans la police d’assurance automobile puisque les couvertures souscrites pour l’ancien véhicule s’étendent au nouveau véhicule à certaines conditions :
� Vous avez 14 jours à partir de la prise de possession pour aviser votre courtier ou votre assureur;
� Vous vous engagez, s’il y a une différence de prime entre les modèles, à payer la surprime;
� Vous devez convenir du transfert automatique des garanties en vigueur au moment de la substitution d’automobile.

Dans l’exemple précité, le propriétaire de la nouvelle automobile n’a pas à s’en faire puisque son ancien véhicule 2018 bénéficiait de toutes les garanties, et que celles-ci sont par conséquent automatiquement transférées. Alors, il ne vous reste qu’à faire un appel à votre courtier, le lundi matin, pour l’aviser du sinistre en même temps que du changement de véhicule.
Le nouveau propriétaire s’en tire bien dans ce cas : les dommages à sa nouvelle acquisition sont couverts et une prime additionnelle devra être acquittée. Malheureusement, il n’en est pas toujours ainsi.
Absence de protection collision
Pour certains, l’accident de la fin de semaine tourne parfois au cauchemar puisque l’ancienne automobile n’était assurée que pour la responsabilité civile. Par conséquent, la demande d’indemnisation pour les dommages au nouveau véhicule du printemps ne peut être recevable puisqu’il n’y a pas de protection « collision » dans le transfert automatique des couvertures. Les concessionnaires automobiles vérifient les couvertures d’assurance dans les cas de véhicules loués, puisqu’ils exigent une confirmation écrite des protections accordées avant d’autoriser la livraison : ils peuvent ainsi s’assurer d’une couverture complète, des franchises applicables et, surtout, de l’ajout de l’avenant 5A pour véhicules loués ou faisant l’objet d’un crédit-bail. Cet avenant leur permet d’être nommés sur la police d’assurance automobile au même titre que l’assuré lui-même.
Saviez-vous que…
Communiquer avec son courtier plusieurs jours avant de prendre le volant de sa nouvelle automobile est la meilleure chose à faire ?
60 OPTOMÉTRISTE | MAI | JUIN 2023 CHRONIQUE LUSSIER 1 877 543-2960
Il y a des jours ces temps-ci qui ont des allures de printemps. Si vous avez l’idée de changer de voiture, vous auriez intérêt à réviser votre assurance automobile.
Profitez de nos rabais exclusifs
Vous renouvelez votre police d’assurance dans moins de 90 jours ?
Automobile

Habitation
Bateau
Motoneige
Véhicule récréatif
Appelez-nous pour une soumission dès aujourd’hui !
Cabinet de services financiers
1 877 543-2960
Lussier.co/AOQ
Appliquez le Code Promo
Z00042

61 OPTOMÉTRISTE | MAI | JUIN 2023
classées
VERCHÈRES
Temps plein / partiel / permanent Clinique visuelle de Verchères optoplus.com
Docteure Johanne Roy, optométriste 450 583-6644 optojroy@yahoo.ca
Vous cherchez un environnement de travail agréable qui répond à vos besoins ? La clinique visuelle de Verchères, bien établie depuis 33 ans, est à la recherche d’un(e) optométriste motivé(e) pour se joindre à son équipe dynamique. En plus d’une clientèle fidèle et variée, la clinique est fermée la fin de semaine pour une conciliation travail-vie personnelle idéale. Vous aurez la chance de planifier votre horaire selon vos disponibilités et de développer la pratique que vous souhaitez. Venez pratiquer dans une clinique bien équipée (OCT, cv, laboratoire sur place) qui vous permettra de vous épanouir sur le plan professionnel ! Vous pouvez me rejoindre en toute confidentialité.
GATINEAU • TROIS-RIVIÈRES SHERBROOKE ET QUÉBEC
Temps plein / partiel / permanent
Opti-Club
Docteure Andréanne Cormier, optométriste
450 433-8008 poste 259
c_vanessa.fredj@costco.com
Travailler chez OPTI-CLUB c’est avoir la chance d’impacter son quotidien au travers de rencontres stimulantes, de côtoyer des passionnés et de continuer à se développer professionnellement tout en ayant du plaisir. Nos installations vous permettront une pratique libre, indépendante et les salles sont entièrement équipées d’instruments à la fine pointe de la technologie avec OCT.
OPTOMÉTRISTE MOBILE MONTRÉAL MÉTROPOLITAIN
Temps partiel / remplacements ponctuels
Raymond et Côté, opticiens et optométristes mobilesvisionrc.ca
Docteure Isabelle Sirois, optométriste 514 946-1010 poste 3 cv@visionrc.ca
L’équipe de Raymond et Côté est à la recherche d’optométristes désireux de varier leur pratique à travers nos cliniques visuelles mobiles au service des aînés et ce, à travers le réseau de Montréal-Métropolitain. Nous offrons un environnement de travail atypique et très enrichissant auprès d’une clientèle ayant de grands besoins. Que ce soit pour des besoins ponctuels ou de façon plus régulière à temps partiel, nous serons enchantés de vous accueillir dans notre belle équipe déjà composée de 8 opticiens d’ordonnances et 6 optométristes. Au plaisir de vous rencontrer !
LÉVIS (St-Romuald)
Temps plein
Lunët Espace Vision
lunet.ca
Docteur Yannick Jarjour, optométriste
418 929-7549
yannickopto@gmail.com
Lunët Espace Vision est à la recherche d’un ou d’une optométriste pour notre succursale de St-Romuald ! Vous travaillerez en collaboration avec plusieurs opticien(ne)s d’ordonnances compétent(e)s dans un environnement propre, vaste et épuré. Notre modèle d’affaires est axé sur la vente de mode, de marques réputées, et ce, en très grand choix. La clientèle y est active et sympathique. Le taux d’occupation élevé permet de gagner des revenus très avantageux.



62 OPTOMÉTRISTE | MAI | JUIN 2023
Les petites annonces emplois de l’AOQ
OPTOMÉTRISTES RECHERCHÉ(E)S
MONTRÉAL
Temps plein / partiel / permanent
Georges Laoun Opticien georgeslaoun.com
Docteure Nathalie Ouellet, optométriste
Madame Anne-Marie Laoun
514 844-1919
info@georgeslaoun.com
L’équipe rayonnante de Georges Laoun Opticien est à la recherche d’un(e) optométriste à temps partiel ou à temps plein. Bureau familial indépendant à Montréal avec clientèle fidèle établie depuis plus de 35 ans. Équipements à jour, prétests effectués par des assistant(e)s. Au plaisir de vous rencontrer !
RAWDON
Temps partiel / plein
Centre Visuel Rawdon centrevisuel.ca
Docteure Émilie Coutu, optométriste
450 750-6844
emilie.coutu@centrevisuel.ca
Établie dans la région depuis plus de 30 ans, notre équipe a su développer un lien particulier avec sa précieuse clientèle, qui comble nos journées. Au Centre Visuel Rawdon, vous aurez la chance de travailler de concert avec une équipe dévouée et qualifiée qui se compose de 3 optométristes, de 6 opticiennes d’ordonnances, d’une assistante certifiée, de 3 secrétaires et d’une technicienne de laboratoire. Notre clinique est équipée à la fine pointe de la technologie : CV FDT, CV Octopus, OCT, autoréfractomètre/jet d’air automatisé, dossiers électroniques. Venez profiter de notre ambiance chaleureuse et familiale. Que ce soit à temps partiel ou à temps plein, il nous fera plaisir de vous rencontrer.
ROBERVAL
Temps plein / partiel / permanent / temporaire
Opto-Réseau Roberval opto-reseau.com
Docteure Morggan Debaets, optométriste 418 719-8548
mdebaets@opto-reseau.com
ON VOIT VOTRE TALENT | La clinique Opto-Réseau
Roberval est présentement à la recherche d’un(e) optométriste à temps plein ou temps partiel pour rejoindre son équipe. Une opportunité de pratique unique, dans l’une des plus belles régions du Québec. Joignez-vous à nous !
TERREBONNE
Temps plein / partiel
Opto-Réseau La Plaine opto-reseau.com/cliniques/centre-visuel-la-plaine Docteure Marie-Eve Hérard, optométriste
Clinique : 450 477-3536
Cellulaire : 514 462-5945 marie_eveherard@yahoo.ca
Opto-Réseau La Plaine est actuellement à la recherche d’un(e) optométriste pour compléter son équipe. La clinique, récemment rénovée (2022), est bien établie depuis plus de 30 ans et possède une clientèle familiale et un haut taux de nouveaux patients. Poste à temps plein ou à temps partiel disponible. Les horaires sont flexibles et la clinique est fermée la fin de semaine et le vendredi soir. Bureau très bien équipé (Optomap, topographe, cv automatisé, OCT). Possibilité d’association à moyen terme. Au plaisir de vous rencontrer.
CAP-DE-LA-MADELEINE
Temps plein / permanent / temporaire / partiel Greiche & Scaff greiche-scaff.com
Docteur André Aoun, optométriste 514 207-9211 andre.aoun@greiche-scaff.com
Nous vous offrons des conditions exceptionnelles, une très grande flexibilité de pratique et un encadrement dynamique. Nos priorités sont vos besoins pour œuvrer à la santé de vos patients. Parce qu’avant d’être nos clients, ils sont avant tout vos patients. Saisissez dès maintenant l’opportunité de faire partie de notre grande famille Greiche & Scaff. Notre promesse ? Votre tranquillité d’esprit. Discrétion assurée.
63 OPTOMÉTRISTE | MAI | JUIN 2023
• VICTORIAVILLE
•
• ROUYN • ST-JÉRÔME JOLIETTE • BELOEIL • ST-JEAN GRANBY • ST-BRUNO ET DANS LA RÉGION
SHERBROOKE
QUÉBEC
TROIS-RIVIÈRES RIMOUSKI
DU GRAND MONTRÉAL
OPTOMÉTRISTES RECHERCHÉ(E)S
QUÉBEC
Temps plein / partiel / permanent / temporaire
Centre visuel Marthe Verret (Opto-Réseau)
opto-reseau.com/cliniques/centre-visuel-marthe-verretquebec/
Docteure Marthe Verret, optométriste
418 529-4191
optoreseau3400@gmail.com
Optométriste recherché(e) dans un bureau dynamique opérant depuis plus de cinquante ans dans Limoilou, un quartier en pleine effervescence. Vous côtoierez des personnes chaleureuses et agréables dans un bureau où il fait bon travailler. La clinique favorise la collaboration entre ses professionnels, vise à offrir des services personnalisés et priorise les technologies de pointe. Possibilité de s'associer avec la relève et magnifique opportunité de faire croître l'entreprise. Notre message vous interpelle ? Venez nous rencontrer, il nous fera plaisir de vous accueillir et vous serez conquis(e) !
COATICOOK
Temps plein / permanent
Opto-Réseau Coaticook opto-reseau.com
Docteure Sanya Lavoie, optométriste
819 849-4131
sanyalavoie@hotmail.com
Notre équipe d’expérience et dynamique souhaite trouver un(e) optométriste à la recherche d’une clinique achalandée et bien équipée (OCT, Optomap, Octopus, autoréfractomètre, NCT…). Nous avons une clientèle familiale, diversifiée et fidèle. Nous offrons un horaire flexible de 3 à 5 jours par semaine avec 1 ou 2 soirs selon vos disponibilités. Nous sommes fermés la fin de semaine.
MONTRÉAL
Temps partiel (2 jours par semaine)
Opto-Réseau Vision Line Barnabé opto-reseau.com/cliniques/vision-line-barnabe- rosemont/
Docteure Anabelle Leclerc, optométriste 438 274-4969
anabelle.leclerc@hotmail.fr
Tu as le goût d’intégrer une super équipe de travail et de participer à la vie de groupe ? Tu es quelqu’un qui aime s’impliquer auprès de sa clientèle ? Et si on jasait ensemble ? Poste pour 2 jours (mercredi pm/soir et vendredi am/pm), clinique bien équipée avec clientèle variée et fidèle.
PROVINCE DE QUÉBEC
Temps plein / partiel / volant / permanent / temporaire IRIS, Le Groupe Visuel Visitez iris.ca/fr/carrieres pour plus de détails !
Docteure Jahel St-Jacques, optométriste 418 234-4510 jahel.st-jacques@iris.ca
La qualité des services aux patients vous tient à cœur ? Vous recherchez un environnement de pratique favorisant la collaboration interprofessionnelle, une clientèle familiale et fidèle ainsi que de l’équipement de pointe ? IRIS a des opportunités partout au Québec : Rive-Sud de Montréal, Outaouais, Lanaudière, Trois-Rivières, Sherbrooke, Québec/Lévis, Bas-St-Laurent, Charlevoix, Sept-Îles, Saguenay-Lac-St-Jean, Abitibi-Témiscamingue ! Plusieurs postes d’optométristes volants et opportunités de partenariat sont disponibles ! En plus de profiter d’une qualité de pratique, plusieurs secteurs vous offriront une qualité de vie avantageuse et de nombreux attraits touristiques et activités de plein air.
AMOS
Temps plein
Centre Visuel des Eskers
819 732-6831
Docteure Andrée-Anne Roy, optométriste andree-anne.roy@hotmail.com
819 354-6078
Docteure Caroline Coulombe, optométriste caroline.coulombe@lino.com
819 856-3630
Le Centre Visuel des Eskers d’Amos recherche un optométriste à temps plein avec possibilité de travailler 4 ou 5 jours par semaine. Notre clinique établie depuis plus de 75 ans, permet aux optométristes d’avoir une pratique de l’optométrie très variée, valorisante et enrichissante. Patients fidèles à leur optométriste, clientèle variée de tous âges, pathologies, lentilles cornéennes, lunetterie, équipements de pointe, collaboration avec les ophtalmologistes, assistantes certifiées et opticienne d’ordonnances. Nous avons des horaires flexibles et très remplis. Fermé les samedis et ouvert un seul soir par semaine. C’est l’opportunité de démarrer une merveilleuse carrière en région, loin des embouteillages, de profiter des grands espaces et de travailler près de la maison. De plus, notre clinique est entièrement rénovée ! Nous vous attendons !
64 OPTOMÉTRISTE | MAI | JUIN 2023
OPTICIEN(NE) D’ORDONNANCES RECHERCHÉ(E)






























COATICOOK
Temps plein / permanent
Opto-Réseau Coaticook opto-reseau.com
Docteure Sanya Lavoie, optométriste 819 849-4131
sanyalavoie@hotmail.com

Nous sommes à la recherche d’un(e) opticien(ne) d’ordonnances prêt(e) à se joindre à se joindre à notre équipe expérimentée. Nous avons une clientèle familiale, très diversifiée et fidèle. Nous avons également un laboratoire sur place. Nous offrons un horaire sur 4 jours incluant 1 soir et le bureau est fermé la fin de semaine. Nous avons un programme d’assurance collective.
CLINIQUE À VENDRE
OUTAOUAIS (Wakefield)
Lance Edwards ROI roicorp.com/listings/4778
Docteure Barbara Kurtz, optométriste drbkurtzoptometrist@gmail.com

Pratique à vendre dans la région de l’Outaouais. Le propriétaire prend sa retraite et demande votre confidentialité. Une clinique bien établie dans une communauté en pleine croissance. Récemment déménagé dans un nouveau bâtiment professionnel. Une salle d’examen disponible et une salle d’examen prête à équiper.
SHAWINIGAN
Jean-Victor Bergeron, optométriste jeanvictorbergeron.ca
Docteur Jean-Victor Bergeron, optométriste 819 536-7893 jeanv.bergeron@jv-bergeron.ca
Clinique à vendre : retraite imminente. Pratique établie depuis 43 ans, pignon sur rue. Environnement vaste : 3500 pi.ca, 2 grandes salles d’examen fonctionnelles. Bien équipée, OCT RS330, Optomap Daytona, acquis en août 2021, réfractomètre Nidek, périmètre Octopus 900, etc. Clinique indépendante avec clientèle nombreuse, régulière, fidèle et agréable.

65 OPTOMÉTRISTE | MAI | JUIN 2023
VENDREDI, 17 NOVEMBRE 10 H À 18 H Centre Mont-Royal 2200, rue Mansfield, Montréal

IMPRESSION B.I.G. NORMMC
VERRES PROGRESSIFS DÉVELOPPÉS AVEC INTELLIGENCE ARTIFICIELLE
La nouvelle technologie d’IA de Rodenstock et les données de plus de 500 000 scans oculaires biométriques offrent une vision plus nette aux utilisateurs de verres progressifs.
Pour plus de renseignements, veuillez communiquer avec votre représentant en lentilles de l’Optique Centennial. www.centennialoptical.com
Parce que chaque œil est unique

PROPOSEZ À VOS PATIENTS DE NOUVELLES SOLUTIONS OCULAIRES
Notre programme de cogestion comporte de nombreux avantages :
Plus de 30 cliniques au Canada
Une équipe toujours prête à vous soutenir
Des chirurgiens ayant réalisé plus d’un million d’interventions*
Des interventions pour corriger la presbytie, dont la PresbyVisionMC
Pour réserver la consultation gratuite d’un patient, communiquez avec nous à cogestion@lasikmd.com.

* Dont 500 000 au Québec seulement









 Docteur Guillaume Fortin, optométriste Président
Docteur Guillaume Fortin, optométriste Président





















































 Dr Vincent Moore, OD, FAAO
Dr Vincent Moore, OD, FAAO

















 6 Article 59 de la Loi sur la protection du consommateur
6 Article 59 de la Loi sur la protection du consommateur